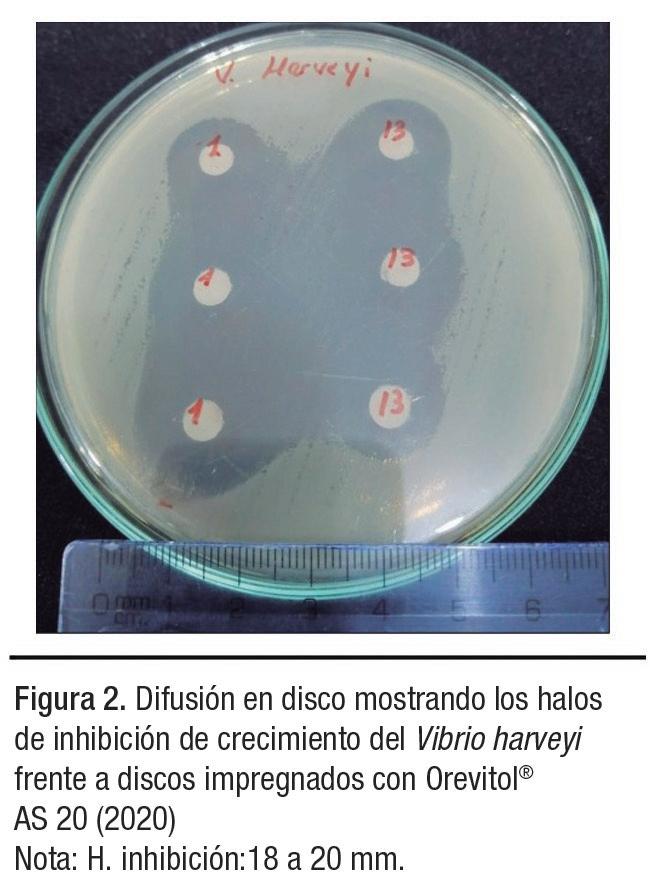

Evaluación de la variabilidad y poder discriminatorio de los patrones distintivos únicos en camarones patiblancos Litopenaeusvannamei de los principales países productores de camarones




Evaluación de la variabilidad y poder discriminatorio de los patrones distintivos únicos en camarones patiblancos Litopenaeusvannamei de los principales países productores de camarones
Editorial
Noticias de la industria
Investigación y desarrollo Evaluación de un centro de investigación del sistema de acuicultura de recirculación diseñado para abordar las necesidades actuales de conocimiento en la producción de salmón del Atlántico



Desarrollo de la acuicultura de agua dulce en la Unión Europea y América Latina: tendencias de producción y dotación de recursos
Directorio
Análisis
DIRECTOR Salvador Meza info@dpinternationalinc.com
EDITOR ASOCIADO Marco Linné Unzueta
COORDINADORA EDITORIAL Karelys Osta edicion@dpinternationalinc.com
DIRECCIÓN ADMINISTRATIVA
Adriana Zayas Amezcua administracion@dpinternationalinc.com

COORDINACIÓN DE OPERACIONES Johana Freire opm@dpinternationalinc.com
COLABORADORES EDITORIALES
Carlos Rangel Dávalos
DISEÑO EDITORIAL / PUBLICITARIO Perla Neri design@dpinternationalinc.com
COLABORADORES EN DISEÑO Rozana Bentos Pereira
COORDINADOR DE VENTAS Y MARKETING Juan Carlos Elizalde crm@dpinternationalinc.com
CIRCULACIÓN Y SUSCRIPCIONES Renée Meza suscripciones@panoramaacuicola.com
OFICINA EN LATINOAMÉRICA
Empresarios No. #135 No. Int. Piso 7 Oficina 723, Col. Puerta de Hierro, C.P. 45116 Zapopan, Jal., México. Cruza con las calles Av. Paseo Royal Country y Blvrd. Puerta de Hierro Tels: +(33) 8000 0578
OFICINA EN ESTADOS UNIDOS DP INTERNATIONAL INC. 401 E Sonterra Blvd. Sté. 375 San Antonio, TX. 78258 info@dpintertnatinonalinc.com
COSTO DE SUSCRIPCIÓN ANUAL $750.00 M.N. DENTRO DE MÉXICO USD $100.00 EE.UU., CENTRO Y SUDAMÉRICA €80 EUROPA Y RESTO DEL MUNDO (SEIS NÚMEROS POR UN AÑO)
PANORAMA ACUÍCOLA MAGAZINE, Año 27, No. 6, septiembre - octubre 2022, es una publicación bimestral editada y distribuída por Design Publications, S.A. de C.V. Av. Empresarios #135 Piso 07 Oficina 723 Col. Puerta de Hierro CP. 45116. Zapopan, Jalisco, México. Tel: +52 (33) 80 00 05 78, www.panoramaacuicola.com, info@dpinternationalinc.com. Editor Responsable: Salvador Antonio Meza García. Número de Reserva de Derechos de Uso Exclusivo 04-2019-071712292400-01, licitud de Título No. 12732, Licitud de Contenido No. 10304, ambos otorgados por la Comisión Calificadora de Publicaciones y Revistas Ilustradas de la Secretaría de Gobernación. Permiso SEPOMEX No. PP-140033. Impresa por Negocios Gráficos Grafinpren S.A. Telefono: 04-2221362 ext 28 / 0959537917. Av. C.J. Arosemena Km 2.5 Antiguo Coliseo Granasa, Guayaquil, Ecuador. Este número se terminó de imprimir el 30 de septiembre de 2022 con un tiraje de 3,000 ejemplares.
La información, opinión y análisis contenidos en esta publicación son responsabilidad de los autores y no reflejan necesariamente el criterio de esta editorial.
Queda estrictamente prohibida la reproducción total o parcial de los contenidos e imágenes de la publicación sin previa autorización de Design Publications, S.A. de C.V. Tiraje y distribución certificados por Lloyd International
Visite nuestra pagina web: www.panoramaacuicola.com
También síganos en:
Artículo
LiquaLife®: dietas líquidas que mejoran el crecimiento de las larvas de camarón
Artículo Nuevos mecanismos para controlar los patógenos de Vibrio

Artículo Doble estrategia en alimentación para camarones: ingrediente funcional + dieta con alta inclusión de fuentes de proteínas vegetales
Artículo de fondo Percepción de cultivadores de bivalvos y moluscos de California acerca del cambio en las condiciones oceánicas y estrategias para la capacidad de adaptación

Artículo
Perspectivas de la industria acuícola: Patrick Waty, CEO de INVE Aquaculture. Una entrevista exclusiva para Panorama Acuícola Magazine
Artículo
Z Pro Dieta Seca Superior para Larvas. Una dieta larval optimizada en nutrientes para un desempeño superior

Artículo
ActiTuna: ingrediente funcional sostenible para apoyar la mejora del rendimiento del camarón
Artículo Harina de subproductos avícolas como alternativa a la harina de pescado en la dieta de juveniles de dorada (Sparus aurata)












Artículo Olpheel Anti-Ox: alternativa natural a los antioxidantes sintéticos para la conservación de los alimentos acuícolas
Artículo 3er. Summit Latinoamericano por la Sustentabilidad Pesquera y Acuícola: “Latinoamérica una sola región, una sola misión: pesca con futuro”

Artículo Productos innovadores del Programa Aqua-CKM que mejoran la productividad del camarón Litopenaeus vannamei
Artículo Relación longitud-peso y factor de condición del camarón Litopenaeus vannamei cultivado en estanque revestido con polietileno
Artículo Postbióticos: estrategia para soportar la inmunidad del camarón
Reseña
Conferencia de Cooperadores Agrícolas de las Américas 2022 - USSEC

Nicovita anuncia que implementará en Ecuador el primer Centro Experimental para el desarrollo de tecnología acuícola

Los probióticos Vibrio diabolicus (Ili), Vibrio hepatarius (P62) y Bacillus cereus sensu stricto (P64) colonizan las superficies internas y externas de las larvas de camarón Penaeus vannamei y las protegen contra Vibrio parahaemolyticus
Topografía moderna y de precisión
NeoShrimp®: único alimento con 100% de sus proteínas de origen marino para larvicultura

Evaluación de la variabilidad y poder discriminatorio de los patrones distintivos únicos en camarones patiblancos Litopenaeus vannamei de los principales países productores de camarones

Impacto del internet de las cosas, en el control y monitoreo de los parámetros del agua, para la producción del camarón en Ecuador

Técnica de minería de datos: nuevo método para identificar los efectos del aglutinante de acuicultura con sardina en las dietas de juveniles de Litopenaeusvannamei



Efecto de la fotolisis y pH en la degradación de la oxitetraciclina en sedimento y agua marina


Cómo reducir las concentraciones de dinoflagelados de una manera sostenible La agavina induce microbios beneficiosos en la microbiota del camarón en condiciones de cultivo

Según la FAO (2016), el crecimiento de la población alcanzará 9.5 mil millones de personas en 2050, estimándose que se requerirán 40 millones de toneladas adicionales de mariscos para 2030, lo cual significa que es casi el doble de nuestra producción actual para el consumo humano. Ante esto, la FAO se cuestiona: “¿Cómo superar este déficit de manera sostenible?”.
Para responder lo anterior, se puede asumir que los alimentos obtenidos vía acuicultura tendrán una tendencia tal de que “... en el próximo decenio, la producción total de la pesca de captura y la acuicultura superará a la de carne de vacuno, porcino y aves de corral” (FAO, 2016); producción que ostenta una gran calidad desde el punto de vista nutricional y, a su vez, se reflejará en dietas más saludables, y bajo la premisa de actividades bajo estándares de Buenas Prácticas de Producción (BPP) y de Buenas Prácticas de Manufactura (BPM) permitirá la reducción de la huella de carbono bajo acciones de sustentabilidad.
Ante lo expuesto anteriormente, uno de los puntos críticos de atención es incentivar el reconocimiento y aprovechamiento nutricional de los productos acuáticos, ya que, a pesar los cambios continuos en el mercado y la volatilidad en los precios provocados por procesos de inflación, COVID, guerra, etc., se puede contar con productos de la acuicultura accesibles al consumidor promedio. Sin embargo, reitero, deberá promocionarse de manera agresiva los beneficios de consumo de estas proteínas con la finalidad de incrementar el consumo per cápita, dado que la FAO reportó para 2016, el consumo per cápita mundial de productos pesqueros y acuícolas alcanzó un record máximo de 21 kg, esto se debe en parte al
crecimiento vigoroso de la acuicultura la cual provee en la actualidad el 44% de los productos que consume la población.
Recordemos que parte de esa “bondad” nutricional se encuentra en que los productos de la acuicultura proveen proteínas, ácidos grasos, vitaminas y minerales; elementos para una dieta saludable, coadyuvando a proteger de la malnutrición en todas sus formas, así como de las enfermedades no transmisibles como diabetes, cardiopatías, accidentes cerebrovasculares y cáncer.
Por último, y en la tesitura de trabajar con las estrategias para reducir las emisiones de gases de efecto invernadero, en las dietas futuras se promueven, en la mayoría de los casos, dietas “verdes” basadas en fuentes de origen vegetal y pasan por alto el potencial de las dietas “azules” sustentadas en los productos acuáticos; para que permita el crecimiento adecuado y consolidar las unidades productivas acuícolas, haciéndolas más competitivas y articuladas en redes de valor, que generen productos con valor agregado para los mercados nacional e internacional, se deberá establecer estrategias que promuevan el crecimiento, programación y estandarización de la producción, sin dejar de lado el incremento en la rentabilidad y favorecer el aprovechamiento sustentable de los recursos; reflejándose en acciones destinadas a la reducción de las emisiones, adoptando tecnologías eficientes en combustible y trabajar en la producción de más peces y mariscos que no requieran de una alimentación a base de alimentos y encontrar fuentes para la fabricación de alimento para peces más respetuosos con el medio ambiente.


Probotic, la empresa de tecnología acuícola con sede en Noruega, ha dado a conocer los primeros hallazgos obtenidos en una prueba piloto con su innovador dron submarino Probot. Los logros del equipo ya revolucionan el sector de la acuicultura, al conseguir automatizar la inspección y la limpieza de las redes de peces, uno de los puntos menos fuertes de la industria. La automatización, informaron desde la empresa, resulta en una producción de alimentos más limpia, un mayor bienestar animal, menores costos operativos y menores emisiones climáticas.

“La idea de esta tecnología se me ocurrió después de pasar años inspeccionando y limpiando redes de peces de la forma tradicional”, explicó Mikkel Pedersen, CEO y fundador de Probotic. “Sabía que podía haber una manera más eficiente de hacer el trabajo, así que me puse a trabajar en mi visión de construir un robot que automatizara estos procesos, ahorrando a las empresas acuícolas horas de trabajo y costos operativos”, añadió.
La prueba piloto del dron comenzó este mismo verano en las instalaciones que la compañía tiene en Ballangen Sjofarm y, después de un mes, los aspectos mecánicos están verificados. Así, la siguiente prueba está dirigida a optimizar los algoritmos de navegación y detección del dron. El prototipo de Probotic es de
la séptima serie de prototipos de la empresa y corresponde al último prototipo de esta serie antes del lanzamiento del modelo de producción.
Uno de los hallazgos más significativos reportados por Probotic después del primer mes de prueba del prototipo Probot P.7 es que su sistema de propulsión a chorro funciona en condiciones reales y permite que las algas fluyan a través del chorro de agua. Por supuesto, este es el estado actual y se espera que los hallazgos reportados mejoren con un mayor desarrollo.
Además, el dron puede operar a 90 cm/s de corriente de agua cuando está en el modo de limpieza, y a 180 cm/s cuando está en modo inspección. Por otra parte, se ha tomado nota de que, la estación de acoplamiento sumergible, mantiene el dron asegurado en su lugar cuando pasa por una tormenta con una corriente de agua de 1 m/s. A su vez, la hidrodinámica del dron permite un movimiento suave en el agua.

Según informó la compañía noruega, después de un mes de prueba no hay condiciones de ruptura. Los videos en vivo y los datos de sensores del dron están disponibles para los interesados. Probotic dio a conocer que la versión beta del algoritmo de detección también encuentra agujeros.
El sistema
De acuerdo con la visión de la compañía, el método actual en la piscicultura para limpiar las redes de jaulas de peces es reactivo, lo que significa que son limpiadas cuando la acumulación de algas y desechos es tan grave que es necesario hacerlo. Según la visión de Probotic, este enfoque reactivo afecta negativamente el medio ambiente, la salud de los peces y de los operadores, y además demanda costos y recursos.
El sistema tradicional es operado de forma manual y utiliza agua a alta presión para bombear y eliminar las algas y los desechos. Uno de los problemas es que la biopelícula se descarga directamente en la red y provoca un entorno poco satisfactorio para los peces.
La importancia de contar con un método preventivo Pero el dron submarino Probot utiliza un método preventivo, una forma más natural y gentil de limpiar las redes y dificulta por completo la creación de biopelículas. Esto es posible mediante la limpieza constante durante todo el día, ya que los drones solo se pausan durante la carga de la batería, o durante una inspección adicional por parte del operador.
En ese sentido, Pedersen explicó que “el sistema Probot se rentará para el servicio, lo que garantiza nuestras metas de sustentabilidad y nos brinda control sobre el ciclo de vida del producto. También significa que somos responsables de garantizar que el producto funcione como se espera durante su vida útil, permitiendo a los clientes enfocarse en sus otras operaciones de alto valor”.
La empresa noruega Probotic comprueba la efectividad de sus drones submarinos en la inspección y limpieza de redes de peces
La compañía internacional Garware Technical Fibres informó de que ha registrado un “favorable desempeño comercial con crecimiento en proyectos en América Latina”, lo cual ha alentado a sus directivos a planificar su ingreso al mercado brasileño. En pro de ese objetivo, la empresa proveedora de redes y cabos ha dado un primer paso y ha llevado su participación al International Fish Congress (IFC) & Fish Expo Brasil 2022.
“Estamos seguros de que nuestros productos innovadores resolverán los desafíos operacionales, agregarán valor y aumentarán la rentabilidad de la acuicultura en Brasil, como lo hemos venido haciendo con nuestros clientes del sector en Canadá, Escocia, Faroe, Noruega, Australia, Nueva Zelanda y Chile”, comentó Gopakumar Menon, vicepresidente para las Américas de Garware.
Junto a Menon, estuvo presente en el evento brasileño Francisco
Serra, gerente comercial de Garware Chile. Ambos tuvieron oportunidad de conversar y hacer la fotografía de rigor junto a Altemir Gregolin, exministro de Pesca y presidente de IFC Brasil, y a Eliana Panty, Directora Ejecutiva del evento.
Soluciones innovadoras a escala mundial
Garware Technical Fibres brinda soluciones innovadoras en el ámbito mundial, no commodities, y es conocida en el sector por desarrollar productos enfocados en aplicaciones para una industria acuícola global. De hecho, para los centros de cultivos en Brasil, la compañía internacional india, líder global en soluciones textiles, desarrolla redes especializadas.

Entre los desarrollos de Garware destaca la tecnología V2, redes de HDPE con tecnología antifouling que incluyen incrustaciones de micropartículas de cobre que distancian los periodos de limpieza in
situ hasta en un 50%, con un impacto positivo en el medio ambiente. En tanto, las redes Star V4 de la compañía se puede impregnar con polietileno al 100% con pinturas tradicionales a base de agua, siendo las únicas capaces en el mercado global.
A su vez, Garware Technical Fibres confecciona las llamadas Sapphire, redes antipredadores con una alta resistencia al corte, mayor rigidez y resistencia a la tracción y a la abrasión. Entre ellas que se encuentra la Ultra Core MBX, hecha de HDPE compacto, la cual contiene en su centro hebras de acero inoxidable que aumentan su resistencia ante los ataques de los lobos y es de cinco a seis veces más fuerte comparada con el nylon. Otro de sus grandes beneficios es que su huella ambiental es más baja que la del nylon, generando de tres a cuatro veces menos emisiones de CO²
En tanto, la Sapphire Ultra Guard, otra de sus redes, posee en su centro polímeros especializados que reemplazan las hebras de acero, manteniendo las características de protección hacia el ataque de los lobos y haciendo más fácil su reciclaje, que alcanza el 100%.
Garware también cuenta con la red Sapphire X18, la de mayor rigidez que, si bien puede ser manipulable como una red normal en operaciones, es ideal para los cercos loberos de caída recta o vertical. Esta red permite la llegada segura y frecuente de embarcaciones mayores.
La compañía Garware, presente en los principales países acuícolas de Europa, Asia, Norteamérica y América Latina, está listada en la Bolsa de Valores de Mumbai y estuvo entre los expositores de alrededor de 15 países que presentaron productos relacionados con los mercados acuícolas entre los pasados 31 de agosto y 2 de septiembre en el gran evento de Foz do Iguaçu.
Garware
en el mercado brasileño con la presentación de su avanzada tecnología en redes acuícolas en el IFC 2022
La Universidad de Cádiz acoge la conferencia internacional de cuatro días “Ulva, de la biología fundamental a la acuicultura”.
Expertos del Instituto Español de Oceanografía, la Universidad de Almería y de la Universidad de Cádiz (UC) trabajan en el desarrollo, optimización y estudio multidisciplinario de nuevos alimentos funcionales, en los que se ha sustituido parte de la harina y aceite de pescado por harina de algas y se han añadido probióticos, los cuales se han probados en España en la engorda de alevines de rodaballo (Scophthalmus maximus) hasta tamaño comercial, estudiándose también el desempeño del producto final para el consumo humano.

Este trabajo se ha desarrollado en el marco del proyecto Algadiet II, “Desarrollo y optimización de nuevos piensos funcionales, basados en el uso de harinas de algas y probióticos, para el engorde de rodaballo”, financiado por Fundación Biodiversidad, en el marco del Programa Pleamar, cofinanciado por el Fondo Europeo Marítimo y de Pesca de la convocatoria 2019.
Los creadores de los nuevos alimentos resaltaron que estos fueron formulados con base en los principios de la sostenibilidad y la protección del medioambiente.
Los responsables y colaboradores de Algadiet II organizan una jornada en la Universidad de Cádiz para ofrecer detalles y resultados del proyecto. Durante el evento, se ofrecerá una serie de ponencias, entre ellas: “Papel de las biomasas de macroalgas en la formulación de piensos para acuicultura: Estado del arte”, de Erik-Jan Malta, del Centro Tecnológico de la Acuicultura de Andalucía (Ctaqua) de Cádiz; “Nuevas perspectivas en la aplicación de probióticos”, ofrecida por Miguel Moriñigo Gutiérrez de la Universidad de Málaga, y “Crecimiento de rodaballo cultivado con piensos funcionales: algas y probióticos”, de Cristina Rodríguez, IEO-CSIC Santander.
Algunas de las restantes conferencias serán “Utilización de algas en la alimentación del rodaballo: Efectos sobre la composición quími-
ca, funcionalidad intestinal y parámetros de calidad de pescado”, de Francisco Alarcón López de la UA; “Evaluación metabólica y del bienestar animal en ejemplares de rodaballo alimentados con inclusión de microalgas, macroalgas y probióticos”, de Juan Martos Sitcha de la UC; “Expresión génica del metabolismo lipídico e inmunidad de rodaballos cultivados con piensos suplementados con algas y probióticos”, de María Castro Pérez y, finalmente, “Perfil sensorial de filetes de rodaballo alimentados con dietas suplementadas con algas”, de Alma Hernández de Rojas, ambos del IEO-CSIC Guijón.
Ulva, presente a escala mundial La noticia de la presentación de los nuevos alimentos a base de algas llegó cuando la propia Universidad de Cádiz y el Centro Tecnológico de la Acuicultura (Ctaqua) se encontraban organizando la conferencia internacional “Ulva, de la biología fundamental a la acuicultura”, que tuvo entre los pasados 12 y 15 de septiembre, cuyo objetivo fue “conocer el estado del arte, las lagunas de conocimiento y los ‘cuellos de botella’ de esta macroalga”.

Nueva
Este encuentro internacional está enmarcado en la acción “Cost Seawheat”, que tiene como objetivo el aprovechamiento de la Ulva y la exploración de sus aplicaciones comerciales en alimentación humana, alimentación animal e industria farmacéutica, entre otras.
Expertos españoles desarrollan nuevos alimentos funcionales con harina de algas y probióticos para alimentación del rodaballo
de peces tropicales. Ricardo supervisó el desarrollo de la Estación Experimental de Acuicultura en la Universidad Central del Este, República Dominicana.
Aquatic Equipment & Design se orgullece en anunciar que Ricardo Arias se ha unido a nuestro equipo como nuestro Gerente General. Ricardo se graduó en la Universidad de Tampa como Licenciado en Ciencias en Biología. Completó una formación en acuicultura en Pusan, Corea del Sur, y luego trabajó en cultivo de camarones, cultivo de tilapia y cría
Con más de 30 años de experiencia en la industria acuícola, Ricardo fue Gerente General de Aquatic EcoSystems, una empresa líder mundial en catálogos de acuicultura que vende y distribuye equipos relacionados con esta industria. Durante su permanencia en AES, fue clave en el desarrollo de las ventas internacionales, creando y gestionando la División Internacional. Ricardo también se desempeñó como Gerente de Ventas Globales para América Latina de Pentair Aquatic Eco-Systems, donde supervisó la estrategia de venta para la región de América Latina. Ricardo brindó soporte técnico ofreciendo soluciones en el


diseño de sistemas para criaderos de camarones y peces, sistemas de recirculación, acuicultura de engorde y sistemas de acuaponía, además tiene extenso conocimiento en todas las formas de acuicultura practicadas en el mundo.
Antes de unirse a Aquatic Equipment and Design, Ricardo pasó 3 años en Cargill Aqua Nutrition –Norteamérica, donde se desempeñó como Young Animal Nutrition Lead, especialista en camarones, responsable del desarrollo y ejecución de ventas de dietas Liqualife para criaderos de camarones en América Latina y Asia.
Estamos emocionados de sumar a Ricardo a nuestro equipo y esperamos continuar sirviendo a nuestra industria. Ricardo puede ser contactado a través de Ricardo@aquaticed. com o través de nuestro sitio web www.aquaticed.com
Una mejor comprensión de la bioseguridad de los sistemas de recirculación acuícolas es clave para una producción sostenible y ética de salmón del Atlántico en estos sistemas, por lo que este estudio evalúa el rendimiento en una nueva instalación de este tipo destinada a la investigación de infecciones de peces, tomando el salmón del Atlántico como modelo.
Por: Redacción de PAM*
El salmón del Atlántico (Salmo salar) es una de las principales especies de peces cultivadas en el mundo, con una producción anual de alrededor de 2.4 millones de toneladas (FAO, 2020). Su ciclo de producción acuícola comprende dos fases diferenciadas: una producción de smolts en tierra, seguida de una fase de engorda en jaulas marinas hasta alcanzar el tamaño de mercado. Recientemente, la producción en tierra ha pasado del uso de sistemas tradicionales de flujo continuo a sistemas acuícolas de recirculación (RAS, por sus siglas en inglés). La mayor adopción de RAS para producir smolts y postsmolts se debe, en parte, a los beneficios de un entorno
de producción controlado, incluida la reducción de los impactos ambientales negativos, una ubicación flexible y una alta bioseguridad.
En teoría, la bioseguridad es más estricta en los RAS que en otros sistemas de producción, como los sistemas de flujo continuo, aunque todavía se presentan filtraciones de patógenos que provocan eventos de mortalidad masiva y grandes pérdidas económicas. Los patógenos, que van desde bacterias y virus hasta hongos y parásitos, pueden infectar a los peces cultivados en RAS. Entre los patógenos que representan un problema grave en el cultivo basado en RAS de salmónidos, se encuentran el virus de la necrosis pancreática infecciosa
(IPNV, por sus siglas en inglés), los agentes bacterianos de la enfermedad branquial Flavobacterium spp. y Ca. Branchiomonas cysticola, o el agente de la enfermedad bucal roja entérica Yersinia ruckeri.
Es un desafío desarrollar estrategias de desinfección para controlar los brotes de patógenos, en el agua de cultivo y las unidades de tratamiento de agua en los RAS, sin afectar negativamente la salud y el bienestar de los peces o la comunidad de bacterias nitrificantes en los biofiltros. En tal sentido, este estudio tiene por objetivo describir y evaluar una nueva instalación RAS para la investigación de patógenos de peces, enfocado en el salmón del Atlántico como modelo animal.
Evaluación de un centro de investigación del sistema de acuicultura de recirculación diseñado para abordar las necesidades actuales de conocimiento


Los ensayos experimentales se llevaron a cabo en el laboratorio de salud de los peces de la estación de investigación de acuicultura de Tromsø (Havbruksstasjonen i Tromsø AS, Kårvik, Noruega). Las nueve unidades RAS individuales están ubicadas en una de las salas de infección del centro de investigación (Figura 1). En la Figura 2 se muestra el esquema del flujo de agua a través de las diferentes unidades RAS.


Se incubaron huevos oculados de salmón del Atlántico (AquaGen Atlantic QTL-innOva PRIME, AquaGen AS, Trondheim, Noruega) y los peces se criaron en un sistema de flujo continuo a ± 7.5ºC bajo un fotoperíodo de luz continua hasta alcanzar ~10–26 g de peso corporal. Los peces fueron alimentados continuamente (~23 h/día) hasta la saciedad con dietas comerciales (gránulos de 1 y 2 mm, Nutra Olympic, Skretting, Noruega) a través de un alimentador automático de correa. En el experimento 5, los peces se alimentaron con una dieta experimental formulada para salmón Atlántico parr-smolt (gránulos de 2 y 3 mm de tamaño, Nofima AS, Bergen, Noruega).
Los datos biológicos, la calidad del agua y los parámetros de gestión del sistema de cinco ensayos experimentales independientes realizados entre septiembre de 2020 y julio de 2021, se utilizaron para evaluar las unidades RAS:
Experimento 1. Modelo de desafío de patógenos: vector reposición de agua
Un total de 495 salmones del Atlántico juveniles de (± 12 g) se distribuyeron aleatoriamente entre las nueve unidades RAS. Los peces se sometieron a uno de tres tratamientos por triplicado. Los tratamientos consistieron en: a) grupo control, donde los peces no estuvieron expuestos a Y. ruckeri; b) grupo de entrada única, en el que los peces se expusieron una vez a un cultivo de 24 h de Y. ruckeri administrado a través del agua de reposición, y c) grupo de múltiples entradas, en el que los peces se expusieron a un cultivo de 24 h de Y. ruckeri administrado, a través del agua de reposición, durante 3 días consecutivos. El período experimental duró 15 días. El peso final de los peces fue de 16 g, la biomasa de 453 g y la tasa de crecimiento específica general fue de 1.92%/día.
Experimento 2. Modelo de desafío de patógenos: vector de peces infectados
Se distribuyó un total de 450 salmones del Atlántico juveniles (± 12 g), infectados previamente con Y. ruckeri o no infectados, entre las nueve unidades RAS utilizando la siguiente matriz de infección: Control = 0 peces infectados y 50

peces no infectados por unidad RAS; baja carga de patógenos = 5 peces infectados y 45 peces no infectados por unidad RAS, y alta carga de patógenos = 20 peces infectados y 30 peces no infectados por unidad RAS. Los tres tratamientos se realizaron por triplicado. El período experimental duró 14 días. El peso final de los peces fue de 16 g, la biomasa de 493 g y la tasa de crecimiento específica general de 2.05%/día.
Experimento 3. Desinfección química: concentraciones de ácido peracético
Un total de 360 de salmones del Atlántico juveniles (± 15 g) se distribuyeron aleatoriamente entre las nueve unidades RAS y se aclimataron durante una semana. Los peces se sometieron a tres diferentes tratamientos, con tres RAS replicados por tratamiento. Los tratamientos fueron un control (0.0 mg/L), una concentración baja de ácido peracético (PAA) (0.1 mg/L) y una concentración alta de PAA (1 mg/L). El ensayo experimental duró 29 días. El peso final de los peces fue de 35 g, la biomasa de 877 g y el crecimiento específico de 2.92%/día.
Experimento 4. Desinfección química: administración de PAA por pulso vs. continuo
Un total de 360 salmones del Atlántico juveniles (± 26 g) se distribuyeron aleatoriamente entre las nueve unidades RAS y se aclimataron durante 1 semana. Los peces fueron sometidos a tres tratamientos diferentes, con tres repeticiones por tratamiento. Los tratamientos fueron control (sin PAA), pulso PAA (1 mg/L cada 72 h) y PAA continuo (1 mg/L). El ensayo experimental duró 29 días. El peso final de los peces fue de 54 g, la biomasa de 1,181 g y la tasa de crecimiento específica general de 2.52%/día.
Experimento 5. Esmoltificación: efectos de los niveles de grasa en la dieta en la transformación de parr-smolt
Un total de 990 salmones juveniles del Atlántico (± 19 g) se distribuyeron aleatoriamente entre las nueve unidades RAS y se aclimataron durante 1.5 semanas. Los peces fueron sometidos a tres tratamientos dietéticos diferentes por triplicado: dieta control, dieta baja en grasa (−5% de grasa) y dieta alta en grasa
(+5% de grasa). Los parr se transformaron utilizando un régimen fotoperiódico de onda cuadrada que constaba de 6 semanas de “señal de invierno” (LD 12:12), seguidas de 9 semanas de LD 24:0. El ensayo experimental duró 57 días. El peso final de los peces fue de 94 g, la biomasa de 4,721 g y la tasa de crecimiento específica general de 2.81 %/día.
Variabilidad de parámetros de peces y calidad del agua La Tabla 1 refleja las cifras de peso corporal y longitud a la horquilla de los peces de los cinco ensayos experimentales en el muestreo final. El coeficiente de correlación entre clases (ICC) fue de 0.1 en prome-
dio, con un rango de 0.0 a 0.4. En general, la variación dentro de los tanques (CVe) fue mayor que la variación entre tanques (CVß): 36 vs. 11% para el peso y 6 vs. 2% para la longitud, respectivamente, CVe y CVß. La mayor diferencia se observó para el peso, donde los valores de CVe oscilaron entre 22 y 97%, mientras que los valores de CVß oscilaron entre 5 y 20%.
La potencia realizada se calculó utilizando la función wp.crt3arm del paquete R “WebPower” (Zhang y Mai, 2019). Se llevó a cabo un análisis de potencia para la configuración del sistema estándar de nueve tanques con tres tratamientos asignados, tres tanques replicados cada uno, para un rango de peces por tanque de 1 a 60.
La potencia media realizada de los cinco experimentos fue del 59% en peso y del 47% en longitud. La potencia por peso realizada presentó la mayor variación entre los experimentos, variando del 21 al 95%. La sensibilidad del análisis de potencia estadística se evaluó utilizando un rango de ICC para los tanques agrupados en los tratamientos a 0, 0.1 y 0.2, y los tres tamaños del efecto estandarizados (pequeño = 0.2, medio = 0.5, y grande = 0.8), tal y como lo define Cohen (1988) (Figuras 3A–C). Aquí, se puede observar que: (1) el poder estadístico disminuye con el aumento del ICC, (2) el poder estadístico aumenta con el aumento del efecto del tratamiento y (3) el poder estadístico aumenta con



el aumento del número de peces muestreados por tanque.
Los parámetros promedio de calidad del agua de los cinco ensayos experimentales se resumen en la Tabla 2. Los valores CVExp (entre los cinco ensayos experimentales) fueron en promedio un 243,7 % más altos en comparación con los valores CVTrat (dentro de los cinco tratamientos experimentales).
En el estudio, se utilizaron datos de cinco ensayos experimentales independientes para establecer una línea de base de variación para rendimiento de los peces, calidad del agua y métricas de gestión del sistema de una instalación de investigación novedosa y única para la investigación de patógenos en RAS.
La instalación RAS actual reutiliza el agua y esta característica abre una nueva área de investigación de patógenos: cómo eliminar patógenos en el agua. El estudio evaluó la eficacia de un método de desinfección química que combinó un ciclo de pH bajo-alto para eliminar patógenos, en este caso específico la bacteria Y. ruckeri.
La evaluación y descripción de nuevas instalaciones de investigación es importante para el uso eficaz de los recursos, la producción científica de alta calidad y crear conciencia sobre centros de investigación para la colaboración nacional y transnacional.
La evaluación y descripción de nuevas instalaciones de investigación son importantes para el uso eficaz de los recursos, la producción científica de alta calidad y para crear conciencia sobre centros de investigación para la colaboración nacional y transnacional.
En el estudio se describen los componentes del tratamiento del agua, el flujo del proceso del agua y los límites de calidad del agua para las especies objetivo, información que se puede emplear para otras investigaciones y usuarios de la industria con la finalidad de desarrollar y refinar sus propios sistemas de producción. En general, el CVß relativamente bajo es una buena indicación de que el orden de magnitud de la variación del tanque/RAS es bajo. En consecuencia, la instalación de investigación es muy prometedora para la replicar las condiciones experimentales, lo cual es importante para entornos tecnológicos y biológicos complejos como RAS, con el beneficio adicional de que las unidades RAS son independientes y no violan los supuestos estadísticos.
Este estudio describe y evalúa una instalación RAS diseñada específicamente para realizar investigaciones sobre la dinámica de infección por patógenos del salmón del Atlántico y las respectivas estrategias de desinfección. Se tuvieron en cuenta cuatro objetivos principales al diseñar y construir esta instalación: (1)
establecer modelos de desafío con patógenos utilizando peces in vivo, (2) ofrecer flexibilidad en las tecnologías de desinfección, incluida la ozonización, la radiación ultravioleta y los productos químicos para el agua, (3) producir un rendimiento de peces y una calidad del agua relevantes para la industria dentro de niveles óptimos para el salmón del Atlántico, y (4) tener unidades RAS replicadas idénticas e independientes para respaldar diseños experimentales sólidos y análisis de datos estadísticos. Los datos de los cinco ensayos analizados indican que la instalación ofrece con éxito los resultados esperados, con la expectativa de que será útil en el desarrollo de nuevos conocimientos para mejorar la bioseguridad de RAS en la industria acuícola del salmón del Atlántico.

Esta es una versión resumida desarrollada por el equipo editorial de Panorama Acuícola Magazine del artículo “EVALUATION OF A RECIRCULATING AQUACULTURESYSTEMRESEARCH FACILITY DESIGNED TO ADDRESS CURRENT KNOWLEDGE NEEDS IN ATLANTIC SALMON PRODUCTION” escrito por: VASCO C. MOTA - Nofima AS; ANJA STRIBERNY - Nofima AS; GERHARDUS C. VERSTEGE - Nofima AS, Havbruksstasjonen i Tromsø AS; GARETH F. DIFFORD - Nofima AS, Norwegian University of Life Sciences; CARLO C. LAZADO - Nofima AS. La versión original, incluyendo tablas y figuras, fue publicada en ABRIL de 2022, en FRONTIERS IN ANIMAL SCIENCE. Se puede acceder a la versión completa a través de: doi: 10.3389/fanim.2022.876504.


A diferencia de otras regiones del mundo, la piscicultura de agua dulce en la Unión Europea y América Latina y el Caribe es un subsegmento marginal del sector acuícola, cuyos cambios por década en la producción se compara a partir del análisis de las dotaciones de recursos de agua dulce y el uso de los recursos hídricos renovables totales como indicador de la abundancia del agua.
Por: Redacción de PAM*Desde mediados de la década de 1990, casi todo el crecimiento en el suministro de alimentos del mar se ha originado en la acuicultura. A escala global, la contribución de la producción de peces de agua dulce a la producción acuícola total aumentó desde 55.6%

hasta 61.2% entre 1995 y 2019, lo que indica que la tasa de crecimiento de la acuicultura de agua dulce supera a la de la maricultura. En la Unión Europea (UE-27) y América Latina y el Caribe (ALC), el perfil de la industria acuícola es diferente al de las otras regiones, ya que la acuicultura costera (mari-
na o de agua salobre) domina el sector en ambas regiones. En 2019, la acuicultura de agua dulce solo contribuyó con 25.0% y 27.4% de la producción pesquera total en ALC y UE-27, respectivamente, y la tasa de crecimiento fue inferior a la de la acuicultura marina en ambas regiones.
Tendencias de la producción acuícola en las dos regiones Aunque a escala mundial la acuicultura de agua dulce se está expandiendo rápidamente, existe una heterogeneidad espacial en los patrones de desarrollo, tanto entre regiones como dentro de cada región (Figura 1).



La Figura 2 presenta los cambios por década en la producción de la acuicultura de agua dulce en América Latina. Durante este período, la producción creció un 95% (de 476 a 927Kt), lo que es considerablemente mayor que la tasa de crecimiento mundial de acuicultura de agua dulce (60%). Brasil es por mucho el mayor productor de ALC; es el único país no asiático en el top 10 de la lista mundial de productores acuícolas de agua dulce y el crecimiento de 2.1 veces de la producción brasileña durante una década es considerablemente más alto que el de los otros grandes productores mundiales. Sin embargo, en los otros grandes productores de ALC (Perú, México y Colombia) el sector creció a un ritmo incluso superior al de Brasil. En conjunto, los cuatro principales productores (Brasil, Perú, México y Colombia) representan el 85% de la producción acuícola de agua dulce total de la región, y contribuyeron al 98% del incremento en el volumen de producción durante una década.
Producción en la UE Contrariamente al desarrollo significativo en la acuicultura de agua dulce en América Latina y el mundo, la producción en la UE no ha crecido durante décadas. La producción disminuyó ligeramente de 284 a 280 Kt en la última década (Figura 3). Al igual que en América Latina, en la UE existen grandes diferencias entre los patrones de desarrollo de los países individuales. Hay gradientes marcados de oeste a este y de sur a

norte en las tasas de crecimiento de la industria. La producción acuícola en la mayoría de los países del oeste y del Mediterráneo cayó; por el contrario, los estados del este y del norte aumentaron su producción de pescado (Figura 1).
La diversificación de especies aumenta la resiliencia de la industria al reducir su vulnerabilidad a
En 2019, la acuicultura de agua dulce solo contribuyó con el 25.0 % y el 27.4 % de la producción pesquera total en ALC y UE-27, respectivamente, y la tasa de crecimiento fue inferior a la de la acuicultura marina en ambas regiones.
las crisis del mercado y a los brotes de enfermedades específicas de especies. El índice de diversificación (DIV, por sus siglas en inglés) calculado para la acuicultura de agua dulce de América Latina se redujo de 0.68 a 0.59 en la última década, sugiriendo que se ha producido una concentración de la industria y el sector se volvió menos diversificado a escala regional. La reducción en el DIV se atribuye principalmente al creciente predominio de la tilapia del Nilo en la acuicultura latinoamericana. En Brasil, México y Perú, la diversificación de la producción pesquera se redujo significativamente, lo que corresponde a un patrón de desarrollo en el que una especie dominante se vuelve aún más dominante en la producción (tilapia para México y Brasil, trucha para Perú).

La diversidad de especies aumentó ligeramente en la UE-27 en los últimos años de 0.54 a 0.56, lo cual se atribuye principalmente a la disminución de la contribución de la trucha a la producción total.
Uso y recursos del agua en la acuicultura de ALC y la UE Intensidad de los recursos hídricos de la producción acuícola de ALC y la UE
La intensidad del uso de los recursos varía ampliamente entre los sistemas de cultivo. Los sistemas de estanques, que son el ambiente dominante para la producción de peces de agua dulce tanto en el mundo como en ALC, se encuentran entre RAS/jaula y sistemas de flujo continuo en términos de uso del agua, con valores de huella entre 3 y 40 m3/kg, dependiendo de los rendimientos, condiciones de evaporación y filtración en el sitio de producción y régimen de renovación de agua aplicado.
Generalmente, se considera que el uso específico del agua tiene una relación asintótica con la intensidad de la producción acuícola, encontrándose que los sistemas de producción más intensivos emplean los recursos hídricos de manera más eficiente (por kg de pescado producido) que los sistemas de producción extensiva (Tabla 1).

El crecimiento de la producción acuícola requiere entre 5 y 50 m3 de agua por kg de capacidad adicional, según la especie y el sistema de producción. La acuicultura de tilapia y carpa en la mayoría de los sistemas semintensivos típicos demandan de 10 a 30 m3/kg, mientras que la trucha producida en flujo continuo convencional requiere más de 50 m3/kg. Al examinar las dos regiones, destaca ALC por su abundancia en recursos hídricos totales renovables (TRWR, por sus siglas en inglés) con un valor de 21,476 m3/ cápita/año, mientras la UE-27 tiene un TRWR menor en un orden de magnitud (3,041 m3/cápita/año). El crecimiento de la producción acuícola de agua dulce anual durante los últimos diez años fue de -0.01 kg/cáp. (UE) y 0.70 kg/cáp. (ALC).

Los puntos en la Figura 4 representan la disponibilidad per cápita de recursos de agua dulce renovados anualmente frente al crecimiento per cápita en el sector de la acuicultura en la última década
Según los datos disponibles, se estima que el 48% de la producción en agua dulce se origina en sistemas de estanques/tanques/canalizaciones de flujo continuo, el 38% se produce en estanques de tierra con agua estática, mientras que los sistemas RAS representan el 10% y la acuicultura en jaulas/corrales el 4%. En condiciones de flujo continuo, se cultivan principalmente truchas y, en menor medida, bagres africanos. La trucha de agua fría a menudo se cría en aguas superficiales desviadas de cursos de agua más pequeños, mientras que el bagre de aguas cálidas se cría en aguas geotérmicas subterráneas. En el segmento de cultivo en estanques, por lo general se practica un policultivo semintensivo en el que predomina la carpa con rendimientos bajos (< 1 t/ha). A diferencia de América Latina, los sistemas RAS europeos se construyen sobre todo para cultivar especies de agua dulce como truchas, bagres y esturiones.

para los
Se estima que el 48% de la producción de agua dulce se origina en sistemas de estanques/ tanques/canalizaciones de flujo continuo, el 38% en estanques de tierra de agua estática, mientras que los sistemas RAS representan el 10% y la acuicultura en jaulas/corrales el 4%.
12 principales países productores de cada región. El crecimiento per cápita de la acuicultura se calcula como la diferencia entre la producción per cápita entre 2017-2019 y entre 2007-2009. Por lo tanto, en los países con incremento de la población y una producción ligeramente creciente, pueden tener valores negativos para el cambio per cápita en la producción de peces (por ejemplo, Dinámica). La correlación Pearson-r calculada entre las dos variables es de 0.53 (p = 0.08) para los países de América Latina, mientras que para los países europeos es de 0.75 (p < 0.01) si se excluyen los datos atípicos de Bulgaria. Estos valores sugieren una relación positiva entre el desarrollo de la acuicultura de agua dulce per cápita y la disponibilidad de agua dulce per cápita
Perú, Colombia y Brasil son los países con más abundancia de agua en América Latina, y estos países ocupan el segundo, primer y cuarto lugar en términos de crecimiento acuícola per cápita, respectivamente. Por otro lado, Cuba se caracteriza por tener la menor disponibilidad de recursos hídricos en América Latina y esto corresponde a una mayor reducción de la producción acuícola. Entre los mayores países productores de pescado de agua dulce en la UE, Suecia, Hungría y Rumania tienen el mayor volumen de recursos hídricos, lo que corresponde a tasas de crecimiento positivas de la acuicultura per cápita en estos países. Suecia tiene la mayor abundancia de agua entre los principales productores de la UE y esto permite una alta tasa de crecimiento en la producción de truchas en sistemas de flujo continuo, que tiene la mayor demanda de agua entre los sistemas europeos.
En las regiones con escasez de agua, una estrategia para maximizar el valor de la producción por m3 de agua utilizada es cultivar especies de alto valor en sistemas acuícolas de recirculación (RAS, por sus siglas en inglés), que minimizan la huella hídrica. La acuicultura basada en RAS (crianza de esturiones, anguilas, bagres y truchas) se ha desarrollado rápidamente, en especial en los países europeos donde los recursos hídricos renovables per cápita están por debajo de 400 m3. Dinamarca, Francia, Alemania, Polonia y España, en conjunto, representan el 75% de la producción de RAS en la UE.

La acuicultura genera emisiones tanto al aire como al espacio acuático. La mayor preocupación ambiental tiene que ver con: (i) la liberación de nitrógeno o fósforo, que puede estimular los procesos de eutrofización en el cuerpo receptor de agua y ii) la emisión de gases de efecto invernadero (GEI). A diferencia de la huella hídrica, que es principalmente generada durante las actividades de granja, la mayoría de los GEI relacionados con la acuicultura se emiten durante la producción de alimentos, de manera que la huella de carbono está determinada en gran medida por el factor de conversión de alimentos y los ingredientes usados en los alimentos acuícolas. Esto implica que los hábitos nutricionales de las especies cultivadas y la disponibilidad regional de los ingredientes que cumplan con estos requisitos nutricionales tengan una gran influencia en la mitigación del cambio climático.
Hay diversos factores que juegan un papel importante en el desarrollo de la acuicultura, incluida la demanda del mercado, los daños al ambiente, las regulaciones de licencias y la capacidad institucional. ALC, que representa un tercio de la escorrentía total del mundo, está bien dotada de recursos hídricos renovables actualmente subutilizados y todavía
tiene un gran margen de expansión. En el contexto europeo, a menudo se cita que la burocracia y las regulaciones ambientales restrictivas son barreras para el crecimiento, pero es necesario comprender mejor si las regiones pobres en recursos naturales tienden a tener reglas ambientales más estrictas para garantizar la conservación de la biodiversidad y el funcionamiento de los ecosistemas, y si las influencias socioeconómicas e institucionales son en sí mismas consecuencias de la escasez de recursos. De hecho, muchos de los productores europeos ven que el potencial futuro de la industria depende de los subsidios, en lugar de la expansión de la producción física.
Esta es una versión resumida desarrollada por el equipo editorial de Panorama Acuícola Magazine del artículo “FRESHWATER AQUACULTUREDEVELOPMENTINEUAND LATIN-AMERICA:INSIGHT ON PRODUCTION TRENDS AND RESOURCE ENDOWMENTS”escrito por:GERG˝OGYALOG;JULIETHPAOLACUBILLOS TOVAR;EMESEBÉKEFI-HungarianUniversityof AgricultureandLifeSciences.La versión original, incluyendo tablas y figuras, fue publicada en MAYO, 2022, en SUSTAINABILITY. Se puede acceder a la versión completa a través de: https://doi.org/10.3390/su14116443

mación de una comisión con expertos de diferentes áreas de las empresas del sector, para revisar temas técnicos que requieren atención, acción o pronunciamiento de la industria. La convocatoria fue liderada por la directora ejecutiva de la CNA, Yahira Piedrahita.
Hace pocos días, miembros directivos de la Cámara Nacional de Acuacultura (CNA) ecuatoriana participaron de la reunión virtual convocada por la Alianza Global para la Facilitación del Comercio, en el marco del proyecto Fortalecimiento de la Ventanilla Única Ecuatoriana (VUE) y la Modernización de Procedimientos Sanitarios. El propósito del encuentro fue conocer los formatos que se implementarán en VUE para las exportaciones a los mercados de interés, de modo que la Alianza, en conjunto con la CNA, trabajen en la elaboración de los formatos de manera participativa, de acuerdo a los requisitos del mercado.

En la reunión estuvieron presentes Laura Escalante y José A. Játiva, de la Alianza Global, y, en representación de la entidad, Yahira Piedrahita, directora ejecutiva; Luis Robles, director adjunto; y Daniel Pesantes, gerente de Comercio Exterior.

Con el proyecto de Fortalecimiento de la VUE y la Modernización de Procedimientos Sanitarios se busca reducir costos, tiempos y trámites en las operaciones comerciales, aumen-
tando la eficiencia de servicios, mediante reingeniería de procesos y avance tecnológico, fortaleciendo la VUE, para la digitalización y actualización de 17 trámites de exportación de productos acuícolas y pesqueros.
El pasado año 2021 Ecuador suscribió un memorando de entendimiento con la Alianza Global para la Facilitación del Comercio, que dará una cooperación no reembolsable de USD 2.3 millones para implementar un acuerdo con la Organización Mundial del Comercio (OMC). Los fondos se utilizarán para avanzar en el cumplimiento de la implementación del Acuerdo de Facilitación del Comercio de la OMC y la ejecución de un decreto ejecutivo interno que busca aumentar la competitividad del país.
La Alianza Global para la Facilitación del Comercio es dirigida en Ecuador por el Centro para la Empresa Privada Internacional, la Cámara de Comercio Internacional y el Foro Económico Mundial, en cooperación con la Gesellschaftfür Internationale Zusammenarbeit, y es financiada por los gobiernos de los Estados Unidos, Canadá, Alemania y Dinamarca.
Nueva comisión revisará temas técnicos
Por otra parte, en la Cámara Nacional de Acuacultura se realizó la confor-
El propósito de la comisión técnica es establecer una agenda de trabajo, además de conocer y analizar propuestas de normativa sanitaria. Participaron de esta nueva reunión Laurence Massaut, de BioMar; Diva Aldama y Marita Monserrate, de Skretting Ecuador; Xavier Romero, del Grupo Almar; Iván Cereceda, miembro de AquaGen; y Ana María Costa y José Fernando Vargas, de Songa.
First Class Shrimp, por primera vez en la Seafood Expo Asia de Singapur
En tanto, y mientras la CNA se prepara para la nueva edición de la Aqua Expo Guayaquil del próximo mes de octubre, la entidad está trabajando en lo que será su presencia en la Seafood Expo Asia, que se llevará a cabo entre el 14 y el 16 de septiembre en Singapur. Según se ha informado, el pabellón de Ecuador First Class Shrimp ocupará una superficie de 144 metros cuadrados y contará con la participación de 10 empresas ecuatorianas. Ellas son Edpacif, Excamecor, Expalsa, Expotuna, Frigolandia, Nirsa, Omarsa, Procamaronex, Songa y Total Seafood.
En tanto, la Aqua Expo Guayaquil 2022 ya tiene confirmada la presencia de más de 250 empresas, con sus stands vendidos. Además, en el congreso técnico comercial que tendrá lugar en la feria habrá 30 conferencistas nacionales y ecuatorianos, informaron desde la CNA. El encuentro tendrá lugar entre los próximos 17 y 20 de octubre en el Centro de Convenciones de Guayaquil. Los interesados en asistir pueden obtener su pase para tanto para el congreso como para la feria comercial en el website de Aqua Expo.
Aqua Expo 2022 Guayaquil, el evento técnico camaronero más importante del continente americano, tendrá lugar del 17 al 20 de octubre en el Centro de Convenciones de la ciudad ecuatoriana. La exposición comercial será la más grande de la historia del evento, ya que tendrá un área de alrededor de 7,000 metros cuadrados, y en ella se realizará el montaje de más de 200 stands de empresas que ya han confirmado su presencia. Se espera que diariamente sean alrededor de 3,000 personas las que visiten la feria comercial en esta nueva edición.
El acto inaugural se realizará el 17 de octubre a las 19:30 horas y contará con la presencia de autoridades del Gobierno ecuatoriano y seccionales, así como representantes de la industria y la academia. El evento es patrocinado por Agrantech, BiofortSP, BioMar, Cargill, Skretting, DSM, Nicovita y USSEC, informaron desde la Cámara Nacional de Acuacultura (CNA) de Ecuador, organizadora del evento.
Empresas nacionales y extranjeras mostrarán, en el recinto ferial, la innovación de la industria a través de productos y servicios para todos los eslabones de la cadena acuícola.
En lo que respecta al Congreso Aqua Expo 2022, el programa técnico se desarrollará en dos salas de forma simultánea, abordando temas de salud animal, nutrición y
manejo de la alimentación, calidad e inocuidad, procesos eficientes de producción, uso de nuevas tecnologías, sostenibilidad, certificaciones y proyecciones del mercado del camarón. Más de 60 conferencistas nacionales y extranjeros participarán en exposiciones y paneles.
Desde la CNA informaron de que se han alcanzado alianzas con medios internacionales como Panorama Acuícola, AquaFeed e Infofish para la difusión y cobertura del evento.
La Cámara, entidad organizadora del evento por más de dos décadas, invitó una vez más al sector acuícola mundial a ser parte de la innovación y el crecimiento de la industria que cada año se reúne en un solo lugar: Aqua Expo 2022. Los interesados en visitar la exposición comercial o participar en el congreso pueden ingresar a www.aquaexpo.com.ec y gestionar su pase.
La noticia del éxito en la adhesión a la exposición comercial llega muy pocos días después de la participación de un grupo de empresas camaroneras ecuatorianas en la feria de productos del mar más importante de Oriente, ‘Seafood Expo Asia’, que tuvo lugar en Suntec Singapore Convention & Exhibition Centre hace pocos días.

La presencia ecuatoriana fue organizada en su totalidad por la Cámara Nacional de Acuacultura,
que preparó un pabellón de Ecuador que ostentó el distintivo ‘First Class Shrimp’ y tuvo 144 metros cuadrados. La delegación ecuatoriana estuvo conformada por Crimasa, Edpacif, Excamecor, Expalsa, Exportquilsa, Expotuna, Frigolandia, Nirsa, Omarsa, Procamaronex, Santa Priscila, Songa y Total Seafood.
Singapur es un importante eje de negocios para el comercio mundial. Es el centro de envío más activo del mundo conectado a 600 puertos en más de 120 países. Su aeropuerto, el Aeropuerto Changi de Singapur, es un centro aéreo regional líder y reconocido como uno de los mejores a nivel internacional.
Durante la exposición de tres días de la ‘Seafood Expo Asia’, una larga lista de empresas expositoras mostró sus nuevos productos, equipos y servicios. Compradores de la industria de restaurantes, supermercados, hoteles y catering, así como importadores y distribuidores de todo el continente asiático visitaron el evento en busca de productos del mar innovadores, frescos, congelados, refrigerados, enlatados y con valor agregado para satisfacer la creciente demanda de sus clientes.
El traslado de este evento a Singapur, explicaron desde la CNA, ya permite atender diversas necesidades en la cadena de valor de productos del mar del continente asiático, brindando a la industria la oportunidad de explorar nuevas oportunidades comerciales.

Con más de 200 stands confirmados, la edición 2022 de Aqua Expo Guayaquil tendrá la exposición comercial más grande de su historia
El Ministerio de Producción, Comercio Exterior, Inversiones y Pesca (MPCEIP) de Ecuador y la Administración de Alimentos y Medicamentos (FDA, por sus siglas en inglés) de los Estados Unidos (EE.UU.) firmaron hace muy pocos días un acuerdo de confidenciali-
dad, como paso inicial para alcanzar una asociación regulatoria en materia sanitaria de productos acuícolas y pesqueros. Esta acción, que en última instancia redundará en beneficios para los productores de camarón del país, tiene por objetivo el de reconocer a la Subsecretaría
de Calidad e Inocuidad ecuatoriana (SCI) como la entidad de control en Ecuador.
El acto simbólico tuvo lugar en la ciudad de Guayaquil con la presencia del ministro Julio José Prado; el viceministro de Acuacultura y Pesca, Andrés Arens; la subsecretaria de Calidad e Inocuidad, Diana Poveda; y los comisionados asociados de la FDA, Donald Prater y Mark Abdoo. Además, estuvieron presentes representantes del sector acuícola ecuatoriano.
Durante la ceremonia, Abdoo, comisionado Asociado de Política y Estrategia de la FDA, manifestó que esta alianza permitirá la creación de programas de importación de alimentos más efectivos y eficientes, lo que no solo beneficiará al sector del camarón sino a muchos otros productos ecuatorianos que quieren certificarse para exportar a EE.UU. Asimismo, Abdoo destacó el potencial de Ecuador como proveedor mundial de alimentos.


Con la firma de un acuerdo entre los Gobiernos de Ecuador y Estados Unidos se da un nuevo paso para la creación de programas de importación de camarón más eficientes
Por su parte, el ministro Prado destacó que el sector camaronero ecuatoriano cerró el año 2021 con una cifra total de exportaciones de más de USD 5,300 millones, casi un 40% más que en 2020. En tanto, hasta junio de 2022 las ventas al exterior, de este preciado bien, lograron ya USD 3,791 millones. “Garantizar el cumplimiento estricto de estándares de calidad e inocuidad es nuestra prioridad”, enfatizó Prado.
En el marco de esta nueva alianza, los delegados de la FDA visitaron Ecuador para evaluar las áreas de trabajo que regula la SCI y, específicamente, las relacionadas al sector acuícola, tales como criaderos, granjas, plantas procesadoras, fábricas y distribuidores de alimentos balanceados, y laboratorios. También, está previsto recibir cinco equipos de trabajo que realizarán la revisión documental y visitas técnicas,
y mantener reuniones con representantes del sector productivo y exportador del país.
Otra actividad que se tiene programada es la organización del curso de descomposición y entrenamiento sensorial organoléptico en camarones, previamente y como parte de esta alianza, se realizaron dos cursos de HACCP y de Buenas Prácticas de Acuacultura, informó el Ministerio de Producción, Comercio Exterior, Inversiones y Pesca ecuatoriano.
La Cámara Nacional de Acuacultura, impulsando la evolución desde el año 2010
En el acto realizado en la ciudad de Guayaquil estuvieron presentes también directivos de la Cámara Nacional de Acuacultura (CNA). “El propósito de este convenio es lograr una asociación regulatoria en materia sanitaria, con el fin de que tanto las autoridades ecuatorianas como estadounidenses puedan colaborar más cerca y poder ofrecer las garan-
tías y controles necesarios para el ingreso de productos pesqueros y acuícolas a ese mercado. Esto permitirá que las exportaciones acuícolas a los Estados Unidos ofrezcan las garantías oficiales, de tal manera de que se facilite el acceso a dicho país” expresó José Antonio Camposano, presidente ejecutivo de la CNA.
En tanto, Yahira Piedrahita, directora ejecutiva de la Cámara, puntualizó que “el acuerdo regulatorio que suscriben la FDA y la Subsecretaría de Calidad y de Inocuidad es el gran inicio de un proceso de colaboración entre nuestra autoridad sanitaria y la de uno de nuestros mercados más importantes. Esto nos permitirá que las exportaciones de camarón hacia Estados Unidos ofrezcan garantías oficiales, facilitando los procesos para el ingreso a este país. En lo personal, es algo que he venido impulsando desde el año 2010, cuando se discutía el borrador de la Ley de Modernización de los Alimentos de los Estados Unidos.

La Corporación Financiera Internacional (IFC, por sus siglas en inglés), una organización que forma parte del Grupo Banco Mundial, informó hace muy pocos días de que otorgará un préstamo de USD 45 millones a Industrial Pesquera Santa Priscila, el principal exportador de camarón de Ecuador. Con este préstamo, la IFC ayudará a la empresa a ampliar su número de granjas y mejorar su automatización, productividad y sostenibilidad.
“El financiamiento a largo plazo de IFC ayudará al crecimiento de nuestras operaciones. Con el apoyo de IFC, esperamos aumentar los niveles de productividad en más del 20% en términos de libras de camarón por hectárea. La experiencia de IFC también ayudará a elevar nuestros estándares operativos en términos de prácticas ambientales y sociales (A&S), gobierno corporativo y seguros, impulsando nuestra sostenibilidad para satisfacer la dinámica demanda del mercado”, aseguró Raúl Estrada, asesor corporativo de Santa Priscila.
La IFC, que es la principal institución internacional de desarrollo
dedicada al sector privado de los mercados emergentes, favorecerá a las granjas camaroneras ecuatorianas ayudándolas a reemplazar el diésel por electricidad en sus operaciones, mientras se abordan los riesgos ambientales en la producción de camarones. El objetivo es ayudar a mejorar la sostenibilidad
del sector, apoyando los objetivos climáticos de Ecuador.
Como cada día queda más patente, el sector camaronero es de vital importancia para la economía de Ecuador, originando aproximadamente el 20% de las exportaciones del país y el 5% del producto interno bruto (PIB). La inversión del IFC llega en un momento en el que el sector se enfrenta a una serie de desafíos relacionados con la baja productividad y la dependencia de los combustibles fósiles, que impiden la sostenibilidad general de la industria.
Los fondos de IFC solo se invertirán en granjas que estén adaptadas para replicar los estándares de certificación del Aquaculture Stewardship Council (ASC) o Best Aquaculture Practices (BAP), promoviendo buenas prácticas con beneficios de sostenibilidad. Alrededor del 42% del financiamiento contribuirá a la mitigación climática, evitando emisiones de aproximadamente 2,000 toneladas de CO2 equivalente al año.


Industrial Santa Priscila recibe un préstamo de USD 45 millones de la IFC para ampliar su número de granjas y mejorar su automatización, productividad y sostenibilidad
Apoyar el crecimiento a largo plazo
Alfonso García Mora, vicepresidente de Europa, América Latina y el Caribe de la Corporación, aseguró que “abordar el cambio climático
expanda, adopte prácticas agrícolas
tructura agrícola. Esto promoverá el crecimiento de la competencia y la productividad en este importante sector orientado a la exportación,

tor del camarón para hacer frente a
El directivo de la IFC destacó la importancia de apoyar las inversiones que contribuyen a la preservación del empleo y las exportaciones, algo que es fundamental para los esfuerzos de recuperación del país posteriores a la COVID-19.
Es de utilidad destacar que la IFC es la principal institución internacional de desarrollo dedicada al sector privado de los mercados emergentes. En el presente, trabaja en más de 100 países y utiliza su capital, sus conocimientos especializados y su influencia para crear mercados y oportunidades en los países en desarrollo.
y apoyar el crecimiento a largo plazo es una prioridad clave para IFC en América Latina y el Caribe.
La inversión de IFC apoyará a uno de los principales productores de camarón de Ecuador para que se
Durante el ejercicio 2021, IFC comprometió una cifra récord de USD 31,500 millones para empresas privadas e instituciones financieras en los países en desarrollo, aprovechando la capacidad del sector privado para ayudar a poner fin a la pobreza extrema e impulsar la prosperidad compartida cuando las economías abordan los impactos de la pandemia de COVID-19.

Con este nuevo centro de experimentación acuícola especializado en la validación de tecnologías, Nicovita continúa fortaleciendo su red de investigación y desarrollo para soluciones integrales de camarón blanco. Se trata de la red de investigación y desarrollo más grande del mundo para este segmento.
Por: Nicovita*Fieles al compromiso de acompañar el agresivo crecimiento de la industria, y bajo una constante preocupación por contribuir al desarrollo sostenible de la industria, Nicovita marca un nuevo hito en la investigación y desarrollo acuícola con la firma de un convenio para implementar y poner en funcionamiento el primer Centro Experimental para el desarrollo de Tecnología Acuícola de camarón (CEA Tecnológico) del Ecuador.
Se trata de un espacio vivencial y experimental de investigación, el cual contará con un conjunto de piscinas de cultivo de camarón y un grupo de expertos destinado a la validación de tecnologías existentes, nuevas y propias de Nicovita; así como al desarrollo de nuevas soluciones tecnológicas que contribuyan a mejorar la productividad, los niveles de eficiencia y la rentabilidad en el cultivo de camarón, contribuyendo así al desarrollo sostenibilidad de la industria.


“Instalar este nuevo Centro Experimental Acuícola para el desarrollo de tecnología evidencia con acciones nuestro compromiso de continuar realizando importantes inversiones para acompañar el crecimiento sostenido de la industria. Para nosotros es un gran orgullo comunicar este importante hito, ya que además continúa consolidando a Nicovita como la marca con la red de centros de investigación e innovación para camarón más importante del mundo”, destacó















Fabricio Vargas, Gerente General de Vitapro Ecuador.
El nuevo Centro Experimental Acuícola para desarrollo Tecnológico (CEA Tecnológico) cierra el círculo virtuoso de Nicovita en cuanto a investigación, ya que complementa la generación de conocimiento que se realiza en su laboratorio central y planta piloto, así como en la red de cuatro centros experimentales dedicados a la nutrición y desafíos sanitarios que Nicovita ha instalado en Perú (Trujillo, Lima, Tumbes) y México, respectivamente.
Este nuevo proyecto es una muestra más de la confianza de Nicovita en el sector, acompañando su crecimiento exponencial con inversiones, como lo son la construcción de su nueva planta de producción anunciada a inicios de este año y la ampliación de su capacidad de producción realizada en el 2021
El compromiso de Vitapro y su marca Nicovita de transformar la acuicultura se hace tangible en la generación de conocimiento con el respaldo científico que la industria necesita, impulsando al sector a tener la confianza para continuar evolucionando. Con esta apuesta, Nicovita da un salto importante en su trabajo de investigación en
tecnología, dándole mayor protagonismo al respaldo científico de la información.
Por ello, las pruebas para determinar cuál es la tecnología que funciona mejor en los cultivos y cómo operarla de la manera más adecuada, se realizarán siguiendo una metodología de diseño experimental, los cuales se complementará con la rigurosidad estadística y respaldo científico que permiten transformar el conocimiento en recomendaciones válidas, a través de la asesoría técnica de Nicovita, para la toma de decisiones en campo fundamentadas en datos.
La investigación será desarrollada por un equipo multidisciplinario integrado por profesionales con amplia experiencia en el mercado camaronero.

Al igual que las soluciones nutricionales y recomendaciones de alimentación de Nicovita, diseñadas “a la medida” y de acuerdo a la realidad del productor camaronero, en el CEA Tecnológico la investigación se implementará en un sistema de producción abierto, que simulará la realidad de la mayoría de productores en Ecuador y Latinoamérica.
Por eso, es posible afirmar que el CEA Tecnológico permitirá expe-
rimentar y desarrollar soluciones enfrentando las mismas variables geográficas, climáticas, físicas, de temperatura, entre otras, que viven a diario los productores de camarón.
Esto es posible gracias a su ubicación estratégica, que se definió luego de realizar una búsqueda exhaustiva hasta encontrar la zona adecuada para el nuevo proyecto. Después de estudiar 14 localidades, Nicovita decidió ubicarlo en el cantón Naranjal, a dos horas de Guayaquil, en la costa ecuatoriana, porque reúne condiciones similares a las fincas camaroneras en términos de salinidad, temperatura, lluvias, entre otras, y posee características que son extrapolables al resto del sector.
El CEA Tecnológico es el punto de partida de nuevas y mayores inversiones enfocadas en tecnología que pronto Nicovita lanzará al mercado, fortaleciendo la infraestructura de investigación experimental en campo del sector camaronero y consolidándola –nuevamente–como su principal socio estratégico. De esta forma, Nicovita continúa dando sólidas evidencias de liderazgo en innovación en la industria acuícola, e impulsando la incorporación de nuevas tecnologías en los cultivos como un habilitador para transformar la acuicultura de una manera sostenible, y evolucionar con confianza.
Sobre Nicovita y Vitapro Vitapro, a través de su marca Nicovita, es una corporación en constante crecimiento que ofrece las mejores y más eficientes soluciones integrales de nutrición y tecnología con el firme propóstito de transformar la acuicultura para nutrir el mañana. Desde hace más de dos décadas, apuesta por la sustentabilidad de la industria acuícola y la rentabilidad de sus clientes. Es así como se ha convertido en una marca líder en Latinoamérica con presencia en Ecuador, Perú, Chile y gran parte de Latinoamérica.
Conoce más de Vitapro y su marca Nicovita en sus redes sociales: LinkedIn @nicovitaoficial www.nicovita.com www.vitapro.com.pe
Este artículo es patrocinado por NICOVITA.


Vibriohepatarius
Bacillus cereus sensu stricto
Hallazgos recientes indican que el uso preventivo de cepas probióticas con capacidad de colonización aumenta la protección de las larvas, lo que representa una estrategia prometedora en el control de la enfermedad de necrosis hepatopancreática aguda en criaderos de larvas de camarón.
Por: Redacción de PAM*Las enfermedades bacterianas producidas o inducidas por especies del género Vibrio han causado importantes pérdidas económicas en el cultivo de camarones en todo el mundo, debido a tasas de mortalidad masiva de hasta 100%. Un ejemplo reciente es la enfermedad de necrosis hepatopancreática aguda (AHPND, por sus siglas en inglés) que afecta principalmente a postlarvas (PL) y camarones peneidos juveniles.
Diversas investigaciones revelan que la AHPND es causada por cepas virulentas de Vibrio parahaemolyticus, portadoras del plásmido virulento PVA1 que contiene los genes de las toxinas PirA y PirB. Lai et al. (2015) determinaron que cuando V. parahaemolyticus coloniza el estómago del camarón, este comienza a producir toxinas PirA y PirB, las cuales llegan a la hepatopán-
creas, provocando lesiones graves. En Centroamérica se han reportado pérdidas debidas a la AHPND en criaderos de larvas de camarón; mientras que, estudios epidemiológicos realizados en Suramérica en 2017, indicaron que la alta mortalidad registrada en criaderos estaba asociada con V. parahaemolyticus, portador de estas toxinas.
La vibriosis se ha tratado de manera tradicional con antibióticos con fines profilácticos y terapéuticos con pobres resultados, además de inducir resistencia bacteriana, incluso en V. parahaemolyticus, existiendo el riesgo de acumulación de residuos en el ambiente.
En Ecuador, distintos estudios con bacterias marinas aisladas localmente, han demostrado tener efectos beneficiosos en cultivos de Penaeus vannamei. Se determinó que la supervivencia y el rendimiento de estanques sembrados con larvas de camarón tratados con Vibrio diabolicus (Ili) fue mayor en comparación con estanques sembrados con larvas no tratadas. El Vibrio hepatarius (P62) y la cepa probiótica P64, recientemente identificada como cepa probiótica Bacillus cereus sensu stricto, incrementaron la respuesta inmune de juveniles de P. vannamei, resultando en un efecto positivo sobre la supervivencia en estanques tratados (Gullian et al., 2004; Aguayo et al., 2009).
En este artículo se presentan los resultados de un estudio cuyo objetivo fue caracterizar la presencia de apéndices de bacterias en la superficie celular en las cepas probióticas, mediante microscopía electrónica de barrido en modo de transmisión; para luego evaluar la capacidad de colonización de los probióticos marcados en las PL de P. vannamei utilizando microscopía de fluorescencia y confocal.
Los probióticos V. diabolicus (cepa Ili), V. hepatarius (cepa P62), B. cereus s.s. (cepa P64) y V. parahaemolyticus (cepa BA94C2) patógeno causante de AHPND en camarones, fueron proporcionados por el Departamento de Microbiología del Centro de Investigación Nacional de Acuicultura y Marina (CENAIM, ESPOL).
Inicialmente, las tres cepas de probióticos se caracterizaron mediante microscopía electrónica
de barrido. Luego, se determinó la capacidad de colonización de estas en larvas de camarón P. vannamei mediante su exposición directa a probióticos previamente teñidos con colorantes flurocromos, naranja de acridina (AO, por sus siglas en inglés), azul de Evans y 4′ , 6-diamidina-2-fenilindol (DAPI). Las larvas se observaron por medio de epifluorescencia y microscopía
confocal. Al final, se evaluó el consorcio de probióticos en larvas de P. vannamei en un cultivo de larvicultura (Nauplii 5 hasta PL8), donde se aplicaron los tres probióticos diariamente. El ensayo incluyó un grupo control sin la aplicación de probióticos. Después de 16 días de cultivo, las larvas tratadas con el consorcio microbiano y el grupo control fueron desafiadas con una cepa patógena de V. parahaemolyticus causante de AHPND.

En la Figura 1, se muestran microfotografías de microscopía electrónica de barrido centradas en la observación de fimbrias y flagelos en las células. Celularmente, Ili es ovalado, presentando extremos redondeados con un tamaño de 1.3 a 2.2 μm de largo y 0.6 a 0.9 nm de ancho, con una presencia distintiva de numerosos flagelos laterales (Figura 1A). P62 tiene células de forma ovalada con un tamaño de 1.4 a 2.7 μm de largo y 0.8 a 1.7 μm de ancho con una estructura de membrana plasmática muy bien definida, donde se anclan las fimbrias (Figura1B). P64 tiene una forma bacilar característica con un tamaño de 1.5 a 2.9 μm de largo y 0.8 a 1.2 μm de ancho, además de una membrana plasmática bien definida con presencia de flagelos y fimbrias (Figure 1C). Los tres probióticos formaron biopelículas después de 48 h de incubación. Sin embargo, la biopelícula más fuerte la formó la bacteria probiótica Ili (p < 0.05), seguida de P62 y P64. Estos resultados se confirmaron cuando las biopelículas se tiñeron con naranja de acridina.

Ensayos de motilidad en enjambre de bacterias probióticas
El probiótico Ili y P62 presentaron menor motilidad de enjambre a 25°C. Ili alcanzó su máximo crecimiento a 27°C (p <0.05). La migración de Ili fue significativamente mayor a las temperaturas estudiadas que la de las otras bacterias probióticas (p < 0.05). La motilidad de enjambre de P64 no se vio afectada de forma negativa por la baja temperatura, siendo significativamente mayor (p < 0.05) a 25°C en comparación con el probiótico P62 (Tabla 1).
Ensayo de colonización de bacterias probióticas en larvas de camarón
La microscopía confocal permitió verificar la capacidad de adhesión de las tres bacterias probióticas a la cutícula y tripa del camarón. La Figura 2A muestra la cepa de probiótico Ili adherida a la zona oral.


En la Figura 2B, la cepa de probiótico P62 aparece adherida a la membrana peritrófica del intestino. En la Figura 2C, el probiótico P64 teñido con DAPI se detecta en las células de los urópodos.
Se evaluaron las características protectoras de los tres probióticos por su interacción con V. parahaemolyticus causante de AHPND. Las
larvas en estado Z3 expuestas a V. parahaemolyticus fueron completamente colonizadas, observándose larvas fuertemente teñidas con AO (Figura 3A). Si las larvas fueron colonizadas de forma previa con cada probiótico individual, la señal de V. parahaemolyticus fue menor y restringida a la cutícula externa y a una sección del ciego del intestino medio lateral (Figura 3B, C, D). Cuando las larvas fueron colonizadas por el consorcio de probióticos, solo se detectó una señal débil del Vibrio patógeno en la cutícula externa (Figura 3E y F), y no se detectó ninguna señal en el sistema digestivo. Las larvas del control negativo exhibieron una débil señal de fluorescencia cuando se trataron con los sobrenadantes de las bacterias teñidas con AO. Solo se detectó
fluorescencia natural en las larvas tratadas con el sobrenadante (libre de bacterias) de las bacterias teñidas con DAPI y azul de Evans.
Ensayos in vivo, prueba de desafío de larvas de camarón cultivadas con la exposición al consorcio de probióticos
Al finalizar el cultivo de larvas, la tasa de supervivencia de PL8 tratadas con el consorcio de probióticos fue de 83.8%, sin diferencias significativas al compararla con las larvas no tratadas (84.4%). Sin embargo, después del desafío con V. parahaemolyticus, causante de AHPND, la tasa de supervivencia de las larvas tratadas con el consorcio de probióticos fue de 75.33 ± 12.62%, significativamente mayor (p < 0.05) que la de las larvas control (32.27 ± 9.57%).
En ambientes de larvicultura, los vibrios patógenos del camarón exhiben la capacidad de proliferar planctónicamente en el agua, así como colonizar de manera rápida al camarón. Por lo tanto, las bacterias probióticas deben ser capaces de competir por estos espacios, exhibiendo habilidades de colonización. Las observaciones microscópicas, así como los resultados in vitro vivo e in vivo obtenidos en el estudio, indican que los probióticos Ili, P62 y P64 poseen los apéndices de superficie celular necesarios para la colonización de las superficies del huésped. Las larvas expuestas al consorcio probiótico exhibieron una alta supervivencia después del desafío con V. parahaemolyticus que causa AHPND. En consecuencia, la aplicación del consorcio probiótico en P. vannamei en criaderos podría proporcionar a las larvas un efecto protector frente a Vibrio spp. patógeno.
La microscopía electrónica permitió determinar que la robusta motilidad en enjambre observada en el probiótico Ili podría explicarse con la gran cantidad de flagelos laterales que posee esta bacteria. Se establece que el comportamiento bacteriano de motilidad de enjambre sobre superficies sólidas está mediado por flagelos laterales. El probiótico P64 también se caracteriza por tener flagelos laterales y su motilidad de enjambre es mayor que la del P62, en el cual no se detectaron estos apéndices celulares. Los flagelos laterales no solo facilitan la motilidad de enjambre, sino que contribuyen a la adhesión a la superficie, facilitando la formación de biopelículas (Merino et al.,
2006). Esto también explicaría porqué se observaron biopelículas más desarrolladas en la cepa Ili.
Otra estructura celular bacteriana no flagelar que facilita la formación de biopelículas son las fimbrias. Estas fueron muy abundantes en P62, una bacteria que exhibió biopelículas más robustas que P64, en la que se observaron menos fimbrias.
En conjunto, los tres probióticos colonizaron las superficies externa e interna de las larvas. La ocupación de estas localizaciones podría ser uno de sus principales mecanismos de acción. En este sentido, cabe señalar que V. parahaemolyticus causante de AHPND infecta al camarón colonizando primero las superficies del estómago, donde genera toxinas que pueden penetrar la hepatopáncreas y, por lo tanto, destruirlo. Si estos sitios ya están ocupados por probióticos, la patogenicidad de V. parahaemolyticus podría reducirse. Se consiguió la exclusión completa de V. parahaemolyticus causante de AHPND en el intestino cuando se empleó el consorcio de probióticos. En otras palabras, hubo una colonización eficiente del intestino y la cutícula externa por Ili y P62 y una colonización del intestino y la membrana peritrófica del intestino por P64.
Los tres probióticos generaron una fuerte señal fluorescente en el ciego del intestino medio lateral. Se detectó una fuerte señal fluorescente para P64 en la base de las setas del urópodo y en las células subyacentes, indicando que esta podría ser una posible vía de entrada al menos para este probiótico (Figura 2C). De hecho, se observó una fuerte señal de P64 en las células del epitelio intestinal (Figura 4). Por lo
tanto, se supone que estas bacterias pueden penetrar en el hemocele del huésped.
Las larvas de camarón cultivadas con el consorcio probiótico exhibieron una mejor supervivencia (75%) cuando fueron expuestas a V. parahaemolyticus causante de AHPND. Los probióticos adheridos a las cutículas externas y a las superficies internas con capacidad de exclusión competitiva contra el patógeno V. parahaemolyticus puede explicar estos niveles de supervivencia.
Los probióticos Ili, P62 y P64 poseen fimbrias y flagelos, apéndices de la superficie celular, necesarios para la colonización de superficies a través de biopelículas y motilidad de enjambre. Estos probióticos colonizan las larvas de los camarones excluyendo el patógeno V. parahaemolyticus que causa AHPND, hallazgos fundamentales en el desarrollo de nuevos probióticos para la industria acuícola.
Esta es una versión resumida desarrollada por el equipo editorial de Panorama Acuícola Magazine del artículo “THE PROBIOTICSVIBRIO DIABOLICUS (ILI),VIBRIOHEPATARIUS(P62),AND BACILLUSCEREUSSENSUSTRICTO(P64) COLONIZE INTERNAL AND EXTERNAL SURFACES OF PENAEUS VANNAMEI SHRIMP LARVAE AND PROTECT IT AGAINSTVIBRIO PARAHAEMOLYTICUS” escrito por MERYRAMÍREZ-Escuela SuperiorPolitécnicadelLitoral,ESPOLand Universidad Estatal Península de Santa ElenaUPSE;CRISTOBALDOMÍNGUEZBORBOR-EscuelaSuperiorPolitécnica delLitoral,ESPOL;LIZETHSALAZAR,ALEXIS DEBUTyKARLAVIZUETE-Universidadde lasFuerzasArmadasESPE;STANISLAUS SONNENHOLZNER-EscuelaSuperior PolitécnicadelLitoral,ESPOL;FRANK ALEXIS-UniversidadYachayTech; JENNYRODRÍGUEZ-EscuelaSuperior PolitécnicadelLitoral,ESPOL.La versión original, incluyendo tablas y figuras, fue publicada en DICIEMBRE de 2021 en ACUACULTURE. Se puede acceder a la versión completa a través de https://doi. org/10.1016/j.aquaculture.2021.737826

En Geoforest-Ecuador utilizamos automatización robótica de procesos para crear fotografías georeferenciadas de alta calidad y, con esto, diseñar modelos tridimensionales con precisiones centimétricas. Nuestro desafío es brindar nuevos avances tecnológicos y combinarlos con conocimientos fundamentales de las técnicas de mensura de la tierra con la fotogrametría, para dar respuesta a las necesidades de sectores como la acuicultura.
La topografía es una ciencia que se encarga de obtener con rigurosidad y, en muchos casos, precisión y posición de puntos en la superficie de la tierra para su posterior representación en un plano. Para ello, a lo largo de la historia se han utilizado variados elementos y equipos de apoyo con la finalidad de levantar esta información y dejarla plasmada en planos.
Este levantamiento planimétrico, batimétrico, altimétrico, etc., que necesita un trabajo de información de campo cada vez más rápido y preciso, ha hecho que revolucione la tecnología, lográndose levantar en la actualidad a través de escáneres digitales 3D, estaciones totales y drones. Estos instrumentos, en especial los drones, ayudan al topógrafo a obtener y recolectar datos en cues-
tión de segundos en sus laptops o en sus libretas electrónicas de campo; situación que en años anteriores nos remontaba a eternos cálculos de poligonales en gabinete desde nuestra sagrada libreta de anotaciones de mediciones taquimétricas.
Así, junto a nuestro equipo Geoforest-Ecuador, con el respaldo del GRUPO INDUAUTO – INDUSUR, nos hemos planteado el desafío de brindar nuevos avances tecnológicos y combinarlos con conocimientos fundamentales de las técnicas de mensura de la tierra con la fotogrametría, para dar respuesta a las exigencias actuales del mundo laboral.
Un dron de topografía representa un enorme potencial para topógrafos y profesionales de Sistemas de Información Geográfica (SIG). Con un dron, es posible llevar a cabo levantamientos topográficos de la misma calidad que aquellos realizados recopilando medidas de alta precisión a través de levantamientos topográficos tradicionales, aunque en una fracción del tiempo. Esto reduce considerablemente el costo de la topografía y del volumen de trabajo sobre el terreno.
En Geoforest-Ecuador, utilizamos automatización robótica de procesos (RPA, por sus siglas en inglés) para crear fotografías georeferenciadas de alta calidad y, con esto, modelos tridimensionales con precisiones centimétricas. Contamos con amplia experiencia en la elabo-

ración de productos cartográficos de gran resolución a distintas escalas y nuestras soluciones son transversales a diferentes sectores como: 3 Acuicultura, en el levantamiento de altimetría, batimetría y superficie, diseño y construcción de camaroneras.
batimetría y superficie, diseño y construcción de camaroneras.
3 Topografía de precisión en planimetría, altimetría e identificación de infraestructura y servidumbres.
3 Obra civil, arquitectura y urbanismo en el levantamiento de infraestructura, cortes, rellenos, ubicación de puntos de control y de arranque constructivo, tanto

para el seguimiento de obras como para el cálculo de volumen de movimientos de tierras; nuestros RPA se adaptan perfectamente a cada proyecto.

3 En la industria de la construcción, sus tareas incluyen control de deformaciones, apoyo a protocolos de daños y estudio de patologías, seguimiento de grietas, geometría de cubiertas, control de asentamientos, verticalidad de fachadas y análisis de los estados actuales de las edificaciones.
3 En seguridad industrial permite conocer e identificar el área de trabajo y los riesgos que pueden correr los trabajadores, así como identificar si cuentan o no con equipos y herramientas de protección.
3 Los inventarios forestales y cálculos de masa arbórea jamás han sido tan fáciles como con nuestros drones, porque permiten hacer conteos a escala y ubicar parcelas de muestreo georreferenciadas, además de identificar plagas, prevenir incendios y contribuir al mantenimiento, cuidado
En Geoforest-Ecuador, utilizamos automatización robótica de procesos para crear fotografías georeferenciadas de alta calidad y, con esto, modelos tridimensionales con precisiones centimétricas.
3 Seguimiento de obras, es una de nuestras técnicas para construcción y la mejor manera de mostrar lo que ha ocurrido en una obra durante días o meses. Captamos fotografías para slides comparativos, realizamos videos de seguimiento y “time lapse”.
3 Asistencia técnica en obras con equipos de campo y de precisión como navegación cinética satelital (Real-Time Kinematic, RTK), estaciones totales, niveles automáticos, etc., con oficina técnica.
3 Realizamos el seguimiento de la ejecución del proyecto, adaptándonos a las necesidades del cliente, aportando equipo técnico experimentado y material topográfico necesario, utilizando siempre los últimos avances tecnológicos para cada tipo de trabajo.
3 Disponemos de oficina técnica, la cual estudia su proyecto tanto en la fase de licitación como durante su ejecución. Este trabajo se puede realizar en nuestras oficinas, en la suya o desplazándonos directamente a la obra.
Los sectores de agricultura y acuicultura son de los pilares más importantes en el desarrollo de
nuestro país y cumplen un rol importante en nuestra economía. Entre las múltiples razones para afirmar lo anterior, se pueden resaltar dos: 1) son una fuente significativa de generación de empleos en el Ecuador y, por ende, contribuyen a la reducción de la pobreza, y 2) hacen posible brindar seguridad alimentaria a la población. Por estas y otras razones, no es difícil imaginar que desde hace algunas décadas se haya empezado a implementar herramientas dirigidas a promover una producción más eficiente y segura, herramientas basadas en los sistemas de información geográfica y, más recientemente, modernizando el sistema a través del uso de la fotogrametría con drones para llevar a cabo un trabajo eficaz y actualizado en tiempo real.
Con Geoforest-Ecuador, la fotogrametría con drones realiza mapeos fáciles de usar, brinda datos topográficos consistentes de alta calidad de manera más rápida, crea modelos digitales del terreno (MDT) para desarrollar cartografía 3D y mapas vectoriales, todo a menor costo que otras herramientas topográficas.

Hemos ejecutado proyectos de canales de riego, canales de aguas residuales, vías, construcciones civiles, levantamiento de predios, altimetrías, batimetrías, edificaciones, camaroneras, cultivos agrícolas, caídas de agua y gradientes, etc.
Nuestro equipo dispone de la acreditación del título oficial de piloto de drones y somos operadores autorizados, contamos con experiencia en ingeniería civil, ordenamiento territorial, ambiental y forestal y, sobre todo, regularizados con el Ministerio de Ambiente, Agua y Transición Ecológica (MAATE).
Nuestro compromiso fundamental es saber si el vuelo con dron puede obtener los resultados requeridos por el cliente, en cuanto a admisión de errores, antes de presupuestar cualquier proyecto. Para realizar los vuelos con dron es esencial cumplir con las condiciones óptimas exigidas por las entidades competentes de la zona. Por esa razón, insistimos en realizar visitas in situ para conocer el estado actual de camaroneras, vegetación, altura de edificaciones, redes eléctricas, servidumbres, etc., y concretar una reunión previa con el cliente con la finalidad de evaluar a fondo la situación.
Al cliente le ofrecemos la máxima confianza y tranquilidad de disponer de todos los permisos concedidos y toda la documentación en vigor antes de comenzar los trabajos.
Este artículo es patrocinado por GEOFOREST ECUADOR, con el respaldo del Grupo Induauto - Indusur.
Contáctanos: en Instagram como: geoforest.ec Consulta proyectos varios: 0999485502 - 0988962509


Una alimentación adecuada determina un buen crecimiento y reproducción de los organismos de cultivo. NeoShrimp® ofrece una combinación única de características y beneficios para larvicultura, contribuyendo con el éxito de los sistemas de producción de camarones y, por ende, con el desarrollo sostenible de la industria.
 Redacción de PAM*
Redacción de PAM*
En la industria acuícola, la alimentación puede significar más del 50% de los costos directos de producción. En consecuencia, el éxito o fracaso de los cultivos depende en gran medida del tipo y características de los alimentos y de la eficiencia en su uso. Una alimentación adecuada de la especie de cultivo es aquella que asegura el suministro de los nutrientes necesarios, donde juega un papel fundamental la fuente de la cual se obtienen estos nutrientes, para lograr alta digestibilidad, crecimiento esperado y la salud de los organismos, además de la calidad del producto final.
Cada especie posee diferentes condiciones de cultivo, necesidades biológicas, comportamientos de alimentación y requerimientos nutricionales particulares. Por tanto, el alimento que se suministra depende de diversos aspectos como: especie, tamaño y edad del pez; hábitos alimenticios de las especies cultivadas; sistema de cultivo a emplear y fase o etapa de desarrollo.
Un caso particular es la camaronicultura, debido al comportamiento de alimentación específico de los camarones, caracterizado por su lentitud. Al ser masticadores externos, mordisquean los alimentos muy lentamente, lo que resulta en un tiempo prolongado de per-
manencia del alimento peletizado en el agua. Como consecuencia, los nutrientes presentes en el alimento se lixivian o se disuelven en el agua. La lixiviación representa uno de los principales problemas en el cultivo de camarones porque la ingesta de nutrientes consumidos y utilizados no cumple con el nivel que en teoría debería suministrarse con el alimento para satisfacer los requerimientos del camarón.
Al no cumplirse los requerimientos nutricionales debido al desbalance en la dieta, se afecta el crecimiento, así como otros parámetros de productividad. Además, la calidad del agua de cultivo se ve afectada negativamente por la lixi-

NeoShrimp® es un alimento de alta calidad para larviculturas y precrías de camarones, elaborado mediante una avanzada tecnología que asegura una alta estabilidad y calidad de los nutrientes del alimento y muy bajos niveles de lixiviación.
viación, y el exceso de compuestos nitrogenados que se generan.
Al hablar de la producción comercial de camarón, es necesario tener presente que se basa en la siembra de postlarvas, la cual tiene dos fuentes de abastecimiento: larvicultivos y medio silvestre. Independientemente de su origen, el factor que determina el éxito de una operación comercial de engorde es su calidad. Asimismo, se ha demostrado que el cultivo de camarón se apoya en la capacidad de siembra en cualquier época del año, sin depender de la producción silvestre de postlarvas, de tal modo que se incremente la disponibilidad de camarón para cualquier mercado. Esta capacidad se adquiere exclusivamente con el desarrollo biotecnológico de los larvicultivos lo que permite la permanencia en el mercado, además de los múltiples factores biotécnicos, donde la alimentación y las enfermedades juegan un papel fundamental.
El reto del larvicultivo es la producción de organismos similares a los producidos en la naturaleza, aunque, como se mencionó anteriormente, alimentación y enfermedades son factores clave, debido a que pueden ocasionar una alta tasa de mortalidad. La alternativa para controlar estos factores de la producción masiva, es el uso de alimento artificial de alta calidad con capacidad para mantener un ambiente saludable, reducir el riesgo de enfermedades y permitir una disminución sustancial en los altos costos del alimento vivo, que a menudo presenta una alta variabilidad nutricional.
La alimentación artificial en el cultivo de camarón
La larvicultura consiste en la crianza de larvas planctotróficas que pasan por varios estadios, los cuales poseen distintas estrategias de alimentación. En la naturaleza, las larvas dependen básicamente de diatomeas y zooplancton que les brindan sus requerimientos nutricionales. En laboratorio y cultivo, se trata de emular la alimentación natural a través de cultivos masivos
monoalgales y de Artemia. Dichos cultivos presentan una alta variabilidad en su producción y calidad, por lo que los beneficios obtenidos para los organismos no son los esperados.
En consecuencia, se ha desarrollado el alimento artificial, cuya aplicación radica en el reemplazo parcial o total del alimento vivo. El alimento artificial puede clasificarse, de acuerdo a su presentación en seco o líquido. Los alimentos secos gozan de gran popularidad por ser los primeros en ser lanzados al mercado. Sin embargo, con el avance científico en acuicultura se han desarrollo diferentes tipos de alimentos para disminuir los problemas de lixiviación y estabilidad, como microcápsulas, alimento microligado y microcubierto, además de lipoesferas hidroestabilizadas y microemulsiones estables. Las actividades de investigación y desarrollo se centran cada vez más en la búsqueda de ingredientes digeribles y asimilables que promuevan “un ambiente amistoso” con las larvas sin olvidar el aspecto económico, estableciendo el uso proporcional del alimento y el cuidado del medio ambiente.
MEGASUPPLY es una empresa fundada en 1995 dedicada exclusivamente a brindar productos alimenticios, probióticos, insumos, equipos y asesoría al mercado acuícola; ofreciendo a sus clientes, socios y proveedores el valor agregado de contar con un personal técnico de formación universitaria en el área de acuicultura y con experiencia en el área de producción acuícola. A partir de este conocimiento técnico, es capaz de entender y proporcionar soluciones ante cualquier dificultad o necesidad que se presente en los cultivos, mantener actualización constante del personal, representar y proveer alimentos y equipos de alta calidad y con la tecnología más avanzada.
La misión de MEGASUPPLY es ser un socio estratégico de sus clientes, proveedores y empleados
generando valor en la distribución de equipos, suministros, alimentos, probióticos, químicos y servicios en general en todo lo relacionado a la industria acuícola. Su política se basa en el éxito de sus clientes, proveedores y socios, proporcionando productos de valor agregado y servicios que siempre satisfagan y excedan sus necesidades y expectativas. Atendiendo a los paradigmas que sustentan la innovación, la gerencia promueve la participación plena de los empleados en la revisión y mejora continua de los procesos de negocio y de calidad total.
Cuenta con oficinas, almacenes y asistencia técnica en diferentes países desde donde atiende a todos sus clientes alrededor del mundo. Una de estas sedes se ubica en Ecuador, la cual ofrece productos únicos e innovadores para laboratorios, precrías y granjas de camarones, al igual que a laboratorios de peces.
NeoShrimp®: innovación y calidad
NeoShrimp® es un alimento de alta calidad para larviculturas y precrías de camarones, elaborado mediante un proceso de microextrusión fría seguido de esferización. Esta avanzada tecnología asegura una alta estabilidad y calidad de los nutrientes del alimento y muy bajos niveles de lixiviación.
Características distintivas de
Contiene MegAcidG® , brindando una mejor salud y digestión.
9 Alimento de alta digestibilidad. Solo contiene proteínas animales de origen marino, su digestibilidad de proteína en larvas de camarón es superior al 95%, comparado con 60% a 80% en la mayoría de las dietas secas.
9 Producido a baja temperatura, lo cual garantiza la integridad de nutrientes, vitaminas y minerales.
9 Muy bajo nivel de lixiviación.
9 Excelente calidad de agua.

NeoShrimp® posee un alto contenido de proteínas, importante para el crecimiento y el mantenimiento en las etapas de larva y precría de camarones. Entre sus ingredientes se cuentan: proteínas de origen marino, aceites marinos, lípidos olefínicos, nucleótido de levadura, colesterol, premezcla mineral, carbonato de calcio, ácidos orgánicos (MegAcidG®) y premezcla vitamínica, tal como se detalla en la Tabla 1.
su descomposición en la columna de agua produce altos niveles de compuestos tóxicos como el amonio. Uno de los importantes avances del NeoShrimp® es poder ofrecer proteínas y nutrientes altamente digeribles a las larvas y postlarvas de camarón, las cuales inciden positivamente en la calidad y la producción, mejorando la calidad del agua de cultivo.
El uso adecuado del producto NeoShrimp® le permite al acuicultor alcanzar óptimos resultados, por lo que la empresa ofrece recomendaciones precisas para contribuir al logro de los objetivos de producción:
9 Mezclar la dosis de alimento con agua limpia y distribuirla por todo el tanque.
9 Dividir la cantidad sugerida en 4 a 6 alimentaciones al día.
9 Vida útil: 2 años si se almacena en las condiciones recomendadas.
MEGASUPLY, empresa cuya misión es ser socio estratégico de sus clientes, proveedores y empleados generando valor a través de la distribución de productos alimenticios, probióticos, insumos, equipos y asesoría al mercado acuícola, procura el éxito de la industria en conjunto, de manera sostenible, desarrollando productos únicos. En su categoría de alimentos, brinda productos de alta calidad con ingredientes patentados dirigidos a las características específicas y requerimientos de cada especie y proceso de cultivo.

Las fórmulas alimenticias y los esquemas de alimentación deben satisfacer los requerimientos nutricionales del camarón; por tanto, el manejo adecuado del alimento es esencial para optimizar el uso de nutrientes y reducir la contaminación ambiental.
Tomando en consideración que el alimento representa una parte importante de los costos de producción en la cría de camarones, se recomienda mejorar la eficiencia en su uso con la finalidad de incrementar la rentabilidad del cultivo y reducir su impacto sobre el ambiente.
Es frecuente leer sobre la relación entre alimentos de alto nivel de proteínas y el incremento de metabolitos tóxicos en el agua de cultivo. Sin embargo, es importante conocer la razón de esta aseveración. La gran mayoría de alimentos para larvas de camarones en el mercado contiene un alto porcentaje de proteínas de origen vegetal terrestre, las cuales no son totalmente digeridas por estos organismos dado que su sistema enzimático digestivo no es capaz de procesarlas de manera adecuada.
En consecuencia, estas proteínas vegetales terrestres pasan al agua de cultivo, en gran parte intactas, y
9 Evitar la sobrealimentación y subalimentación mediante la observación frecuente de la salud larval y el remanente de alimento en el tanque previo a la próxima alimentación.
9 Alimentar de 4 a 6 veces al día de Z1 a PL1 y de 6 a 24 veces al día de PL2 a PL26.
NeoShrimp®: múltiples opciones de empaque y tamaño NeoShrimp® se ofrece en envases y bolsas de diferente peso y tamaño de partícula, de acuerdo con los diferentes requerimientos del cliente:
9 Envases de 1 kg: < 75 µm, 75-100 µm, 100-150 µm.
9 Envases de 3 kg: 150-250 µm.
9 Envases y bolsas de 10 kg, 12 kg y 20 kg: 250-350 µm, 350-500 µm, 500-800 µm, 800-1,200 µm.
En cuanto a condiciones en las cuales debe almacenarse este producto, se considera conveniente:
9 Mantener el empaque cerrado en un lugar seco y fresco.
9 Se recomienda una temperatura de almacenamiento comprendida entre un mínimo de 5°C y un máximo de 25°C. No se debe congelar, ni permanecer a temperaturas superiores a 40°C.
Su producto NeoShrimp® para larviculturas y precrías de camarones fue desarrollado mediante un proceso avanzado de tecnología de microextrusión fría seguido de esferización, que asegura una alta estabilidad y calidad de los nutrientes del alimento y muy bajos niveles de lixiviación, manteniendo una excelente calidad del agua, representando una inmejorable opción alimenticia para el desarrollo sostenible del creciente sector productivo de cultivo de camarones.
Este artículo es patrocinado por Megasupply Distribuido en Ecuador por: Distribuidora Acuícola Megasupply del Ecuador, S.A. Cdla. Puerta del Sol Mz. 48 SI.1, Salinas, Provincia de Santa Elena, Ecuador. Tlf. +593 98 508-1404 www.megasupplyecuador.com ventas.ecuador@megasupply.net
Este es un artículo desarrollado por el equipo editorial de Panorama Acuícola Magazine a partir de la ficha técnica del producto “NEOSHRIMP®”proporcionada por la empresa MEGASUPPLY DEL ECUADOR S.A. La versión original de la ficha técnica se puede acceder a través de: www.megasupplyecuador.com
Litopenaeus vannamei de los principales países productores de camarones
Los camarones muestreados de Ecuador probablemente tienen un perfil de elementos único en comparación con los camarones del Sudeste Asiático
La importancia de conocer la procedencia de los alimentos marinos ha llevado a los investigadores a explorar opciones innovadoras para mejorar la trazabilidad de estos productos, cuyos hallazgos aportan evidencias sobre la posibilidad de utilizar patrones distintivos únicos como una herramienta capaz de diferenciar el origen geográfico de los camarones de los principales países exportadores en el mundo.
 Por: Redacción de PAM*
Por: Redacción de PAM*
La mayor parte de la producción del camarón patiblanco Litopenaeus vannamei, se concentra en unos pocos países de Latinoamérica y del sudeste asiático que incluyen a
Ecuador, Tailandia, Vietnam, India, Indonesia y China. Si bien China lidera la producción mundial de esta especie de camarón, la mayor parte de su producción es para consumo interno, mientras que el
resto de los países mencionados destinan su producción al comercio internacional, siendo sus principales destinos Japón, Estados Unidos, Unión Europea, Corea y China (ONU, 2020).
Evaluación de la variabilidad y poder discriminatorio de los patrones distintivos únicos en camarones patiblancos
A pesar de la importancia de los alimentos del mar en la cadena de suministro para consumo humano, los Estados Unidos y la Unión Europea han documentado fraude en el etiquetado de estos productos. El etiquetado incorrecto se utiliza para manipular los precios, mejorar la comercialización, reemplazar las especies cultivadas con especies silvestres y cumplir la cuota requerida por los procesadores. Las declaraciones como, por ejemplo, las relacionadas con la sostenibilidad en las certificaciones, también se basan en la trazabilidad precisa del origen de los productos. Se han explora-

do varios métodos analíticos como herramientas de trazabilidad, incluyendo análisis de ácidos grasos, análisis de isótopos estables y perfil de ADN. Además, se han implementado nuevas tecnologías como la cadena de bloques y la identificación por radio frecuencia en las cadenas de suministros de productos del mar.
Otra herramienta identificada para mejorar la trazabilidad de los productos del mar es el patrón distintivo único, la cual también es prometedora como opción para discriminar los orígenes geográficos de los camarones. Aunque Ecuador es un importante productor de cama-

rón, hasta la fecha, solo ha realizado un estudio de patrón distintivo único como herramienta de trazabilidad, por lo que el potencial para diferenciar camarones de Ecuador y países individuales en el sudeste asiático utilizando este método es relativamente inexplorado. El objetivo de este estudio fue comprender el potencial del patrón distintivo único para diferenciar entre los principales países exportadores de camarón en el sudeste asiático y Ecuador.
Se seleccionaron camarones patiblancos de cinco países: Ecuador, India, Indonesia, Vietnam y Tailandia. Los sitios de recolección se eligieron con el apoyo de los investigadores (expertos de la industria acuícola en sus respectivos países) con la finalidad de seleccionar áreas representativas de la producción de camarones (Figura 1). En todas las granjas escogidas se emplean métodos de producción similares (operaciones semintensivas o intensivas), todos los camarones fueron alimentados con dietas granuladas. Las muestras se tomaron siguiendo el mismo procedimiento (Li et al., 2017). Los camarones se llevaron a un laboratorio en el país de muestreo, se descabezaron y pelaron. Posteriormente, las colas peladas se secaron en deshidratadores de alimentos comerciales a 50◦C hasta que el tejido alcanzó una masa constante. Una vez secas, las muestras se almacenaron congeladas hasta su envío para el análisis de patrones distintivos únicos.
Se utilizó un ICP-MS NexION 350 d (PerkinElmer Inc., Waltham MA, EE.UU.) para realizar el análisis de patrones, empleándose tanto el modo de discriminación estándar como el cinético. Se siguieron varios pasos para asegurar la consistencia entre series y dentro de ellas. La media y la desviación estándar de cada elemento se reportan por país de origen. Se realizó un análisis de tipo MANOVA (ANOVA modificado) (MATS, por sus siglas en inglés) unidireccional aplicando la prueba estadística descrita en Friedrich y Pauly (2018), que es estadísticamente robusta a la heteroscedasticidad, no depende de la normalidad multivariada y puede utilizarse con datos de alta dimensión.
Con la prueba de tipo MANOVA se encontró una diferencia significativa entre los patrones distintivos de los cinco países del estudio (MATS = 947.047, p < 0.001). En la Tabla 1 se presenta un resumen de las concentraciones de elementos encontradas en el tejido muscular de la cola del camarón y las pruebas estadísticas univariadas. En general, se detectaron diferencias significativas en 28 de los 33 elementos reportados. En 15 de los 28 elementos donde se observaron diferencias estadísticas, y en 17 elementos en general, los camarones de Ecuador tuvieron las concentraciones más altas en promedio. Vietnam y Tailandia tendieron a pertenecer a las mismas agrupaciones post hoc, encontrándose en el mismo grupo en 25 de los 28 elementos donde se detectaron diferencias significativas.

En general, el modelo de clasificación de bosque aleatorio obtu-
vo una precisión validada de 91% (Tabla 2). Los resultados más precisos fueron los de Ecuador (97%), mientras que los menos precisos fueron los de Tailandia (80%).

El elemento más importante de la clasificación fue el Cs, seguido de As y Se (Figura 2). Los menos importantes fueron el Cr y Pb.
El análisis discriminante canónico (CDA, por sus siglas en inglés) redujo el grupo de datos a cuatro variables canónicas. En las dos primeras dimensiones, que representan ~78% de la variación total, Ecuador

El patrón distintivo único se ha identificado como una herramienta para aumentar la trazabilidad en los productos del mar y ha demostrado ser prometedor para distinguir el origen geográfico de los camarones.
e India se separan de los tres países del Sudeste Asiático (Figura 3a).
Los camarones indios se separan de los camarones de los otros países a lo largo de la segunda variable canónica, mientras que Ecuador se separa a lo largo de la primera variable canónica. Los elementos con fuertes cargas factoriales en la primera variable canónica incluyen Al, As, Sr, mientras que los elementos altamente correlacionados con la variable canónica 2 son Al, Co y V (Tabla 3). Aunque Tailandia, Vietnam e Indonesia se superponen en las dos primeras dimensiones del CDA, Indonesia se separa de Tailandia y Vietnam en la primera y tercera dimensión, que está altamente asociada con los elementos Ca, Cs y V (Figura 3b).
Se realizó un análisis discriminante con un modelo de bosque aleatorio con camarones patiblancos de cultivo de los principales países exportadores, las concentraciones de los elementos presentes en el tejido muscular del camarón. La base para elaborar el patrón distintivo es que existen patrones de heterogeneidad en las muestras de diferentes agrupaciones predefinidas (por ejemplo, especie, métodos de producción, origen geográfico). En el grupo de datos del estudio, 28 de los 33 ele-
mentos reportados mostraron diferencias estadísticas entre agrupaciones. En general, las muestras de Ecuador estaban más mineralizadas que las de otros países, lo cual puede deberse a que la corriente de agua dulce proveniente de las montañas andinas de Ecuador es más rica en minerales que las regiones de tierras bajas del sudeste asiático. En general, la precisión del procedimiento de discriminación con 328 muestras fue de 91%. Esto se
compara favorablemente con otros estudios realizados con respecto a la identificación de la ubicación geográfica en camarones cultivados. Li et al. (2017) cubrió un subconjunto de las áreas geográficas de este estudio y tuvo una precisión general del 97%, pero con menos muestras y un alcance más limitado. Gopi et al. (2019) pudieron identificar al camarón tigre negro Penaeus monodon en regiones de Australia y el sudeste asiático con una preci-


El etiquetado incorrecto se utiliza para manipular los precios, mejorar la comercialización, remplazar las especies cultivadas con especies silvestres, y cumplir la cuota requerida por los procesadores.
sión del 98%; sin embargo, en ese estudio hubo mezcla de captura silvestre y camarones cultivados en el muestreo.
La trazabilidad de los productos del mar es una preocupación creciente para los productores, minoristas y consumidores. Los consumidores son cada vez más conscientes del impacto de su poder adquisitivo y, por lo tanto, están dispuestos a comprar productos que se perciben como “sostenibles”, incluso si tienen un precio más alto (Roheim et al., 2011). En muchos casos, los minoristas utilizan los esquemas de certificación como un sustituto de la sostenibilidad y la formulación de declaraciones, aunque los excluye del proceso de validación de las declaraciones sobre el producto, les permite proyectar una conciencia ambiental.

En acuicultura, tanto el “Aquaculture Stewardship Council” como los estándares para camarones de “Global Aquaculture Alliance Best Aquaculture Practice” tienen requisitos de cadena de custodia y trazabilidad. Los resultados presentados aportan evidencia sobre la posibilidad de utilizar el patrón distintivo como una herramienta de trazabilidad. Las muestras de camarones de cinco países, líde-
res mundiales en exportación de camarones fueron discriminadas con éxito según el país de origen. También se trata de una muestra considerablemente mayor que la de otros estudios similares y no hay confusión en los datos entre especies cultivadas y silvestres. Además, los hallazgos demuestran que los camarones muestreados de Ecuador probablemente tienen un patrón distintivo único en comparación con los camarones del sudeste asiático, lo cual ha sido el foco de los esfuerzos previos en la elaboración del patrón distintivo del camarón.
En general, el estudio demuestra que con un muestreo más robusto (muestro de más lugares y más muestras de cada granja), se podría generar una base de datos para discriminar los orígenes geográficos de los camarones de los principales países exportadores de camarones del mundo. Los investigadores buscaron clasificar el camarón por país de origen en cinco de los mayores exportadores de camarón del mundo. El potencial de la elaboración de patrones distintiivos como herramienta de trazabilidad en aplicaciones prácticas es aún un área relativamente inexplorada. En general, con una preci-
sión de 91% utilizando un modelo de clasificación de bosques aleatorios, los resultados muestran que los camarones criados en granjas pueden servir como base de datos para posibles aplicaciones de trazabilidad, ya sea para minoristas privados o agencias gubernamentales.
Esta es una versión resumida desarrollada por el equipo editorial de Panorama Acuícola Magazine del artículo “ASSESSINGTHEVARIABILITY AND DISCRIMINATORY POWER OF ELEMENTAL FINGERPRINTS INWHITELEG SHRIMP LITOPENAEUS VANNAMEI FROM MAJOR SHRIMP PRODUCTION COUNTRIES” escrito por ROBERTP.DAVISyCLAUDE E.BOYD-AuburnUniversity;RAVIBABU GODUMALAyAVANIGADDAB.CH MOHAN-SeafoodSolutions;ARTURO GONZALEZ-WorldWildlifeFund, Guayaquil,Ecuador;NGUYENPHUONG DUY-WorldWildlifeFundforNature, Hanoi,Viet Nam;PANDE GDE SASMITA JUdayanaUniversity;NURAHYANI-World WildlifeFund,Jakarta,Indonesia;OLGA SHATOVAyJOSHUAWAKEFIELD-Oritain GlobalLimited;BLAKEHARRISyAARONA. MCNEVIN-WorldWildlifeFund;D.ALLEN DAVIS-AuburnUniversity.La versión original, incluyendo tablas y figuras, fue publicada en OCTUBRE de 2021 en FOOD CONTROL. Se puede acceder a la versión completa a través de https://doi. org/10.1016/j.foodcont.2021.108589

El internet de las cosas ha permitido la implementación de avances tecnológicos en áreas acuícolas en el mundo, abriendo oportunidades para insertar sistemas controlados de forma remota, los cuales pueden ser una herramienta poderosa de soporte al brindar nuevas soluciones con diferentes enfoques, en particular, en el monitoreo de los parámetros de calidad de agua en la producción del camarón en Ecuador.
Por: Redacción de PAM*.El agua es el medio natural de vida de los camarones, consecuentemente la calidad de esta es decisiva en su desarrollo, es decir, es el entorno donde esta especie crece y se reproduce, por tanto, es muy importante para quienes se dedican a la producción de camarones conocer la calidad del medio de vida que proporcionan a sus cultivos (Carchipulla Leal, 2018). La falta de automatización, control o mediciones erróneas de los parámetros del agua en las piscinas camaroneras afectan en gran medida la calidad del camarón. El mayor problema para los organismos acuáticos es obtener suficiente oxígeno, debido a su baja solubilidad en el agua (Zucchi, 2017), disminuyendo el crecimiento y desarrollo del camarón.
Ecuador es el principal exportador de camarón en Latinoamérica y forma parte de los más importantes a escala mundial, llegando a países como China (49%), Estados Unidos (20%), España (7%), Francia (5%) e Italia (4%), convirtiéndose en un rubro relevante en el producto interior bruto total del país. Sin embargo, la mayoría de las camaroneras de la región costera de Ecuador realizan la medición de los parámetros del agua en forma manual (Dupont, 2018), además de carecer de infraestructura que conste de un hardware/software de toma y monitoreo de estos en las piscinas

de los parámetros
de cría de camarón, generando un control poco eficiente y sin margen de respuesta para prevenir algún problema que se presente, debido a la lectura tardía de estos parámetros.
El internet de las cosas (IoT, por sus siglas en inglés) es la red de dispositivos que se encuentran interconectados entre sí, o con internet, la cual permite que los mismos compartan información, tanto captada por sensores o generada por actuadores, además de su manipulación remota. El IoT ha permitido la implementación de avances tecnológicos en áreas acuícolas en el mundo, abriendo oportunidades para insertar sistemas controlados de forma remota. Los sistemas de monitoreo integrados en los procesos acuícolas pueden identificar cambios en comportamientos de crecimiento y parámetros ambientales, influyendo directamente en la producción acuícola. En este sentido, el IoT puede ser una herramienta de soporte al brindar nuevas soluciones con diferentes enfoques, en especial, en el monitoreo de los parámetros de calidad de agua en acuicultura.
En este artículo, se presenta el resumen de una investigación cuyo objetivo fue desarrollar un prototipo basado en una arquitectura IoT, el cual permite la monitorización y control de la calidad del agua e identificar los parámetros más relevantes que influyen positivamente en la producción del camarón en las empresas acuícolas de Ecuador.
Partiendo de una investigación cualitativa a través de la consulta de opiniones de expertos en el área de biología e ingeniería en ramas de la tecnología asociada al internet de las cosas, se obtuvo información
detallada acerca del objeto de estudio y, a su vez, conclusiones que se complementaron con una revisión bibliográfica de trabajos previos.
En cuanto a la arquitectura IoT del prototipo de medición de calidad del agua, en la Figura 1 se muestran los sensores alimentados por paneles solares que miden los parámetros de la calidad del agua (pH, salinidad, oxígeno disuelto, turbidez) y establecen una comunicación con el módulo wifi ESP8266 de internet, permitiendo enviar los datos a la plataforma Firebase En caso que los parámetros estén fuera de los límites establecidos, se envían correos electrónicos de alarma que, posteriormente, son consumidos mediante microservicios por el software de monitoreo, el cual fue diseñado a partir de un modelo vista controlador.
Para el desarrollo del software, se utilizaron las siguientes tecnologías:
9 PHP: Hypertext Preprocessor language open source utilizado para el desarrollo de páginas de web con HTML incrustado, ejecutado desde el servidor.
9 JavaScript: lenguaje de programación ligero, dinámico con soporte para POO (Programación orientada a objetos) ejecutado just-in-time.
9 Node Js: entorno de código abierto y gratuito, donde se da la ejecución para lenguajes de programación JavaScript. Puede utilizarse como servidor contando con módulos optimizados para networking y diferentes tipos de protocolos de internet.
9 Angular 12: es un framework para el desarrollo de páginas web de código abierto.
9 Firebase: plataforma ubicada en la nube que permite el almacenamiento de información.

Para el diseño del hardware, se emplearon los siguientes sensores:
9 Arduino Leonardo: microcontrolador que contiene 14 pines digitales y 6 entradas analógicas con un oscilador de 16MHZ, alimentación externa de 6 V a 20 V y un 1 Kb de memoria programable permite conectar módulos wifi.
9 Módulo wifi ESP8266: componente electrónico de hardware libre utilizado para el acceso a wifi que permite la conexión a internet en todo momento, mayormente usado en proyectos IoT.
9 Sensor de temperatura para líquidos DS18B20: sensor digital para la medición de temperatura en líquidos, ambientes húmedos y bajo los líquidos; requiere solo una línea de datos para la comunicación con el microcontrolador.
9 Sensor de TDS: sensor que mide los miligramos de sólidos solubles en un litro de agua, sirviendo como referencia para los recambios de agua. Con entradas de voltaje desde los 3.3 V a 5.5 V.
9 Sensor de pH líquidos PH0-14: sensor de detección de pH, el cual mide la composición de alcalinidad del agua con lecturas instantáneas. Entrada de voltaje de 5 V.
9 Sensor de turbidez SEN0189: detecta la calidad del agua mediante su nivel de turbidez, no es a prueba de agua, opera con 5 V y un rango de temperaturas entre 5°C~90°C.
El análisis de las entrevistas a expertos permitió la identificación de los parámetros más relevantes para el análisis de la calidad
del agua, los cuales son: oxígeno disuelto, pH, temperatura, salinidad y turbidez. Complementando estos resultados con las opiniones de expertos en IoT, se diseñó la solución del sistema para su medición.

Para comprobar el funcionamiento del sistema, se realizaron pruebas en una piscina o estanque de la camaronera San Andrés Guayaquil – Ecuador, vía Durán Tambo, durante tres días por dos horas, utilizando una laptop Core i5, 8Gb de RAM, 256GB de disco HDD, empleada para la visualización gráfica de datos de los parámetros de la calidad del agua en tiempo real. Se pudo programar las horas de censo, guardando la información en la base de datos MySql, que posteriormente es consumida mediante un API para generar reportes históricos con base en filtros. El software cuenta con dos perfiles: administrador y obrero. El usuario administrador puede crear cuentas a los obreros, así como asignar las piscinas para su monitoreo y gestionar valores máximos y mínimos de los parámetros a monitorear. El perfil obrero solo puede generar reportes y visualizar los valores en las piscinas que le corresponden.

En Ecuador, la tecnología IoT no está siendo explotada como es debido. Tomando como referencia la investigación de Beltán & Mejía (2018), quienes crearon un dispositivo que mide en tiempo real parámetros de la calidad del agua (temperatura, pH y radiación ultravioleta) haciendo uso de la plataforma de software libre Thinger.io para la visualización de los datos, se compararon los resultados obtenidos con el presente prototipo, lo que permitió agregar más parámetros primordiales que contribuyen a la supervivencia y crecimiento en el cultivo del camarón, a saber: oxígeno disuelto, turbidez y salinidad, complementando el monitoreo de la calidad del agua en este cultivo.

En la actualidad, las camaroneras aún no optan por el uso de esta tecnología debido a su alto costo de adquisición. La solución del prototipo que se presenta incluye la medición de los parámetros con un software personalizable, amigable con el usuario y escalable, con el uso de las bases alojadas en la nube se puede incluir tecnologías como inteligencia artificial para la creación de modelos de predicción.
Se desarrolló un sistema de control y monitoreo de los parámetros de la calidad del agua de las piscinas de cultivo de camarones, con acceso remoto. El software permite al usuario monitorear el estado actual, visualizar el histórico y elaborar informes de los parámetros a través del tiempo, con el fin de analizar su comportamiento y evitar posibles problemas en el medio acuático de cultivo del camarón Litopenaeus vannamei Según investigaciones previas y juicios de expertos, se seleccionaron los parámetros para la medi-

ción de la calidad del agua considerados más importantes para el crecimiento, supervivencia y sobrevivencia del camarón. En el hardware se puede visualizar los datos en la pantalla LCD alimentada con energía solar, enviando datos bajo el protocolo HTTP en el módulo wifi NODE MCU V3; mientras que los obtenidos mediante sensores son enviados por internet hacia la base de datos en Firebase, la cual se actualiza cada 10 segundos.
Con la arquitectura IoT no es necesario instalar software para el uso del prototipo porque es centralizado y se accede a través de una infraestructura de red disponible. Los datos se almacenan en MySQL, una base de datos segura y estable, con capacidad de almacenamiento de 16 TB, lo que permite resguardar grandes cantidades de datos para el análisis del proceso de medición del agua. El software es capaz de medir en tiempo real oxígeno disuelto, temperatura, salinidad, pH y turbidez. Mediante la integración de la tecnología IoT, se obtuvo un prototipo, el cual demostró ser efectivo para emplearse donde sea
necesario mantener un control y monitoreo preciso de las condiciones ambientales.
Finalmente, se logró un producto de calidad que permite a los acuicultores, parametristas y dueños de camaroneras de la región costa del Ecuador tener acceso a los datos de parámetros de agua en forma remota, adquirir mayor conocimiento y, en base a ello, tomar acciones oportunas y evitar pérdidas económicas.
Esta es una versión resumida desarrollada por el equipo editorial de Panorama Acuícola Magazine del artículo “IMPACTO DEL INTERNET DE LAS COSAS EN EL CONTROL Y MONITOREO DELOSPARÁMETROSDELAGUAPARALA PRODUCCIÓNDELCAMARÓNDEECUADOR” escritoporESPINOZACRUZ,P.J.;LUCASAGUIRRE, Y.M.;RAMOSMOSQUERA,B.yALARCÓN SALVATIERRA,J.A.-UniversidaddeGuayaquil, Ecuador.La versión original, incluyendo tablas y figuras, fue publicada en ABRIL de 2022 en PRO SCIENCES:REVISTADEPRODUCCIÓN,CIENCIAS EINVESTIGACIÓN.Se puede acceder a la versión completa a través de https://doi.org/10.29018/ issn.2588-1000vol6iss43.2022pp83-92
La generación de conocimiento en alimentación y el uso de la tecnología para optimizarlo son de suma importancia en la industria acuícola. Para lograr una visión adecuada al respecto, se aplicaron herramientas de minería de datos con el fin de estudiar los beneficios de los aglutinantes en las dietas de camarones juveniles Litopenaeusvannamei y descubrir tendencias, patrones y situaciones anómalas en las secuencias de datos.
Por: Redacción de PAM*Ecuador es considerado uno de los países más importantes en la producción de camarón. Su alta producción se debe a dos factores: 1) esta ha sido tradicionalmente semiintensiva, utilizando intercambio de alimentos y agua, pero sin aireación, y 2) hay mucha tierra deshabitada adecuada para grandes estanques y
granjas. Sin embargo, existe un interés creciente en expandir la acuicultura en este país empleando especies y tecnologías alternativas.
Con el fin de diversificar la producción acuícola en Ecuador, se han llevado a cabo diversos proyectos para la producción de camarón. En 2002, debido al síndrome de la mancha blanca, se desarrollaron
métodos alternativos de producción, como el cultivo en estanques cubiertos que permite un menor intercambio de agua y un nivel de temperatura más constante, y el sistema llamado “onshore” que consiste en cultivar camarones a salinidades muy bajas utilizando agua de pozos y ríos en áreas agrícolas de las provincias de Manabí y Guayas.

La alimentación suplementaria está asociada con estas actividades, lo que influye en el costo de producción de camarón.
La estrategia y la optimización de la alimentación son aspectos de importancia en acuicultura que implican la formulación de diferentes dietas (pellets o gránulos). El contenido de nutrientes presente en los gránulos influirá en el crecimiento y la supervivencia de los camarones, y en los productos de desecho excretados. En la formulación de gránulos, es necesario mantener el valor de los nutrientes dietéticos utilizando aglutinantes, aunque no es común su uso como atrayentes en los alimentos para camarones. Para lograr una visión adecuada al respecto, se aplicaron herramientas de minería de datos, como el algoritmo de agrupamiento K-means (K-Means Clustering Algorithm) y PCA Biplot, con el fin de estudiar los beneficios de los aglutinantes en las dietas de camarones y descubrir tendencias, patrones y situaciones anómalas en las secuencias de datos. El objetivo principal de este estudio fue utilizar técnicas de minería de datos, como el algoritmo de agrupamiento K-Means y PCA Biplot, identificando el rendimiento en el crecimiento y la composición nutricional de camarones juveniles Litopenaeus vannamei después de ser alimentados con dietas que incluyen aglutinantes de acuicultura con sardina.
El experimento se realizó en la Camaronera “La Chorrera”. Se distribuyeron aleatoriamente diez camarones juveniles L. vannamei (0.70 g) por tanque (180 tanques de 20 L de capacidad). Las dos mezclas utilizadas se prepararon con la siguiente composición: Mezcla 1 (M1) de granulados mezclados con aglutinante (hidrolizados de subproductos de sardina al 20%) y Mezcla 2 (M2) de granulados mezclados con aglutinante (hidrolizados de subproductos de sardina al 30%).
Durante las siete semanas consecutivas de la prueba, los camarones juveniles fueron alimentados cuatro veces al día. En los comederos se agregaron 200 g de mezcla (M1) o 200 g de mezcla (M2). Los experimentos se realizaron por triplicado.
Se contaron, pesaron y midieron tres camarones de cada tanque (después de siete semanas del
ensayo) con la finalidad de determinar: rendimiento de crecimiento, incluida la ganancia de peso (WG %, por sus siglas en inglés), tasa de crecimiento específico (SGR %), eficiencia alimenticia (FE %), índice de eficiencia proteica (PER) y porcentaje de supervivencia (S %). Se realizó un análisis proximal de las muestras según el criterio de la Asociación de Químicos Analíticos Oficiales (AOAC).
Minería de datos para el rendimiento de crecimiento de camarones juveniles
En la Figura 1 se aprecia el uso del método de algoritmo de agrupamiento de 90 objetos con cinco variables cada uno, utilizando el software RStudio. El gráfico (a) presenta el uso de tres agrupamientos o clusters para rendimiento de crecimiento de camarones juveniles L. vannamei alimentados con la mezcla M1, mientras que en el gráfico (b) de los alimentados con la mezcla M2, ambos después de siete semanas. Los resultados muestran una curva normal de distribución de 90 puntos de datos alrededor de tres agrupamientos en cada gráfico.
El tamaño de cada grupo está relacionado con el número de puntos de datos, en el gráfico (a): el tamaño del Grupo 1 (color rojo) es 28, el tamaño del Grupo 2 (color negro) es 32 y el tamaño del Grupo 3 (color verde) es 30. Los camarones juveniles L. vannamei alimentados con la mezcla M1 perteneciente al Grupo 2 mostraron los valores más altos de rendimiento de crecimiento. Por otra parte, en el gráfico (b): el tamaño del Grupo 1 (color negro) es 30, el tamaño del Grupo 2 (color verde) es 29 y el tamaño del Grupo 3 (color rojo) es 31. Los camarones juveniles L. vannamei alimentados con la mezcla M2 perteneciente al Grupo 3 presentaron los mayores valores de rendimientos de crecimiento. Dado que los puntos de datos se distribuyen normalmente, los grupos varían en tamaño con puntos de datos máximos y puntos de datos mínimos.
La Figura 2 muestra el gráfico factorial del plano 1–2 (PCA-Biplot); el gráfico (a) presenta la inercia acumulada hasta 49.1% mientras que el gráfico (b) presenta la inercia acumulada hasta 47%. Los agrupa-

mientos se calcularon utilizando las coordenadas Biplot y su descripción se basa en cinco variables. En el gráfico (a) se observan diferencias importantes. El Grupo 1 (color azul) indica la presencia de 25 camarones juveniles L. vannamei alimentados con la mezcla M1 con mayor relación de eficiencia alimenticia y ganancia de peso, mientras que el Grupo 2 (color verde) indica la presencia de 40 camarones juveniles L vannamei alimentados con la mezcla M1 con mayor relación para tasa de crecimiento específico e índice de eficiencia proteica y el Grupo 3 (color rojo) indica la presencia de 25 juveniles L. vannamei alimentados con la mezcla M1 con mayor relación de supervivencia específica.
En el gráfico (b) también se observaron diferencias entre los agrupamientos. El Grupo 1 (color rojo) indica la presencia de 19 camarones juveniles L. vannamei alimentados con la mezcla M2 con
mayor relación de eficiencia alimenticia, mientras que el Grupo 2 (color azul) indica la presencia de 30 camarones juveniles L. vannamei alimentados con la mezcla M2 con mayor relación para todos los parámetros y el Grupo 3 (color verde) indica la presencia de 41 camarones juveniles L vannamei alimentados con la mezcla M2 con mayor relación para la tasa de crecimiento específico, ganancia de peso e índice de eficiencia proteica. El uso de aglutinantes con sardina en las dietas puede mejorar el rendimiento de crecimiento debido al incremento de alimentación y menor desperdicio de alimentos.
Minería de datos para la composición nutricional de camarones juveniles
La Figura 3 presenta la aplicación del método de algoritmo de agrupamiento K-means para 90 objetos
de cinco variables cada uno, utilizando el software RStudio. En el gráfico (a) se presenta el uso de tres agrupamientos para la composición nutricional de camarones juveniles L. vannamei alimentados con la mezcla M1, mientras que en el gráfico (b) de los alimentados con la mezcla M2. En los resultados se aprecia la distribución normal de 90 puntos de datos alrededor de tres agrupaciones en cada gráfico. El tamaño de cada agrupamiento está en relación con la cantidad de puntos de datos. Gráfico (a): el tamaño del Grupo 1 (color rojo) es 31, el tamaño del grupo 2 (color negro) es 30 y el tamaño del Grupo 3 (color verde) es 29. Los camarones juveniles L. vannamei alimentados con la mezcla M1 pertenecientes al Grupo 1 mostraron los valores más altos de parámetros nutricionales. Mientras, que en el gráfico (b): el tamaño del Grupo 1 (color negro) es 30, el

tamaño del Grupo 2 (color verde) es 28, y el tamaño del Grupo 3 (color rojo) es 32. Los camarones juveniles L vannamei alimentados con la mezcla M2 pertenecientes al Grupo 3 presentaron los valores más altos de parámetros nutricionales. Dado que los puntos de datos se distribuyen normalmente, los agrupamientos varían en tamaño con puntos de datos máximos y puntos de datos mínimos.
La Figura 4 presenta el gráfico factorial del plano 1-2 (PCA-Biplot); el gráfico (a) muestra la inercia acumulada hasta 56%, mientras que el gráfico (b) presenta la inercia acumulada hasta 54.1%. Los agrupamientos se calcularon usando las coordenadas Biplot y su descripción general se basa en cuatro variables.

Se observaron en el gráfico (a) diferencias importantes entre los agrupamientos. El Grupo 1 (color verde) indica la presencia de 35

Las herramientas de minería de datos, como el algoritmo de agrupamiento K-means y PCA Biplot, permiten estudiar los beneficios de los aglutinantes en las dietas de camarones y descubrir tendencias, patrones y situaciones anómalas en las secuencias de datos.

camarones juveniles L. vannamei alimentados con la mezcla M1 con mayor relación de humedad y lípido bruto, mientras que el Grupo 2 (color rojo) indica la presencia de 36 camarones juveniles L. vannamei alimentados con mezcla M1 con mayor relación para cenizas y el Grupo 3 (color azul) indica la presencia de 19 camarones juveniles L. vannamei alimentados con mezcla M1 con mayor relación para la proteína bruta. En el gráfico (b) también hay diferencias entre los agrupamientos. El Grupo 1 (color verde) indica la presencia de 23 camarones juveniles L. vannamei alimentados con mezcla M2 con mayor relación para proteína bruta y lípido bruto, mientras que el Grupo 2 (color azul) indica la presencia de 30 camarones juveniles L. vannamei alimentados con mezcla M2 con mayor relación para cenizas, y el Grupo 3 (color rojo) indica la presencia de 37 camarones juveniles L. vannamei alimentados con mezcla M2 con mayor relación para cenizas y humedad. Una buena fuente de proteína para nutrición animal es aquella con un contenido balanceado de aminoácidos. Los valores más altos de composición nutricional
en los cuerpos de los camarones obtenidos con estas dietas pueden ayudar a mejorar la acuicultura en camaroneras de pequeña escala.
Los resultados indican que la minería de datos puede describir una buena visualización de las condiciones de alimentación con el objetivo de obtener parámetros comerciales específicos de los camarones juveniles L. vannamei como el rendimiento de crecimiento o la composición nutricional.
Las herramientas de minería de datos como PCA Biplot y el algoritmo K-means mostraron que los camarones juveniles Litopenaeus vannamei alimentados con la mezcla M2 presentaron la relación más alta con tasa de crecimiento específico, ganancia de peso, relación de eficiencia de proteína, proteína bruta y lípido bruto.
El uso de técnicas de minería de datos sobre parámetros comerciales de camarones juveniles Litopenaeus vannamei permite determinar las condiciones de alimentación para obtener los valores más altos en parámetros específicos como rendimiento de crecimiento o compo-
sición nutricional. El uso de aglutinante con sardina permite un mayor consumo de gránulos; resultado similar al obtenido en otros estudios que utilizaron una mezcla de gránulos con aglutinante de atún que condujo a un mayor consumo en comparación con solo gránulos.
Esta es una versión resumida desarrollada por el equipo editorial de Panorama Acuícola Magazine del artículo “DATAMININGTECHNIQUES:NEW METHOD TO IDENTIFY THE EFFECTS OF AQUACULTUREBINDERWITHSARDINE ON DIETS OF JUVENILE LITOPENAEUS” escrito por FABRICIOGUEVARA-VIEJÓUniversidadEstataldeMilagro;JUAN DIEGOVALENZUELA-COBOS - Universidad EstataldeMilagro,Ecuahidrolizados Industry;ANAGRIJALVA-ENDARAUniversityofSalamanca;PURIFICACIÓN VICENTE-GALINDO Universidad Estatal deMilagro,UniversityofSalamanca, Institute for Biomedical Research of SalamancayPURIFICACIÓNGALINDOVILLARDÓN-UniversidadEstatalde Milagro. La versión original, incluyendo tablas y figuras, fue publicada en APRIL de 2022 en SUSTAINABILITY. Se puede acceder a la versión completa a través de 03. https://doi.org/10.3390/su14074203
La oxitetraciclina es uno de los antibióticos más utilizados en el sector acuícola; sin embargo, no se metaboliza completamente durante su administración terapéutica, resultando en presencia de residuos que incrementan la resistencia antimicrobiana en las bacterias patógenas, por lo que es relevante analizar el efecto de la fotolisis y el pH en su degradación en estanques de cultivo de camarón Penaeus vannamei.
Por: Redacción de PAM*.
El consumo y producción de alimentos provenientes del mar se ha incrementado debido al crecimiento de la población mundial durante los últimos años. Sin embargo, el sector acuícola no está exento de la aparición de enfermedades. Una de las alternativas para su control en el cultivo de peces y crustáceos ha sido el uso de antibióticos. En México, los antibióticos como la oxitetraciclina (OTC), enrofloxacina y florfenicol se emplean en la industria camaronícola para controlar las infecciones bacterianas que se presentan durante los ciclos de producción.
La OTC es uno de los antibióticos más usados en el sector acuícola por poseer actividad bactericida y ser un fármaco de bajo costo. No se metaboliza completamente durante su administración terapéutica, excretándose de forma inalterada al medio ambiente y en
el agua, siendo las características fisicoquímicas del fármaco y del medio receptor importantes en su distribución, transporte y acumulación en el agua y el sedimento. Posee poca estabilidad en condiciones ambientales abióticas como son el pH y la exposición a la luz, siendo la fotolisis el principal mecanismo de su degradación. El uso de la luz solar como factor de degradación de la OTC ha sido una alternativa efectiva y de bajo costo. Sin embargo, la cinética de degradación puede ser dependiente de la composición iónica del agua marina y de los compuestos orgánicos presentes.
Una de las principales causas de residuos de OTC acumulados en los sedimentos de los estanques acuícolas es el alimento adicionado con este antibiótico que no es ingerido por los organismos. La permanencia de los residuos de antibióticos en los sistemas de cultivo acuícola,

incrementa la resistencia antimicrobiana en las bacterias patógenas, ocasionando cuantiosas pérdidas. En este artículo se presenta una investigación cuyo objetivo fue determinar el efecto de la fotolisis y el pH en la degradación de la OTC en solución y contenida en el alimento para camarón, en muestras de sedimento y agua marina, para conocer el residual del antibiótico en estanques de cultivo de camarón Penaeus vannamei.
Se realizó la toma de muestras de sedimento y agua de mar en una granja de cultivo de camarón P. vannamei ubicada en Bahía de Kino, Sonora, la cual fue seleccionada debido a la previa confirmación de que, por política de la empresa, desde hace 10 años no se aplican tratamientos con antibióticos como parte del proceso de cultivo del camarón.
Tanto las muestras de agua del mar como de sedimento, se tomaron de cuatro estanques de la granja seleccionados al azar, colectándolas en seis diferentes puntos de cada estanque. En cada muestreo se tomaron 20 L de agua de mar y se colocaron en recipientes de plástico debidamente identificados. En el caso del sedimento, se tomaron muestras de 1 kg, empleando para su recolección una draga metálica introducida en el estanque a 20 cm de profundidad. En el laboratorio, para el agua del mar, el volumen total recolectado en los estanques se mezcló en un solo recipiente y se homogeneizó. En el caso del sedimento, todas las muestras colectadas se vaciaron también en un recipiente y se homogeneizaron.
Se confirmó la ausencia de la OTC en las muestras de sedimento y del agua del mar, para posteriormente preparar una mezcla homogénea de ambas, en una proporción 2:98 (p/v), de la que se tomaron las submuestras para la realización de los ensayos. Se hicieron mediciones de pH, salinidad, oxígeno disuelto y temperatura. La determinación de la OTC en el sedimento y agua marina se llevó a cabo mediante un método de cromatografía de líquidos de alta resolución (HPLC).
Para evaluar la degradación de la OTC en las muestras de sedimento y agua marina por efecto del pH y la exposición a la luz, se realizó un ensayo bajo condiciones controladas en el Laboratorio de Análisis Biológicos del CIAD, por un período de 40 días, siguiendo el protocolo metodológico publicado por Lai & Lin (2009).
Parámetros fisicoquímicos en la muestra de sedimento y agua marina
La evaluación de los parámetros fisicoquímicos como: pH, salinidad, oxígeno disuelto y temperatura, que presentaron los microambientes dentro de los frascos con las muestras de sedimento y agua marina, mostró valores que se mantuvieron conforme a los óptimos en los sistemas de cultivo de camarón según lo reportado por Li et al. (2008) y Venkateswara-Rao (2009) (Tabla 1)

El resultado obtenido en el análisis de oxitetraciclina en el alimento

comercial para camarón fue de 3,256.51 ± 38.97 μgg-1 para el alimento medicado (adicionado con OTC), y se confirmó la ausencia del antibiótico en el alimento sin medicar (sin adición de OTC). Con base en la concentración obtenida de OTC en el alimento, se hicieron los cálculos para tener una concentración de 10 μgmL-1 en las muestras de sedimento y agua marina utilizadas en los ensayos.
Estandarización del método cromatográfico para determinar oxitetraciclina y aseguramiento de la calidad de los datos Antes de utilizar para el ensayo las muestras independientes de sedimento y agua marina colectadas en la granja acuícola, se analizaron para confirmar la ausencia de la OTC mediante cromatografía de líquidos de alta resolución. La validación del
método analítico empleado para la determinación de la OTC en las muestras de sedimento y agua marina arrojó buenos resultados en los parámetros obtenidos. El método implementado demostró ser simple, rápido, económico y confiable. Los resultados obtenidos en los parámetros de validación aseguran la calidad de los datos generados.
Degradación del estándar de la oxitetraciclina en las muestras de sedimento y agua marina En las muestras de sedimento y agua marina, analíticamente la OTC
La oxitetraciclina (OTC) es uno de los antibióticos más utilizados en el sector acuícola por poseer actividad bactericida y ser un fármaco de bajo costo.
mostró un tiempo de retención de 8.25 ± 0.02 min, observándose en el cromatograma un pico con buena resolución, sin interferencia de otros compuestos, lo que indica una adecuada especificidad o selectividad del método. La Figura 1 presenta cromatogramas típicos obtenidos de muestras de sedimento y agua

marina con OTC y un estándar de referencia de la OTC a una concentración de 10 µgmL-1
Los resultados del experimento de degradación de la OTC sin exposición a la luz y a pH 7 y 8, mostraron que para el estándar de OTC contenido en las muestras de sedimento y agua marina, al día 20 del

ensayo, en los frascos protegidos de la luz a pH 7, se tuvo una degradación del antibiótico de 75.16% y para el pH 8 fue de 69.65%. Hubo un incremento en la degradación de la OTC con el tiempo, detectándose a los 40 días del ensayo una concentración del antibiótico de 0.86 ± 0.04 µgmL-1, lo que representó una degradación del 88.33% con respecto al valor inicial (7.37 ± 0.46 µgmL-1) en los frascos con pH 7 y una concentración de 0.71 ± 0.23 µgmL-1 en los frascos con pH 8, donde la concentración inicial fue de 7.81 ± 0.14 µgmL-1, lo que indica una degradación del 90.9% (Figura 2). Para el caso de las muestras de sedimento y agua marina con estándar de OTC a pH 7 y 8, y expuestas a la luz, no se detectó el antibiótico al finalizar el ensayo (40 días), para ambos valores de pH.
El análisis estadístico demostró que el efecto del pH en la degradación de la OTC en los sistemas con y sin exposición a la luz, y entre los distintos puntos de muestreo, no presentó diferencias significativas (p ≥ 0.05). Sin embargo, la interacción de los factores como la luz, el tipo


de OTC y el tiempo de evaluación, mostraron su efecto sobre la degradación del antibiótico (Tabla 2). La prueba estadística de Bonferroni demostró que existe diferencia significativa en la degradación de la OTC conforme al tiempo transcurrido y los diversos factores evaluados (p ≤ 0.05).

Los resultados obtenidos en las muestras de sedimento y agua marina adicionadas con el estándar de OTC, mantenidas a pH 7 y con exposición a la luz, mostraron un tiempo de vida media de degradación (t ½) de 44.37 ± 21.08 min, a diferencia de las muestras no expuestas a la luz donde fue de
117.44 ± 77.26 min. En los frascos mantenidos a pH 8 y expuestos a la luz, el t ½ de degradación de la OTC fue de 49.68 ± 15.0 min, y en los que se mantuvieron sin exposición a la luz se prolongó hasta 63.85 ± 18.98 min del ensayo, requiriéndose más tiempo para la degradación del antibiótico en el microambiente (Tabla 3).
La Figura 3 representa la degradación de la OTC en el alimento para camarón de la muestra de sedimento y agua marina. En los frascos expuestos a la luz no se detectó el antibiótico al final del experimento (40 días). El t ½ de la OTC en los frascos con pH 8 y exposición a la luz, se observó a los 32.89 ± 6.68 min y en los no expuestos, a los 60.11 ± 16.29 min (Tabla 3).

Se demuestra la capacidad del método de cromatografía de líqui-
Una de las principales causas de residuos de oxitetraciclina acumulados en los sedimentos de los estanques acuícolas es el alimento adicionado con este antibiótico que no es ingerido por los organismos.
La fotolisis e hidrólisis, son procesos que participan en la degradación de los antibióticos y son dependientes de la temperatura, el pH y la luz, como se comprueba en el estudio.
dos de alta resolución, para generar resultados directamente proporcionales a la concentración del analito de interés, como lo establece Andrade (2018). En la cuantificación de la OTC el tiempo de retención cromatográfica del antibiótico fue similar al reportado por Pro (2016), quien obtuvo un tiempo de retención de 7 min, utilizando cromatografía líquida de alta resolución.
La fotolisis e hidrólisis, son procesos que participan en la degradación de los antibióticos y son dependientes de la temperatura, el pH y la luz, como lo reportó Andrade (2018) y se comprueba en el estudio a través del efecto de factores como la luz y la forma como se encontraba la OTC usada (como estándar o incorporada en el alimento para camarón), influyendo directamente en la degradación del antibiótico (p ≤ 0.05).
Los resultados del tratamiento de adición de OTC como estándar sin exposición a la luz, mostraron
una degradación del antibiótico de 88.33% y 90.90% a condiciones de pH de 7 y 8 respectivamente, a los 40 días del ensayo. Mientras que, en el tratamiento con el estándar y exposición a la luz, la degradación fue del 100% para ambos valores de pH. En el tratamiento de adición de la OTC en el alimento para camarón con y sin exposición a la luz bajo condiciones de pH 7 y 8, la degradación fue del 100%, a los 40 días. Este hallazgo es favorable, ya que, en las granjas de cultivo de camarón, la administración de los antibióticos se lleva a cabo a través del alimento.
La presencia de residuos de antibióticos en los sedimentos es relevante porque muchos de estos compuestos han demostrado ser persistentes en el suelo, el sedimento y el agua, lo que representa riesgos ecológicos a largo plazo y, aunque se encuentren en concentraciones traza, la exposición crónica sobre la microbiota acuática puede provocar la generación de resistencia bacteriana.
Esta es una versión resumida desarrollada por el equipo editorial de Panorama Acuícola Magazine del artículo “EFECTO DE LA FOTOLISISY PH EN LA DEGRADACIÓN DE LA OXITETRACICLINA EN SEDIMENTO Y AGUA MARINA” escrito por KAREN GRISELDA SOTELOCORNEJO,ANGELICA ESPINOSA-PLASCENCIA -CentrodeInvestigaciónenAlimentación yDesarrollo,A.C.;SERGIOGÁMEZ-BAYARDO, ADOLFOPÉREZ-ÁLVAREZ,MARIBELJIMÉNEZEDEZA - Universidad Autónoma de Sinaloa; ALFONSOGARCÍA-GALAZ1AyMARÍADEL CARMEN BERMÚDEZ-ALMADA - Centro de InvestigaciónenAlimentaciónyDesarrollo,A.C. La versión original, incluyendo tablas y figuras, fue publicada en OCTUBRE de 2021 en TIP REVISTA ESPECIALIZADA EN CIENCIAS QUÍMICOBIOLÓGICAS. Se puede acceder a la versión completa a través de https://doi.org/10.22201/ fesz.23958723e.2021.369


Ciertas proliferaciones de dinoflagelados han mostrado ser causantes de mortalidades y disminución del crecimiento del camarón, por lo que es necesaria la evaluación de diferentes productos alternativos al sulfato de cobre y no contaminantes, para reducir la concentración de dinoflagelados en los estanques de cultivo de camarón.
Por: Redacción de PAM*En la industria acuícola, el camarón Litopenaeus vannamei es una de las especies de mayor cultivo a escala global. Debido a la naturaleza del ambiente en el que se desarrolla y sus condiciones particulares se enfrenta a varias limitantes, entre las que destacan la necesidad de llevar a cabo seguimientos sanitarios rigurosos para asegurar la calidad del agua como factor principal. Esto ha generado que los productores desarrollen, en finca de manera práctica y empírica (con base en prueba y error), protocolos de manejo tales como desinfección, floculación y biorremediación en la columna de agua, que los ayuden a controlar dichos parámetros sanitarios.
Hay que tomar en cuenta, sin embargo, que las condiciones del medio ambiente y de cultivo cambian de manera estacional en relación con los meses del año, localización geográfica y resistencia del camarón en cuanto a la línea genética, entre otros factores. Dentro de los problemas de calidad de agua a los cuales se enfrenta la camaronicultura, además de factores bióticos tales como las fluctuaciones de poblaciones bacterianas y presencia de patógenos importantes, también se presenta el exceso de concentraciones de microalgas tóxicas en sistemas de cultivo de camarón. En cultivos semintensivos existe una


fuerte correlación entre calidad y diversidad del fitoplancton con relación al desarrollo del camarón.
Los beneficios que estas especies aportan llevan a las camaroneras a la utilización de fertilizantes, con el fin de promover el crecimiento de ciertas especies caracterizadas como benéficas o deseables en un sistema de cultivo. En ocasiones, una adición desmedida de fertilizantes promueve el desarrollo de especies poco deseables, como los dinoflagelados, causando los llamados “blooms” de microalgas que ponen en riesgo la producción de la piscina camaronera. Los dinoflagelados son protistas con flagelos pertenecientes al grupo de fitoplancton. Junto con otro tipo de fitoplancton, estos ingresan a través de la entrada del agua e inmediatamente proliferan en abundancia al encontrarse con los nutrientes (nitrógeno y fósforo), y en las condiciones favorables.
En la mayoría de los casos las floraciones de dinoflagelados no representan ningún daño para los camarones. No obstante, ciertas proliferaciones han mostrado ser causantes de mortalidades y disminución del crecimiento del camarón. Steidinger et al. (1998) reportaron en Florida mortalidades en poblaciones silvestres de camarones Penaeidos que fueron asociadas a la especie de dinoflagelados Gymnodinium pulchellum Otro caso fue en Ecuador, donde se reportó la presencia de dinoflagelados tóxicos como Dynophisis caudata y G. catenatum (Reyes et al., 2001). El objetivo de esta inves-
tigación fue valorar la eficiencia de diferentes productos alternativos al sulfato de cobre y no contaminantes, para reducir la concentración de dinoflagelados en los estanques de cultivo de camarón Litopenaeus vannamei en Guayas, Ecuador.

Los ensayos se realizaron en dos temporadas, verano e invierno. Las muestras de agua tomadas en piscinas camaroneras ubicadas en la provincia del Guayas, con salinidades entre 20 - 25 ppt y temperaturas de 24 y 27°C en promedio, fueron distribuidas en tinas de 120 litros. En la Figura 1, se muestra el diagrama
de la secuencia de ejecución de los ensayos de los diferentes insumos para el control de dinoflagelados. Se llevaron a cabo un total de 3 ensayos con los diferentes insumos, por triplicado e incluyendo una muestra control sin adición de insumo (Tabla 1).


Caso 1. Ensayo en invierno con aireación
Los resultados de la aplicación de los diferentes insumos sobre la concentración de dinoflagelado se detallan en la Figura 2. En este ensayo, con una carga de 120,000 células/ml, el mayor porcentaje
de reducción de dinoflagelados (100%) se obtuvo usando 6 kg/ha sulfato de cobre (CuSO4), mientras que el segundo tratamiento más efectivo fue el peróxido de hidrógeno (H2O2 a 8 l/ha), con un porcentaje de reducción del 85% (Figura 2). La cal viva CaO-A dosificada a razón de 125 kg/ha tuvo un menor efecto que los anteriores, pero siguió siendo superior al
detergente industrial y al uso de tierras de diatomeas. Al adicionar al agua detergente industrial (DI) equivalente a 1 kg/ha y, en otro tanque, tierra de diatomeas (TD) con una dosis de 125 kg/ha, se pudo cuantificar una reducción del 62% y 59%, respetivamente.
El control que no fue tratado con nada, como se esperaba, tuvo una disminución natural del 17%.
En el segundo ensayo la carga inicial de dinoflagelados fue de 84,000 células/ml. Luego de 2 horas de la aplicación, se observó una reducción superior al 96% con óxido de calcio (CaO-B), peróxido de hidrógeno y sulfato de cobre (CuSO4) dosificados a razón 125, 8l y 6 kg, respectivamente por el equivalente a una hectárea (Figura 3).


En contraste, el detergente industrial a 1 kg/ha, CaO-A (125 kg/ha), dióxido de silicio (SiO2) a 10 kg/ ha y tierra de diatomeas a 125 kg/ ha tuvieron un pobre efecto sobre la población de dinoflagelados, llegando a un valor que, siendo mayor al control, no sobrepasó el 40% de reducción.

Caso 3. Ensayo en verano sin aireación a doble dosis de los insumos
En el tercer ensayo con 400,000 células/ml y adicionando el doble de cantidades de insumos, se logró reducir a 84,000 células/ml equivalente al 21% de la concentración inicial de dinoflagelados aplicando 250 kg/ha óxido de calcio (CaO-B), mientras que usando 12 kg/ha de sulfato de cobre (CuSO4) se redujo a 96,000 células/ml, es decir, sobrevivió un 24% de la población inicial de dinoflagelados (Figura 4).
Con el uso de peróxido de hidrógeno (H2O2) a razón de 16 l/ha se alcanzó una reducción de 52%. Adicionalmente, 250 kg/ha cal viva (CaO-A) bajó la carga en un 48%, mientras que 2 kg/ha de detergente industrial logró eliminar el 21%. Finalmente, 20 kg/ha dióxido de silicio (SiO2) redujo el 4% de dinoflagelados. En el recipiente control, como era de esperarse, hubo una reducción mínima del 1%.
A pesar de haber tenido la mayor tasa de reducción de dinoflagelados, el uso excesivo y constante de sulfato de cobre (CuSOH2O4.5HH2O2O) tiene efectos negativos en el ecosistema. Al ser un alguicida provoca la reducción de otras especies deseables como las diatomeas, potencial daño a especies silvestres y al camarón, dependiendo de los cambios que genere en el pH de agua. Cuando hay pH bajo, se incrementa la solubilidad del cobre y, por ende, su concentración en el agua favorece a una alta toxicidad para
el fitoplancton, pero con el riesgo de afectar a los camarones que se encuentran en ese estanque.
De los compuestos que han sido usados como alternativas al sulfato de cobre, el agua oxigenada (H2O2) constituye una alternativa promisoria cuya efectividad se basa en la producción radicales que afectan las paredes celulares de los microorganismos por la oxidación de las proteínas, lípidos y DNA. El óxido de calcio también ha sido usado como herramienta para controlar el fitoplancton, ya que, al ponerse en contacto con el agua de la piscina, en lugar de disolverse como se esperaría, reacciona para formar hidróxido de calcio, el cual se disocia en calcio y dos iones de hidroxilo (OH-), con un efecto inmediato en la calidad del agua al aumentar el pH, reducir el fósforo soluble y el dióxido de carbono, limitando la fotosíntesis del fitoplancton. A su vez, el aumento del pH causa la precipitación de las partículas suspendidas y del fitoplancton, lo que baja su concentración en el agua.
En la Tabla 2 se presenta la comparación costo beneficio con relación a los precios del insumo vs. la reducción de cantidad de dinoflagelado Las reducciones de dinoflagelados no son necesariamente proporcionales a las dosis de los insumos usados. Al ponderar los promedios de los tres casos de estudio para los tres insumos evaluados, se confirma que los dos tratamientos con mayor eficiencia para reducir la población de dinoflagelados son el sulfato de cobre y óxido de calcio B (Tabla 3). Los costos por hectárea del sulfato de cobre son los más altos en todos los casos estudiados (Tabla 2). Aunque este compuesto mostró una considerable eficiencia en el rango de 84,000-120,000 células/ml, su utilización es una solución no idónea


y poco sostenible, lo cual constituye una limitante mayor, donde su costo no justifica la aplicación de la dosis estudiada.
El uso de peróxido de hidrógeno en concentración de 84,000 células/ ml parece ser una buena alternativa; sin embargo, si la carga se incrementa a 120,000 células/ml, no existe una reducción considerable de dinoflagelados. Si la carga es aún mayor (400,000 células /ml), la eficiencia de este insumo se reduce todavía más.

Bajo las condiciones en las cuales se desarrolló este estudio, el óxido de calcio B mostró ser la alternativa más eficiente con relación a costos, debido a que se demostró una mayor reducción en los conteos de esta especie incluyendo en escenarios con alta carga de dinoflagelados (400,000 células/ml), por lo que esta opción se considera ambientalmente más amigable y sostenible.
Este artículo es patrocinado por Skretting
Esta es una versión resumida desarrollada por el equipo editorial de Panorama Acuícola Magazine del artículo “COMO REDUCIR LAS CONCENTRACIONES DE DINOFLAGELADOS DE UNA MANERA SOSTENIBLE” escrito por VIVIAM RUGEL,CARLATORRES;MANUEL ESPINOZAORTEGA;CARLOS MORA-PINARGOTE;DIVA ALDAMA-CANO;CESAR MOLINA-POVEDA –SKRETTING. La versión original, incluyendo tablas y figuras, fue publicada en SEPTIEMBRE de 2022 en BOLETIN # 29- SKRETTING.


Se ha comprobado que la agavina funciona como una fibra dietética, ya que es resistente a la digestión y favorece el crecimiento de bacterias beneficiosas, por lo que en este estudio se evaluó su efecto sobre la estructura de la microbiota del intestino y el hepatopáncreas del Litopenaeuvannamei
Por: Redacción de PAM*Diversos estudios han demostrado la importancia de la microbiota en su huésped, incluso en el caso del camarón. La composición de la microbiota del Litopenaeu vannamei depende de factores ambientales entre los que se pueden mencionar la salinidad del agua y la dieta, y factores biológicos como el órgano y la etapa de desarrollo.
La producción de camarones es la actividad acuícola más rentable a escala mundial, principalmente
debido a la creciente demanda de las especies Litopenaeu vannamei y Penaeus monodon. Sin embargo, muchos factores, como mala calidad del agua e infecciones por virus y bacterias, pueden impedir una producción de camarones óptima, al igual que una tasa de conversión y un rendimiento razonables. En muchos casos, estas complicaciones pueden prevenirse con un manejo adecuado en la camaronicultura, a través de recambio de agua, prebióticos y probióticos, considerando
las restricciones impuestas en el uso de antibióticos. Además, el ambiente de la granja influye de manera importante en el intercambio microbiano entre agua, sedimentos y camarones. Este intercambio es esencial para mantener un balance adecuado entre microbios beneficiosos, inocuos y patógenos.
La harina de pescado es un ingrediente tradicional en las dietas de camarón, pero se ha convertido en un ingrediente limitante por la alta demanda, requiriéndo-

se la introducción de un adecuado sustituto de proteína vegetal. Desafortunadamente, en lo concerniente a L. vannamei, las dietas bajas en harina de pescado resultan en crecimiento reducido y rendimiento general deficiente. Diferentes enfoques han modulado la microbiota del camarón a través de la dieta, mejorando el crecimiento, la resistencia a enfermedades y la productividad. Se ha demostrado que la agavina, componente fructano del agave, es una mezcla compleja de carbohidratos solubles con una

amplia variedad de patrones estructurales en proporciones que dependen de la especie de agave, una combinación tan única que llevó a proponer la denominación de las inulinas como agavina. Se ha comprobado que, al igual que la inulina lineal, la agavina también funciona como una fibra dietética, ya que es resistente a la digestión y favorece el crecimiento de bacterias beneficiosas, por lo que en este estudio se evaluó su efecto sobre la estructura de la microbiota del intestino y el hepatopáncreas del L. vannamei.
En la Tabla 1 se presentan la formulación de las dietas empleadas en las pruebas y su composición proximal. Los fructanos de agave empleados en el estudio se obtuvieron de una planta de Agave tequilana Weber var. azul de 5 años de antigüedad, cultivada en Morelos, México.
El bioensayo se realizó dentro de un estanque de tierra (5 ha) de la camaronera “Camarones El Renacimiento S.P.R. de R.I.” en Sinaloa, México, durante 28 días, siguiendo las condiciones de cultivo tradicional, que consiste en un cultivo semintensivo con 20% de recambio de agua por día. Los alimentos se suministraron dos veces al día de forma manual y monitoreando el consumo mediante bandejas de alimentación. Las dietas contenían aproximadamente 375 g kg-1 de proteína bruta y 95 g kg-1 de lípidos brutos con tres niveles de agavina: la dieta basal (BD) sin agavina añadida, la dieta AG2 con 2% p/p de agavina, y AG10 con 10% p/p de agavina.
Se tomaron 180 camarones de peso similar y se distribuyeron en forma aleatoria en tres grupos de dietas (BD, AG2 y AG10), en tres repeticiones en 9 jaulas (110×110×120 cm), conteniendo 20 camarones por jaula, sumergidas a 90 cm de agua de mar dentro del estanque. Al final del bioensayo, los camarones de cada aula se contaron y pesaron para determinar supervivencia y ganancia de peso (WG, por sus siglas en inglés), para luego calcular tasa de ganancia de peso (WGR), tasa de crecimiento específico (SGR), consumo de alimento (FI), factor de conversión alimenticia (FCR), tasa de supervivencia (SR) y otros parámetros de crecimiento.

La aplicación de una dieta suplementada con 2% de agavina mostró un impacto favorable en los parámetros de crecimiento del camarón.
Los camarones alimentados con la dieta que contenía 2% de agavina (AG2) mostraron un FCR significativamente más bajo (p > 0.05) y un total de consumo de alimento (TFI, por sus siglas en inglés) y una relación de eficiencia de proteínas (PER, por sus siglas en inglés) significativamente más altos (p < 0.05) que BD (Tabla 2). Sin embargo, no se observó diferencia significativa en la supervivencia y otros parámetros evaluados entre todos los grupos (Tabla 2).
La dieta tuvo un efecto determinista más sustancial en la microbiota del hepatopáncreas que en el intestino. El análisis de diversidad alfa mostró que la dieta AG2 parecía disminuir la diversidad y riqueza en ambos órganos, siendo solo significativa en el intestino. Por el contrario, la dieta AG10 tendió a aumentar la diversidad y riqueza alfa en ambos órganos. Sin embargo, la diferencia no fue significativa.
Se observó que la mayoría de Unidades Taxonómicas Operacionales se compartieron entre los tratamientos. Los filos más abundantes para hepatopáncreas fueron Proteobacteria con 65.31%, 63.17% y 54.18% para las dietas AG2, AG10 y BD respectivamente, y para el intestino con 60.76%, 54.79% y 49.88% para las dietas AG2, AG10 y BD respectivamente.
Los resultados sugieren que AG10, la dieta que contenía 10% de agavina, indujo el enriquecimiento
del mayor número de taxones en ambos órganos. El mayor impacto de las dietas en taxones diferencialmente abundantes en el hepatopáncreas estuvo de acuerdo con el efecto más sustancial también observado en la diversidad beta para este órgano.
De los 42 microbios benéficos encontrados en la microbiota del camarón, se observaron nueve especies ya presentes en la agavina. De esos nueve, cinco especies estaban presentes en todas las muestras de camarones (Figura 1). Curiosamente, las otras dos especies (Lactobacillus lactis y Lactobacillus delbrueckii) solo se encontraron en camarones alimentados con agavina (tanto AG2 como AG10), pero estuvieron ausentes en camarones alimentados con la dieta BD (Figura 1). Además, Lysinibacillus fusiformis, presente en agavina, solo se encontró en camarones alimentados con AG10 (Figura 1). Estos resultados sugieren que estos tres microbios beneficiosos podrían haberse introducido con agavina, ya que estaban ausentes en los camarones alimentados con la dieta BD.
Es esencial comprender el papel que juega la microbiota en la salud y la enfermedad del camarón para poder manejar su composición durante las condiciones estresantes que podrían afectar la producción en las granjas. En este contexto, diversas investigaciones han demos-
trado el efecto beneficioso de los prebióticos en las instalaciones de producción de camarones. En este estudio, la aplicación de una dieta suplementada con 2% de agavina mostró un impacto favorable en los parámetros de crecimiento del camarón, como lo revela el FCA y un consumo de alimento significativamente más bajo, en concordancia con otros trabajos donde las fibras dietéticas se incluyen en la dieta en calidad de prebióticos. Esta mejora en el FCA podría estar relacionada con el índice de eficiencia proteica significativamente mayor, obtenido con la dieta enriquecida con agavina al 2% en comparación con la dieta basal, sugiriendo que los cambios en la microbiota podrían estar asociados con una mayor eficiencia de la ingesta de proteínas.
Es interesante cómo una mayor proporción de agavina en la dieta para camarones (AG10) mantiene los mismos parámetros de rendimiento de crecimiento que los camarones alimentados con la dieta BD. Se sugiere que la mejora de los parámetros de desempeño del crecimiento usando agavina al 2% puede deberse a un efecto de saciedad observado en un menor consumo de alimento, contrario al evidenciado con agavina al 10%. Se han identificado efectos dependientes de la dosis de inulinas en humanos, donde una dosis más alta no necesariamente tiene un mejor efecto, sino que puede ser el caso contrario.
Los resultados demuestran que los cambios en la microbiota del camarón dependen de la concentración de agavina en la dieta.
La riqueza y diversidad microbiana general y la abundancia de bacterias probióticas aumentaron con una dosis alta de agavina (10%). En contraste, la riqueza, diversidad y abundancia de bacterias probióticas disminuyó con una dosis baja de agavina (2%). Se ha observado que los cambios en la microbiota del intestino del camarón dependen de la dosis del prebiótico.
El hepatopáncreas y el intestino del camarón son órganos esenciales para la absorción y la digestión de nutrientes. La adición de agavina

solo ejerce un efecto significativo sobre la estructura de diversidad beta del hepatopáncreas, agrupando la microbiota según cada dieta. Por el contrario, este efecto no estuvo presente en el análisis de diversidad beta de los intestinos. Este comportamiento sugiere un proceso determinista al agregar agavina a la dieta, un efecto que fue más fuerte en el hepatopáncreas que en los intestinos.
En general, los resultados sugieren que la agavina podría ser un excelente prebiótico de oligosacáridos, disacáridos, monosacáridos y polioles fermentables para enfermedades asociadas al hepatopáncreas, debido al efecto determinista en la estructura de la microbiota de este órgano. Tal comportamiento también indica que la estructura de la microbiota del hepatopáncreas podría estar más influenciada por los prebióticos que la del intestino. La suplementación con agavina al 2% mejoró el rendimiento del crecimiento, aunque la abundancia de microbios beneficiosos fue significativamente mayor al 10% en comparación con el control. Sin embargo, el rendimiento de crecimiento al 10% fue el mismo observado para la dieta basal. Se podría considerar que un alimento suplementado con 10% de agavina ofrece mejor protección que 2% contra posibles patógenos, sin reducir el rendimiento de crecimiento de los camarones. Estos hallazgos aclaran que la concentración de prebióticos es crucial cuando se implementa una estrategia de prebióticos en el cultivo de camarones.
El hepatopáncreas de AG2 se enriqueció con los géneros Methylobacterium y Bradyrhizobium Los miembros de Bradyrhizobium son capaces de fijar nitrógeno. La fijación bacteriana de nitrógeno es utilizada por distintos organismos para compensar dietas nutricionalmente desequilibradas con alto contenido de carbono y bajo contenido de nitrógeno. El índice de eficiencia proteica fue significativamente mayor en la dieta con 2% de agavina que en la de control, sugiriendo que el Bradyrhizobium enriquecido podría participar en la fijación de nitrógeno, provocando el aumento en el índice de eficiencia proteica.
En estudios recientes se propuso un proceso similar para Totoaba macdonaldi, un pez depredador en el que una dieta suplementada con 2% de agavina también mos-
La riqueza y diversidad microbiana general y la abundancia de bacterias probióticas aumentaron con una dosis alta de agavina.
tró una mayor eficiencia proteica a través del enriquecimiento de Sinorhizobium, un género de bacterias fijadoras de nitrógeno. Por otro lado, la familia Bacillaceae, específicamente el género Bacillus, se enriquecieron en los intestinos de la dieta AG10. Es bien conocido el potencial probiótico de la bacteria Bacillus, una bacteria probiótica multifuncional con una probada capacidad para aumentar la rentabilidad de la acuicultura.
El estudio muestra claramente una influencia dependiente de la dosis de agavina en la composición de la microbiota y el rendimiento general de L. vannamei. Si bien el objetivo de este estudio no fue dilucidar los mecanismos a través de los cuales la agavina participa en el metabolismo de L. vannamei, su inclusión en la dieta promueve una microbiota saludable mediante una mayor abundancia de microbios beneficiosos. Se requiere más investigación para dilucidar el papel de la agavina en la mejora del crecimiento y la abundancia de microbios benefi-
ciosos por medio del análisis de la expresión de genes involucrados en el sistema inmunológico.
Esta es una versión resumida desarrollada por el equipo editorial de Panorama Acuícola Magazine del artículo “AGAVIN INDUCES BENEFICIAL MICROBES IN THE SHRIMP MICROBIOTA UNDER FARMING CONDITIONS” escrito por JUAN PABLO OCHOA-ROMO,FERNANDA CORNEJO-GRANADOS,FILIBERTO SÁNCHEZ,LUIGUIGALLARDO-BECERRA, MIRNALUQUE-VILLEGAS, YESENIAVALDEZ-LÓPEZ,ADRIAN OCHOA-LEYVA - Universidad Nacional AutónomadeMéxico(UNAM);ALONSOA. LOPEZ-ZAVALA - Universidad de Sonora (UNISON);MARÍATERESAVIANAUniversidadAutónomadeBajaCalifornia (UABC);ROGERIOR.SOTELO-MUNDO –CentrodeInvestigaciónen AlimentaciónyDesarrollo,A.C.(CIAD); ANDRÉSCOTA-HUÍZAR-Camarones ElRenacimientoSPRdeRI;AGUSTÍN LÓPEZ-MUNGUIA – Instituto de Biotecnología,UNAM.La versión original, incluyendo tablas y figuras, fue publicada en ABRIL de 2022 en NATURE Se puede acceder a la versión completa a través de https://doi.org/10.1038/s41598-02210442-2

Cargill, líder global en alimentos para la acuicultura y la nutrición animal, ha desarrollado su línea de dietas líquidas LiquaLife® para larvas de camarón, con el fin de garantizar al productor una nutrición más sostenible y camarones saludables.
Por: Redacción de PAM*.La demanda de productos del mar está aumentando. Investigaciones emergentes como la “Evaluación de Alimentos Azules” de 2021, muestran la relevancia de la acuicultura para la nutrición humana. En el sector acuícola, el cultivo de camarón es el de mayor crecimiento a nivel mundial, el cual se considera uno de los productos no petroleros de mayor exportación en el mercado internacional. Por tanto, mantener y mejorar sus niveles de producción es de suma importancia para la economía y seguridad alimentaria de muchas naciones.
El ciclo de vida de los camarones se puede dividir en varias etapas. En la etapa larval van cambiando de forma y pasan por varios estadios a lo largo de su desarrollo, durante los cuales es necesario abordar distintas estrategias de alimentación. En la naturaleza, las larvas dependen básicamente de diatomeas y zooplancton que les brindan sus requerimientos nutricionales. En laboratorio y cultivo, se trata de emular la alimentación natural a través de cultivos masivos monoalgales y de Artemia. Dichos cultivos presentan una alta variabilidad en su producción y calidad, por lo que los beneficios obtenidos para los organismos no son los esperados.
En consecuencia, se han desarrollado alimentos artificiales, cuya aplicación radica en el reemplazo parcial o total del alimento vivo. Una de las empresas en este rubro es Cargill, líder global en alimentos para la acuicultura y la nutrición animal. En la actualidad, Cargill atiende a clientes y comunidades en 70 países con más
de 155,000 empleados alrededor del mundo, brindando productos alimenticios, agrícolas, financieros e industriales de manera segura, responsable y sostenible.
El alimento artificial puede clasificarse, de acuerdo a su presentación, en alimento seco y alimento líquido. En las dietas líquidas han surgido muchos avances tecnológicos para larvas de camarón con la finalidad de brindarle una nutrición óptima y, además, mejorar la calidad del agua. Para esta etapa, Cargill ofrece la mejor opción, LiquaLife® maximiza el retorno de la inversión permitiendo lograr más biomasa, mejores tamaños y camarones más saludables. Se estima que la producción global de camarón se incremente sobre un 11% durante los próximos 4 años, la cual debe sustentarse con un suministro continuo de postlarvas saludables. Es por ello que el apoyo nutricional en esta etapa crítica de crianza del camarón es tan importante (Figura 1).
En el desarrollo de LiquaLife® se tomaron en cuenta los siguientes aspectos:

9 Nutrición de calidad: permite impulsar el máximo potencial genético de los organismos.
9 Bioseguridad: prácticas de producción adecuadas para asegurar larvas de la mejor calidad sanitaria.
9 Genética: facilita el desarrollo de programas de selección y mejoramiento genético.
Ciclo de cultivo del camarón y nutrición asociada
Las características únicas de LiquaLife® se ajustan al ciclo de cultivo del camarón (Figura 2) y toman en consideración los diferentes requerimientos de la etapa larvaria. Durante el cultivo, los cambios (metamorfosis) de estadios larvarios son causantes de gran estrés. Las larvas tienen un tracto digestivo en desarrollo y requieren disponibilidad de alimentos en cantidad y calidad. Además, se debe otorgar alimentos que sean de alta digestibilidad y fácil absorción y entregar un rango de tamaño de partículas adecuadas para el estadio de desarrollo.
Microencapsulación. Nutrición consistente: más nutrientes disponibles
LiquaLife® entrega nutrientes a la etapa larvaria de manera efectiva y eficiente. El proceso de microencapsulación genera perlas estabilizadas y perfectamente hidratadas con el tamaño adecuado y la homogeneidad ideal para facilitar el comportamiento de alimentación natural de los camarones. La estructura básica en capas de las microcápsulas de LiquaLife® evita la pérdida de nutrientes por lixiviación (Figura 3).
Beneficios de LiquaLife® para el productor Nutrición sostenible: ambiente mejorado del tanque Las perlas preestabilizadas de LiquaLife® permanecen intactas hasta que las larvas de camarón las comen, lo que evita la pérdida de nutrientes,
dietas líquidas que mejoran el crecimiento de las larvas de camarón
a diferencia de los alimentos secos que comienzan a lixiviarse al contacto con el agua, aumentando los niveles de materia orgánica y amoníaco
Por las características de su fabricación y calidad física, LiquaLife® ayuda a mejorar la calidad del agua con su contenido de bacterias exoprobióticas, proporcionando a las larvas de camarón un agua más limpia y un entorno más saludable.
Embalaje perfecto: ahorra tiempo, fácil de usar.
El alimento para camarones LiquaLife® está empacado en una práctica bolsa que facilita la alimentación. Simplemente agite el empaque, mida o pese lo requerido, agregue una pequeña cantidad de agua y viértala en el tanque de cultivo. No es necesario moler, tamizar o hidratar.
Los beneficios que ofrece a los productores de camarones se resumen en los siguientes atributos del producto:
9 Estructura de capas que evita pérdida de nutrientes (no lixiviación).
9 Nutrientes permanecen intactos hasta ser consumidos.
9 Impacto muy reducido sobre la calidad de agua.
9 Perlas se dispersan en la columna de agua.
9 Maximiza interacción entre larva y alimento.

9 Incrementa el consumo de alimento.
9 Reduce el gasto de energía
Es necesario garantizar que el sector de la acuicultura continúe creciendo y contribuya, cada vez más, al suministro de alimentos de una manera sostenible. Cargill colabora con este objetivo a través de su línea de dietas líquidas LiquaLife®, la mejor opción para que los productores suministren continuamente postlarvas saludables, maximizando el retorno de la inversión, permitiendo lograr más biomasa, mejores tamaños y camarones más saludables.


Este artículo es patrocinado por Cargill

excretados en el medio ambiente, contaminando los tanques y facilitando la proliferación de bacterias y parásitos como el Zoothamnium
Esta es una versión resumida desarrollada por el equipo editorial de Panorama Acuícola Magazine del artículo “DIETASLÍQUIDAS MEJORA EL CRECIMIENTO DE LAS LARVAS DE CAMARÓN”escrito por CARGILL.
Ciertos aditivos pueden controlar los patógenos de Vibrio; sin embargo, hay otras formas, y a menudo más efectivas, en especial porque son de naturaleza ubicua y casi imposibles de eliminar, aunque aportan iguales beneficios y actúan sinérgicamente. Aquí, presentamos tres nuevos conjuntos de datos para demostrarlo.
 Por: Benedict Standen*
Por: Benedict Standen*
mucho menos reportados, ya que las metodologías son más complejas. No obstante, aportan iguales beneficios y actúan sinérgicamente. Aquí, presentamos tres nuevos conjuntos de datos para demostrarlo.
1. Interrupción de la función y la integridad de la membrana
Las membranas celulares son vitales, ya que mantienen condiciones internas óptimas. Esto es particularmente cierto para los patógenos Gram-

negativos (por ejemplo, Vibrio), donde la membrana de lipopolisacáridos (LPS) proporciona una gran protección. Una estrategia clave es interrumpir esta membrana, reduciendo la virulencia, la resistencia e, incluso, la muerte celular. Nuevos datos demuestran que una mezcla única de sustancias antimicrobianas (Complejo permeabilizanteTM) puede interferir con la integridad y la funcionalidad de la membrana de Vibrio parahaemolyticus (Figura 1).
Es de conocimiento común que ciertos aditivos pueden controlar los patógenos de Vibrio, por lo general, a través de la inhibición directa. Sin embargo, hay otras formas, y a menudo más efectivas, de controlar Vibrio, especialmente dado que son de naturaleza ubicua y casi imposibles de eliminar. Estos modos de acción son

La detección de quorum se refiere a la comunicación bacteriana y es responsable de una serie de mecanismos, incluida la bioluminiscencia, la virulencia y la formación de biopelículas. Aquí, presentamos datos de que una serie de sustancias fitogénicas y extractos bacterianos son capaces de controlar esta detección de quorum, conocida como quorum quenching (Figura 2).



Se sabe que algunas especies de Vibrio producen toxinas. Por ejemplo, al menos cuatro especies conocidas de Vibrio son capaces de pro-
ducir toxinas pirA y pirB, que causan un gran daño al hepatopáncreas, la causa confirmada de la necrosis hepatopancreática aguda (AHPND, por sus siglas en inglés). Una publicación reciente muestra por primera vez, que un Bacillus sp. es capaz de degradar ambas toxinas, en un corto período de tiempo (Nguyen et al., 2021). De hecho, cuando se le desafió con una combinación purificada de toxinas pirA y pirB, la Artemia mostró una supervivencia significativamente mayor cuando se complementó con el probiótico (Figura 3). Otros estudios también confirman resultados similares en camarones, Litopenaeus vannamei.


Como se sabe, la harina de pescado es la principal fuente de proteína en dietas para camarones; sin embargo, existe la necesidad de su reemplazo para asegurar la sostenibilidad del sector acuícola, tarea en la que el uso de nucleótidos como ingrediente funcional en camarones Litopenaeus vannamei alimentados con dietas con una alta inclusión de fuentes de proteínas vegetales mostró resultados beneficiosos en los cultivos.
 Por: Redacción de PAM*
Por: Redacción de PAM*
Un ingrediente funcional es un componente activo presente en diferentes materias primas, como frutas, hortalizas, cereales, leguminosas, entre otras, que por medio de la tecnología se puede extraer e incorporar en otros alimentos con la finalidad de atribuirle propiedades beneficiosas para la salud. Existe una gran variedad de ingredientes
funcionales que se emplean en calidad de aditivos en alimentos usados en las dietas acuícolas, entre los cuales se encuentran las sustancias fitógenas, los probióticos, las enzimas, los antioxidantes y otros ingredientes emergentes como los nucleótidos. Todos estos productos tienen una estrecha relación con el estado de salud y el crecimiento, importantes para el correcto funcio-
namiento del proceso de absorción en la digestión y para la protección frente a los agentes patógenos.
En un sistema intensivo de cultivo del camarón, la calidad de la alimentación es esencial para aumentar la productividad mediante el suministro de dietas equilibradas que satisfagan sus requisitos nutricionales específicos durante el periodo de cultivo. Sin embargo,
cada vez es más frecuente, el uso de ingredientes funcionales para garantizar la ingesta, digestión, absorción y transporte de los ingredientes alimenticios a las células, así como para mejorar el rendimiento y la resistencia a las enfermedades.
Durante décadas, no fue habitual el uso de nucleótidos en la acuicultura, precisamente porque no suelen considerarse esenciales, desde el punto de vista nutricional. Dado los hallazgos de diversas investigaciones publicadas que señalan su deficiencia como perjudicial para las funciones hepática, cardíaca, intestinal e inmunitaria, la administración de nucleótidos a través de la dieta podría resultar adecuada con el fin de garantizar su suministro y disponibilidad para los organismos acuáticos, en especial, durante los momentos de alta demanda en varios procesos fisiológicos y metabólicos. Complementar la alimentación de los camarones con una fuente externa de nucleótidos puede ser una buena estrategia en muchas situaciones.
En la actualidad, la harina de pescado (HP) es la principal fuente de proteínas en los alimentos para peces, pero su disponibilidad limitada se ve afectada por muchos factores, entre ellos el cambio climático. Por tanto, su sustitución constituye un reto para los proveedores de alimentos para peces y ha estimulado un gran número de investigaciones en los últimos años para encontrar fuentes de proteínas sostenibles, eficaces y económicas.
En consecuencia, utilizando una doble estrategia de alimentación, con dietas formuladas que contengan un bajo nivel de harina de pescado (HP), y la inclusión de nucleótidos de levadura, se puede ayudar a optimizar el crecimiento y la salud del camarón a pesar del desafío nutricional. En este artículo se presenta un estudio realizado recientemente en camarón blanco del Pacífico ( Litopenaeus vannamei ), con suplementación de nucleótidos en dietas con altos niveles de harina de soja (HS) para reemplazar el uso de HP.
El estudio de crecimiento se realizó en el departamento de investigación PT. Batam Dae Hae Seng (Batam, Indonesia). PT. Maju Tambak Sumur (Kalianda, Lampung, Indonesia) pro-
porcionó un total de 900 postlarvas (PL) que se aclimataron al sistema de cría. Las PL se alimentaron con un alimento comercial (Evergreen Feed, Lampung, Indonesia) durante tres semanas hasta que alcanzaron el tamaño adecuado. Los camarones (4.24 ± 0.03 g de peso medio inicial) se distribuyeron aleatoriamente en 60 tanques de 70 x 35 x 40 cm (98 L por acuario). A seis grupos replicados de camarones se les administraron diferentes tipos de dietas experimentales, empleando un protocolo estándar de investigación nutricional durante 70 días, y se proporcionó alimentación a mano, cuatro veces al día, a las 07:00, 11:00, 15:00 y 20:00 h. La fórmula para calcular los aportes diarios de alimento (g) fue la siguiente:
Aportes diarios de alimento (g) = (FCR estimado * Crecimiento previsto * número de camarones)/7
Los aportes alimenticios se preprogramaron asumiendo el crecimiento normal del camarón con un factor de conversión alimenticia (FCR, por sus siglas en inglés) estimado de 1.5 a lo largo del estudio de crecimiento. Las raciones diarias de alimento se ajustaron en función del consumo observado, los recuentos semanales de los camarones y la mortalidad. El alimento no consumido, las heces y las mudas se eliminaron con la ayuda de un sifón en el tanque del acuario antes de la primera alimentación.
Al final del período de alimentación, todos los camarones se agruparon y se pesaron individualmente para calcular la biomasa final, el peso final (FBW, por sus siglas en inglés), el porcentaje de aumento de peso (PWG), el factor de conversión alimenticia (FCR), el porcentaje de supervivencia (SR) y el coeficiente de crecimiento térmico (TGC). Con una jeringa estéril de 1 ml, se extrajo hemolinfa de dos camarones intermuda por tanque o de diez camarones por tratamiento de la base del pleópodo del segundo segmento abdominal. La actividad de la lisozima se midió utilizando un kit de detección de lisozima y los resultados se definieron por la lisis de las células de Micrococcus lysodeikticus. Las reacciones se llevaron a cabo a 25°C y se midió la absorbancia a 450 nm en el espectrofotómetro ultravioleta/visible.
La prueba de exposición bacteriana se realizó después del estudio de crecimiento usando una suspensión de Vibrio harveyi hasta alcanzar la densidad de 1 x 105 UFC/ml. Cada grupo de tratamiento tenía 6 réplicas y se alimentaron 4 veces al día con la cantidad mínima de alimento. El experimento de cultivo se prolongó durante 7 días: diariamente se cambió el 25% del agua para evitar el deterioro de su calidad y se añadió agua con la concentración de la cepa correspondiente para mantener la concentración adecuada. Durante este periodo, cada día se evaluó la mortalidad de los

Complementar la alimentación de los camarones con una fuente externa de nucleótidos puede ser una buena estrategia en muchas situaciones.
camarones, para luego calcular la mortalidad acumulada.
Rendimiento del crecimiento
La administración de suplementos de nucleótidos produjo mejoras en los parámetros de rendimiento, especialmente en los grupos de estudio
en los que la HP se había sustituido parcialmente por HS, mientras que no se encontraron diferencias significativas entre los grupos (p > 0.05) (Tablas 1 y 2). Dado que todas las dietas se elaboraron empleando ingredientes de alta digestibilidad y apuntando a niveles similares de proteínas y lípidos, no se registraron diferencias significativas (p > 0.05)


en cuanto al nivel de proteínas en todo el cuerpo del camarón blanco, ni en la tasa de retención de proteínas. Sin embargo, la inclusión de nucleótidos en general favoreció el aprovechamiento de los nutrientes por parte de los camarones de forma similar al grupo de camarones alimentados con la dieta de control. Curiosamente, la reducción de la HP y la suplementación con nucleótidos no afectó al depósito de proteínas de los camarones.
Salud y respuesta a la exposición a V.harveyi La suplementación con nucleótidos permitió un aumento significativo (p < 0.05) de los recuentos de hemocitos totales y de la actividad de la lisozima, en comparación con el grupo sin suplementación de nucleótidos en el que la HP había sido parcialmente sustituida por HS (Figuras 1 y 2). Se observó un efecto de la dosis en el caso de los nucleótidos, ya que el 0.1% obtuvo mejores resultados que el 0.05%. Para la prueba de exposición, todas las dietas suplementadas con nucleótidos registraron tasas de supervivencia significativamente más altas (p <
0.05) en comparación con la dieta de control, pero también en comparación con el grupo alimentado con una dieta sin suplemento de nucleó-
tidos y con sustitución parcial de la HP por HS (dieta 1). Las mayores tasas de supervivencia se alcanzaron con las dietas 3 y 5 con niveles


de inclusión del 10% y 8% de HP, respectivamente, y suplementadas con 0.1% de nucleótidos (Figura 3).
En las condiciones del presente estudio, la suplementación con nucleótidos mostró una tendencia positiva en el rendimiento, el sistema inmunitario y la resistencia a las enfermedades contra V. harveyi en el camarón blanco del Pacífico ( Litopenaeus vannamei ). Por lo tanto, los nucleótidos podrían emplearse como ingredientes alimenticios funcionales para mejorar la salud del camarón en conjunto con dietas formuladas con altos niveles de harina de soja. Esta investigación también aporta pruebas acerca de los efectos beneficiosos para la salud del camarón blanco Pacífico (L. vannamei) derivados de la incorporación de nucleótidos en la dieta cuando se reduce la cantidad de harina de pescado.

Este artículo es patrocinado por Bioiberica.
Esta es una versión resumida desarrollada por Novriadi, R. del artículo “EFFECTS OF DIETARY NUCLEOTIDES SUPPLEMENTATION ON GROWTH,TOTAL HAEMOCYTE COUNT,LYSOZYME ACTIVITY AND SURVIVAL UPON CHALLENGE WITH VIBRIO HARVEYI IN PACIFICWHITE SHRIMP,LITOPENAEUSVANNAMEI” escrito por: NOVRIADI ROMI - Directorate General of AquacultureyJakartaTechnicalUniversity ofFisheries,MinistryofMarineAffairsand Fisheries,Indonesia;ILHAMILHAM-Jakarta TechnicalUniversityofFisheries,Ministry ofMarineAffairsandFisheries,Indonesia; ROIGÉORIOL-R&DBioibericaS.A.U.,España, ySEGARRASERGI,R&DBioibericaS.A.U., España. La versión original, incluyendo tablas y figuras, fue publicada en NOVIEMBRE de 2021 en AQUACULTUREREPORTS. Se puede acceder a la versión completa a través de https://doi. org/10.1016/j.aqrep.2021.100840.
ROMI NOVRIADI Profesor de la Politeknik Ahli Usaha Perikanan (AUP) y vicepresidente de la Sociedad de Acuicultura de Indonesia (E-mail: novriadiromi@yahoo.com o romi.novriadi@ kkp.go.id)
Utilizando una doble estrategia de alimentación, con dietas formuladas que incluyan un bajo nivel de harina de pescado y la inclusión de nucleótidos de levadura, se puede ayudar a optimizar el crecimiento y la salud del camarón a pesar del desafío nutricional.
La industria acuícola de cultivo de bivalvos y moluscos a lo largo de la costa oeste de los EE.UU. es particularmente vulnerable a la acidificación del océano, por lo que profundizar acerca de la percepción de dueños y gerentes de granjas puede contribuir a identificar estrategias específicas para mejorar las políticas, la coordinación y los avances científicos dentro de la industria y las agencias asociadas.
 Por: Redacción de PAM*
Por: Redacción de PAM*
Las comunidades costeras y los usuarios de sus recursos experimentan una amplia variedad de factores estresantes ambientales y de sustento, incluida la intensa competencia por recursos, la urbanización y la degradación ambiental que afectan los recursos de los cuales dependen. El cambio climático exacerba estos factores de estrés y crea nuevas presiones sobre el entorno costero y las personas cuyos medios de subsistencia dependen de ellos. La gran mayoría del trabajo académico sobre el impacto del cambio climático ha consistido en la evaluación biofísica y respuestas a los estresores del ambiente. Si bien los académicos han comenzado a explorar los aspectos sociales, económicos y políticos de la adaptación a estos cambios, gran parte de este trabajo sigue siendo teórico.
Uno de los sistemas para los que la adaptación climática se presenta crítica en los próximos años es la acuicultura marina, en especial, la acuicultura de mariscos (definida en este estudio como cultivo de bivalvos y moluscos). Se sabe rela-
tivamente poco acerca de cómo los operadores acuícolas y las comunidades dependientes de las operaciones acuícolas perciben y responden a la acidificación oceánica (OA) y a otros factores ambientales estresantes, o sobre las acciones específicas que han tomado o las necesidades que tienen para prepararse o mitigar estos factores. En tal sentido, la acuicultura de moluscos surge como una oportunidad para realizar investigaciones integradoras sobre sistemas socioecológicos, las cuales contribuyan a mejorar la
comprensión de la capacidad de adaptación frente a los impactos climáticos actuales y futuros.
En el estado de California, se está prestando atención a la acuicultura, con inversión en investigación relacionada con el desarrollo de un plan estatal de acuicultura. Sin embargo, esta región está excepcionalmente expuesta al estrés inducido por el cambio climático a través de OA y otros factores ambientales estresantes, los cuales pueden ser de particular preocupación para la actividad. De manera particular, este estudio se

enfoca en la acuicultura de bivalvos y moluscos en tres regiones del estado de California: Humboldt, Point Reyes y la Costa Central.

Se realizaron entrevistas semiestructuradas a los dueños y/o gerentes principales de las operaciones acuícolas en las tres regiones focales (Figura 1), de tres a cuatro entrevistas por región. Estas se diseñaron para abordar las preguntas de investigación, utilizando guías de trabajos anteriores en la región como marco
de referencia. La guía fue evaluada previamente por expertos en acuicultura de mariscos para garantizar preguntas claras y relevantes acerca de la percepción de los entrevistados sobre el cambio ambiental.

El escenario acuícola regional de California
Se solicitaron entrevistas a representantes de 13 operaciones de bivalvos y moluscos en las regiones combinadas, de las 19 operaciones existentes en el estado. Se recibieron 11 respuestas, resultando en un tamaño de muestra que representa más de la

mitad del total (Tabla 1). Las ostras fueron las especies más comunes cultivadas por los entrevistados, en 8 de las 11 granjas.
En todas las entrevistas, las enfermedades marinas y los patógenos se mencionaron frecuentemente como impactos ambientales (Figura 2), al igual que las lluvias y la proliferación de algas, debido a la asociación que tienen estos factores con enfermedades y patógenos marinos. La temperatura del agua se señaló con frecuencia y, en algunos casos, los productores informaron
La acuicultura de bivalvos y moluscos representa una oportunidad para realizar investigaciones integradoras sobre sistemas socioecológicos que mejoren la comprensión de la capacidad de adaptación frente a los impactos climáticos actuales y futuros.
que la misma se estaba volviendo más cálida.
Muchos productores también refirieron los factores químicos del carbonato; sin embargo, al contrario de los demás factores ambientales mostrados en la Figura 2, se preguntó específicamente si ellos pensaban que habían experimentado cambios o impactos derivados de la OA, lo que dificulta evaluar la percepción de los entrevistados sobre la importancia relativa de la OA en comparación con otros factores mencionados.
Dada la gran cantidad de factores estresantes e impactos que experimentan los productores, los entrevistados identificaron una variedad de posibles estrategias de adaptación para garantizar que sus operaciones sobrevivan al cambio, tanto de OA como de desafíos ambientales, sociales, económicos o regulatorios más amplios. Las estrategias específicas discutidas por los productores pueden describirse en tres categorías generales:
1. Políticas y trabajo en red Las estrategias discutidas con mayor frecuencia corresponden a la categoría de política y redes de apoyo o trabajo, siendo las estrategias adaptativas más discutidas los cambios regulatorios y de permisología y el desarrollo y apoyo en redes (Figura 3). Cuando se profundizó en permisología y regulaciones, los comentarios estuvieron dirigidos a que los procesos de permisos difíciles, costosos y lentos inhibían la capacidad general de adaptarse o permanecer resistente al cambio, un desafío descrito anteriormente con respecto a la acuicultura tanto en California como en los Estados Unidos (EE.UU.).

2. Gestión de las granjas. Los productores mencionaron una serie de estrategias prácticas en torno a la gestión de las granjas de bivalvos y moluscos, que pueden facilitar su capacidad adaptativa: permitir una mayor flexibilidad en la especie o etapa cultivada, o en los métodos o localización del cultivo. Cultivar especies o etapas de vida numerosas o adicionales proporciona un tipo de seguro, similar al “efecto portafolio” aplicado tanto en el área ecológica como económica. De esta manera, los negocios de los productores podrían mantener los ingresos y las operaciones si una de las especies o etapa de vida falla más que la otra, debido a eventos de mortalidad, cambios en el mercado u otros factores. Algunos productores identificaron esto como una estrategia que será más necesaria en el futuro, para diversificar sus productos y asegurar un ingreso estable bajo condiciones oceánicas variables. Los productores también expresaron su deseo de modificar o expandir los métodos de cultivo, el equipo o la ubicación para generar una mayor flexibilidad en las operaciones.
3. Ciencia. La necesidad de un mejor entendimiento de los impulsores de la salud y la mortalidad de los bivalvos y moluscos se mencionó en todas las entrevistas menos en una (Figura 3). Los eventos de mortalidad pueden ser severos y periódicamente conducen a la pérdida de la mayoría de los bivalvos y moluscos en algunas áreas de arrendamiento o criaderos.

Artículo de fondo
Aunque este estudio fue específico para la industria acuícola de bivalvos y moluscos de la costa oeste de los EE.UU., su relevancia y vínculos con el campo más amplio de la capacidad de adaptación a factores estresantes son evidentes.
Las entrevistas con los productores revelaron numerosos factores estresantes ambientales y de otro tipo que afectan a la industria de bivalvos y moluscos en California e identificaron múltiples estrategias disponibles para facilitar la capacidad de la industria para adaptarse a estos factores estresantes. Las estrategias adaptativas estaban frecuentemente vinculadas, en cuanto a la reducción de un factor estresante que pudiera permitir a los productores asignar recursos para la implementación de una estrategia dirigida a otros factores estresantes. En particular, la capacidad de los productores para ejecutar una determinada estrategia de adaptación a menudo podría verse facilitada por un proceso de permisos modificado. De hecho, el enfoque citado con más frecuencia para la adaptación fue la modificación o agilización de los procesos regulatorios y de permisos, ya que la obtención de permisos y el cumplimiento de las reglamentaciones son necesarios para realizar cambios en la mayoría de las prácticas de gestión acuícola.
Aunque el estudio fue específico para la industria acuícola de bivalvos y moluscos de la costa oeste de EE.UU., su relevancia y vínculos con el campo más amplio de la capacidad de adaptación es evidente. Las estrategias descritas, aunque adaptadas a estas especies en específico y región, se pueden clasificar de manera más amplia en dominios de capacidad de adaptación observados en otras comunidades y geografías. En un informe sobre el tema, Cinner et al. (2018) identificaron cinco dominios comunes de capacidad de adaptación: activos, flexibilidad, organización social, aprendizaje y agencia. Al realizar un análisis cruzado de estos cinco dominios y las estrategias identificadas por los productores, se concluye que se
pueden poner en práctica en las 18 estrategias presentadas.
Por ejemplo, dentro del dominio de la “flexibilidad”, muchas de las estrategias de manejo de granjas descritas se basan en la necesidad de flexibilidad, como el deseo de adaptar las especies o los equipos usados para el cultivo (especies y método/tipo de equipo) o la capacidad de mover equipos alrededor de su área de arrendamiento (flexibilidad espacial) (Figura 3).
De manera similar, los productores identificaron numerosos “activos” necesarios para implementar estas estrategias, por ejemplo, acceso al equipo necesario (métodos/ equipo) o tipos de instalaciones, como un criadero y un espacio de engorde (múltiples etapas del ciclo de vida). El dominio de la “organización social” es evidente en la confianza y el deseo de los productores de mejorar sus redes para obtener información y compartir datos. Las estrategias del dominio de “aprendizaje” son claras en las lagunas científicas identificadas, como el deseo de obtener más información sobre los impulsores de la mortalidad de los bivalvos y moluscos o sobre las condiciones de OA.
Los productores de bivalvos y moluscos de California observan y experimentan de manera directa numerosos cambios ambientales, algunos de los cuales son más fáciles de observar o medir. Si bien la mayoría de los productores expresaron su preocupación por las condiciones oceánicas cambiantes, con frecuencia fue un reto para ellos establecer un vínculo directo entre los resultados de sus operaciones y los cambios que podían ser fácilmente observados o medidos. En particular, relacionar impactos o resultados a OA planteó desafíos en sus habilidades para implementar respuestas directas. En cambio, OA se percibía como un multiplicador de estrés potencial y desconocido, y los productores identificaron (y en muchos casos están implementando) una serie de estrategias que podrían ayudarlos a
adaptarse a los cambios resultantes de factores estresantes ambientales, económicos o políticos.
Algunas estrategias apuntaron directamente al OA (p. ej., mejorar el monitoreo del pH o desarrollar reproductores resistentes al OA), pero la amplia gama de estrategias apoyó la adaptación a múltiples factores estresantes para facilitar una mayor resiliencia en el cultivo. Facilitar la capacidad de adaptación requiere un enfoque coordinado que reconozca la naturaleza interconectada de los factores de estrés y las estrategias asociadas, por lo que la reducción de un tipo de factor de estrés puede permitir a los productores asignar recursos de manera proactiva para la implementación de estrategias de adaptación relacionadas con otros factores de estrés para mejorar la resiliencia general. Al evaluar las estrategias de adaptación identificadas por los operadores de acuicultura y los desafíos clave para su ejecución, este trabajo evidenció la necesidad de mejorar las políticas, la coordinación y los avances científicos dentro de la industria de la acuicultura de bivalvos y moluscos y las agencias asociadas.
Esta es una versión resumida desarrollada por el equipo editorial de Panorama Acuícola Magazine del artículo “CALIFORNIA SHELLFISH FARMERS:PERCEPTIONS OF CHANGING OCEAN CONDITIONS AND STRATEGIES FOR ADAPTIVE CAPACITY” escrito por MELISSAWARD-SanDiegoState University;ANAK.SPALDING,Oregon StateUniversity;ARIELLELEVINE-San DiegoStateUniversity;ERIKAALLEN WOLTERS-OregonStateUniversity. La versión original, incluyendo tablas y figuras, fue publicada en MARZO de 2022 en OCEAN AND COASTAL MANAGEMENT Se puede acceder a la versión completa a través de https://doi.org/10.1016/j. ocecoaman.2022.106155

Patrick Waty, CEO de INVE Aquaculture. Una entrevista exclusiva para Panorama Acuícola Magazine

Patrick Waty, CEO de INVE Aquaculture, compartió con Panorama Acuícola Magazine su visión acerca del futuro de la acuicultura mundial durante los años por venir y el indiscutible aporte de la empresa al desarrollo y crecimiento de la industria.
 Por: Redacción de PAM*.
Por: Redacción de PAM*.
El crecimiento de la población y el consecuente aumento de los requerimientos de alimentos, ha hecho que las miradas se dirijan hacia a la actividad acuícola y su enorme potencial para contribuir significativamente como fuente sustentable de proteínas, siendo indispensable la coordinación de los esfuerzos de los distintos actores con la finalidad de dar respuesta a los retos que nos depara tanto el presente como el futuro. Con estas ideas en mente, Panorama Acuícola Magazine obtuvo una entrevista exclusiva con Patrick Waty, CEO de INVE Aquaculture, quien compartió con nosotros y nuestros lectores su visión acerca de la industria y el papel de la innovación en la sustentabilidad de la producción acuícola.
¿Cómo cree que se desarrollará la acuicultura en los próximos 5-10 años, en cuanto a especies y regiones?
Al respecto, Patrick nos ofrece su perspectiva: “En los próximos 5 años estimamos que la producción de camarones en el continente americano crecerá a un TCAC del 7% desde 1,590 millones de toneladas métricas (mt) en el 2022 hasta 2,200 mt en el 2027. En Sudamérica, esperamos que Ecuador lidere el
crecimiento, pasando de 1.2 mt en 2022 hasta 1.6 mt para el año 2027, así como un fuerte crecimiento en América Central, con la producción duplicándose en los próximos 5 años. En particular, Venezuela crece fuertemente gracias a exportaciones a la UE y su fácil acceso a terrenos en la cuenca de Maracaibo, y una industria que ¡crece a 30% anual! México crecerá más lento, a unos 2.5% y Brasil, aunque muestra buen crecimiento, seguirá siendo un productor pequeño con alrede-
dor de 0.09 mt en el 2022 y 0.105 mt en 2027”. Se muestra optimista la destacar que “Ecuador es el que está mejor preparado para crecer con un gobierno comprometido y varios productores importantes con buen acceso a capital. Los granjeros tienen menos desafíos o restricciones de acceso a terrenos y, lo más importante, ¡son rentables y crean capital! Nos gustaría ver un aumento proporcional de exportaciones a EE.UU. y la UE para reducir la dependencia de China”.
Al referirse a otras latitudes fuera del continente americano, el CEO de INVE Aquaculture señaló: “Esperamos un crecimiento lento en la industria del camarón, con un 2-3% anual en India, donde Penaeus monodon crecerá más rápido que Litopenaeus vannamei, aunque este último seguirá dominando la producción (94% en 2027). Esperamos que Vietnam muestre un buen crecimiento en Asia, mientras Tailandia continúa luchando para ser competitivo. Indonesia mostró buena resiliencia para enfrentar el aumento de ventas a los EE.UU. durante la pandemia del COVID-19, pero el consumo interno ha sido lento y aún persisten fuertes desafíos biológicos por enfermedades”.
En cuanto a Europa, y respecto al mercado de peces marinos, “consideramos que el crecimiento más significativo ocurrirá en Turquía con un 19% de aumento en la producción en los próximos 5 años. Estamos entusiasmados con los mercados emergentes en Omán y Medio Oriente, aunque su materialización no sea pronto y serán una pequeña proporción de la producción total”, dijo Patrick Waty.
¿Cómo se posiciona INVE Aquaculture para colaborar en el desarrollo y crecimiento de la acuicultura?
“El agua cubre un 60% de la superficie terrestre pero la acuicultura sólo
suministra un 2% del alimento mundial. No necesito decirle a usted, o a los lectores de Panorama Acuícola, que nuestra industria tiene un papel fundamental en el suministro de alimento a una creciente población mundial, ahora y en el futuro”, enfatizó. “Para nosotros, el único medio para darle forma a este futuro es hacerlo en cercana colaboración y asociación con el mercado. Al crear conciencia sobre la conversión de alimento, la calidad del producto final y la administración de sistemas, apuntamos a establecer metas cada vez más altas en los estándares para la cría de especies acuícolas. Hemos estado haciendo esto por 35 años, y seguimos igual de ambiciosos, y nuestra ansia de innovación, cooperación y profesionalismo es igual de fuerte ahora de lo que era cuando INVE se constituyó”.
Con presencia en 27 países, INVE Aquaculture se posiciona para estar presente en los principales focos de cambio de la acuicultura, con centros de I+D y equipos de apoyo técnico en toda Europa, Asia, América, el Medio Oriente y África, manteniendo su lugar en el mercado, “cerca de los clientes y con nuestras manos en el agua”, dijo el CEO de la empresa.

Basada en su misión de apoyar la producción de sistemas de acuicultura y el crecimiento comercial de nuestros clientes, INVE Aquaculture suministra soluciones innovadoras y sustentables, agregando valor en
puntos claves de los ciclos de cultivo. “Creemos que la calidad del alimento para reproductores y larvas tiene beneficios prolongados, que el manejo de la población microbiana es esencial desde hatchery hasta cosecha, y que las condiciones del ambiente de organismos bajo cultivo deben controlarse cuidadosamente”, puntualizó Patrick.
Al referirse al uso de Artemia, no duda en destacar que “revolucionó la acuicultura y ha contribuido de manera considerable al rápido desarrollo del sector”. En la actualidad, la Artemia aún es un componente importante y crítico en los protocolos, razón por la cual la industria tendrá que aceptar el desafío de usarla tan eficientemente como sea posible, para que la acuicultura crezca utilizando la oferta limitada de Artemia de la naturaleza. De allí que Patrick destacó: “Esto requiere conocimientos adecuados y estrategias de aplicación. El desarrollar nuevos productos y tecnologías relacionadas con Artemia y compartir las innovaciones y conocimientos con los clientes, ayudará a la industria a crecer”.
En esta línea de acción, mantener información específica relacionada con alimentos vivos en las mismas instalaciones del hatchery, es importante para el futuro, y la posibilidad de contar con especialistas técnicos de INVE Aquaculture, capaces de transferir este conocimiento a los nuevos planteles del hatchery, también ayudará a asegurar el futuro del sector.
Al abordar este punto, Patrick Waty se inspiró para detallar los factores clave que marcan las ventajas competitivas de la empresa en el
•
“Una de nuestras mayores diferencias es nuestra conexión con las otras divisiones del Benchmark Group. Estamos en el comienzo de una nueva etapa
“Esperamos un crecimiento lento en la industria del camarón, con un 2-3% anual en India, donde Penaeus monodon crecerá más rápido que Litopenaeus vannamei, aunque este último seguirá dominando la producción (94% en 2027).”
¿Cómo hace INVE Aquaculture para marcar diferencia de otras empresas que participan en los mismos mercados de acuicultura?
mercado:Patrick visitando nuestra sede en Tailandia.
de cooperación entre INVE y nuestros colegas de ‘Breeding and Genetics’, quienes están intentando combinar nuestras tecnologías en paquetes y protocolos genético-nutricionales a la medida para los clientes. Hay un enorme potencial de causar un impacto en la predictibilidad, consistencia y finalmente en la rentabilidad de la combinación de carteras, y nuevos sistemas de datos con los que estamos trabajando nos ayudarán a documentar y comprobar esto. Enfocarnos solo en INVE. La estrategia de enfocarnos en nuestra cartera nos diferencia de nuestros competidores. Tenemos expertos en la empresa en las tres disciplinas esenciales para la producción en acuicultura: optimización de la nutrición animal, manejo de salud animal y riguroso control del ambiente de cultivo. Combinado con más de 35 años de operaciones y experiencia técnica de campo, somos una de las pocas empresas que puede ofrecer prácticas de cultivo holísticas que cubran estos tres aspectos esenciales.
Una vez que un producto egresa de nuestro departamento de innovaciones, tenemos un completo control desde el uso de
materias primas de alta calidad, pasando por la manufactura en nuestras propias instalaciones en Asia y EE.UU., la distribución y, finalmente, el seguimiento in situ con nuestro equipo de Servicios Técnicos.
Nuestro compromiso con los clientes nos diferencia de nuestros competidores. Desde nuestras innovaciones y equipos, pasando por el departamento Comercial y el Operacional, hasta el de Soporte Técnico, todo lo que hacemos está diseñado para resolver los desafíos de los clientes y satisfacer sus necesidades. Tenemos un gran departamento de I+D con centros de investigación y pruebas en terreno, en los principales mercados de acuicultura. Nuestros clientes tienen acceso a expertos y equipos de soporte técnico (un equipo de consultores técnicos calificados) que puede entender sus necesidades y ayudar a resolver los problemas.
INVE Aquaculture ha sido, desde hace mucho tiempo, el punto de referencia para productos de hatchery de peces marinos. Nuestra estrategia está enfocada en suministrar productos de alta calidad que tienen un efecto positivo
prolongado sobre la fortaleza y rendimiento de los peces. Todos nuestros productos actuales y futuros son investigados y puestos a prueba en nuestro propio hatchery de peces marinos en Italia. Adicionalmente, tenemos un equipo de experimentados especialistas que se esfuerzan en perfeccionar los protocolos, adaptándolos a las condiciones locales para lograr la producción eficiente de alevines de calidad.”
¿Qué esperas del 2022 y qué te entusiasma del futuro de INVE Aquaculture?
Tratando de resumir todo cuanto planea realizar este año, Patrick nos habla de sus objetivos en tres aspectos principales:
“Personalmente, para el resto del 2022 espero viajar más y reunirme con más colegas, nuestros clientes y socios. Lo dije antes, pero INVE en realidad tiene su lugar en el mercado y por los últimos dos años hemos extrañado el contacto cara a cara y me alegro que eso se esté recuperando. Tan solo estas últimas dos semanas he visitado a nuestro equipo y clientes en Tailandia, y es fantástico estar de vuelta en terreno, ¡y no siempre por Zoom!
En cuanto a la empresa, me entusiasma la posibilidad de extender nuestra cooperación con los colegas de Benchmark Genetics, y así unir nuestras tecnologías en paquetes y protocolos genético-nutricionales a la medida para los clientes. Hay un enorme potencial de causar un impacto en la consistencia, desempeño, resistencia a enfermedades y, finalmente, en la rentabilidad en la combinación de carteras.
A nivel de productos, en el área de Marine Fish (parte del departamento de Nutrición) acabamos de introducir una importante innovación: la nueva línea de alimentos “Natura pRo y ExL”,

diseñadas para reducir la necesidad de rotíferos de 50% sin impactar la supervivencia o calidad de las larvas, e incluso las mejoran. Me entusiasma ver el rendimiento de este producto en el mercado, durante los próximos meses”.
Con respecto a la sustentabilidad, ¿Qué hace INVE Aquaculture para contribuir a que la producción de la acuicultura sea más sustentable?
INVE Aquaculture entiende que la sustentabilidad no se trata solo de usar “ingredientes verdes” y embalajes reciclables. Se trata de extraer de los animales el máximo absoluto en los sistemas, con el mínimo de aportes, aplicando “los productos y protocolos correctos en el momento correcto y de la manera correcta para asegurar que cada animal logre el máximo potencial”. Además, solo colabora con socios que cumplen los mismos estándares de control de calidad, conformidad con normas, ética laboral y responsabilidad medioambiental.
Para cerrar con broche de oro esta entrevista, Patrick profundiza en las acciones que se están llevando adelante como muestra del compromiso de INVE Aquaculture con la sustentabilidad de la acuicultura, basado en su enfoque holístico en la prevención de enfermedades y manejo ambiental:

“Nuestro departamento de adquisiciones está ampliando la adquisición de productos de
fuentes sustentables con certificaciones de Marine Trust, ProTerra, Friends of the Sea, etc. La optimización de suministros y transporte es un proyecto en progreso.
Estamos en proceso de postular y cumplir con la certificación del Global Gap Compound Feed Manufacturing en todas nuestras instalaciones productivas. A pesar que la cartera de INVE Aquaculture se produce a los más altos estándares de calidad del mercado, queremos que sea certificado de manera oficial. No solo por el certificado mismo, sino porque implica que nuestros procesos han sido revisados por una fuente independiente.
Uno de nuestros mayores y más importantes productos (Artemia) es un recurso natural y, por eso, debe ser manejado de manera sustentable. Nuestras tecnologías e innovaciones han optimizado el uso y cosecha de Artemia, junto con hacer el proceso más seguro y con menos impacto sobre las poblaciones naturales. Estas innovaciones optimizadas y económicas (Artemia, SEPArt technology, D-FENSE) han simplificado la producción de Artemia, logrando que sea un alimento vivo conveniente y sustentable para peces marinos y camarones. En el área de cosecha de Artemia más importante del mundo –el Great Salt
Lake en Utah, EE.UU.– estamos involucrados en la iniciativa “Management of Artemia resources of the Great Salt Lake (Utah, USA)” (Manejo de los recursos de Artemia del Great Salt Lake), junto con los otros miembros de la Cooperativa del Great Salt Lake, el Consorcio Internacional de Artemia (IAAC) y miembros de los gobiernos estatal y nacional.
Permanentemente estamos invirtiendo en nuestras instalaciones productivas con el fin de producir de manera más eficiente y reducir residuos e impacto ambiental. Este año se instalará un panel solar en nuestra fábrica de Tailandia, con lo que un 30% de la electricidad total consumida por la planta vendrá de fuentes renovables.
Nuestra cartera de cultivo reúne soluciones preventivas, biocidas ecológicos y antimicrobianos naturales, soluciones de biorremediación de suelos y agua, promotores de fortaleza e inmunoestimulantes para apoyar la salud animal y acondicionadores de cultivo. Nuestro enfoque holístico en la prevención de enfermedades y manejo ambiental es clave en la producción sustentable de acuicultura, creemos que la prevención prevalece y es mucho más económica que cualquier tratamiento de emergencia o mitigación ciega”. Además, destacó que en junio de 2022, INVE se unió a la “Asociación para el Camarón Sostenible” (Sustainable Shrimp Partnership , SSP) en Ecuador, con el firme objetivo de “cambiar la percepción y el tratamiento del camarón de producto básico a producto de alta calidad”, junto a quienes “se ocupan de mejorar las prácticas de cultivo del camarón a lo largo de toda la cadena de producción para mejorar la calidad y el impacto ambiental y social”. Es así como produciendo camarones según los criterios autoimpuestos por la SSP para alcanzar los más altos estándares ambientales y sociales, el uso de cero antibióticos y el impacto neutro en el agua, “podemos asegurar un futuro sostenible para el sector del camarón de cultivo”, señaló Patrick para finalizar esta interesante entrevista con nuestro Director Salvador Meza.
La camaronicultura requiere de combinaciones nutricionales capaces de asegurar un adecuado nivel alimenticio para brindar el mejor rendimiento en crecimiento y supervivencia, justo el área en la que Zeigler® Bros., Inc. ha centrado sus esfuerzos para desarrollar productos como Z Pro, dieta larval optimizada en nutrientes para un desempeño superior.
 redacción de PAM*
redacción de PAM*
En los últimos años, el consumo y la producción de alimentos provenientes del mar se han incrementado debido al crecimiento de la población mundial. La cría de camarones tiene el potencial ideal para responder a las demandas de alimentación y nutrición de la humanidad. Debido a las asombrosas cifras de producción de camarón a escala global y exportación de los últimos 5 años, este se considera uno de los productos no petroleros de mayor exportación en el mercado internacional.
Los camarones tienen un ciclo de vida muy complejo, el cual va desde huevo, estadios larvarios (nauplio, zoea, mysis hasta postlarva), juvenil y adulto. Para cada una de estas etapas, el camarón tiene requerimientos nutricionales muy específicos, haciendo de suma importancia que el alimento proporcione tanto un balance óptimo de nutrientes, como un adecuado tamaño de partículas. Por tanto, la dieta debe suplir la necesidad de suministro de estructuras químicas apropiadas para desarrollar las funciones y mantener la salud de los camarones. Además, el crecimiento y el desarrollo idóneos durante cada etapa condiciona al
organismo a manejar las dificultades a enfrentar, a menudo, ambientes de crecimiento estresantes y desafiantes.
En este sentido, la elección del alimento es un factor clave para asegurar la salud y el tamaño esperado en la cría de especies para consumo humano. En el caso particular de la camaronicultura, se requiere de combinaciones nutricionales capaces de asegurar un adecuado
nivel alimenticio para brindar el mejor rendimiento en crecimiento y supervivencia, los cuales se reflejen en resultados de cosecha con una mejor conversión alimenticia y menor mortalidad.
Desde principios de la década de 1980, Zeigler® ha estado muy involucrado con la ciencia detrás de la nutrición de alimentos para camarones y el desarrollo de productos. Identificando y buscando
soluciones a los problemas clave de la industria y desafiando las prácticas obsoletas, la empresa sigue desempeñando un papel central en el progreso de esta industria. A través de estrechas relaciones de trabajo con socios comerciales e instituciones de investigación líderes, Zeigler® ha cimentado su posición como pionero en la industria de cultivo de camarón y continúa liderando nuevos avances tecnológicos que apoyan la sostenibilidad, la seguridad y, sobre todo, la productividad general de la camaronicultura.
Zeigler® desarrolla productos innovadores para la industria de producción de camarón
La empresa Zeigler® fue fundada en 1935, originalmente como un productor local de alimentos para aves y ganado. A partir de 1967, cambió su dirección estratégica hacia la investigación y desarrollo de dietas acuáticas, desarrollando tecnologías nuevas e innovadoras para mercados especializados. En la actualidad, elabora más de 300 productos y exporta a más de 50 países de todo el mundo. Cuenta con dos plantas de fabricación ubicadas en el centro-sur de Pensilvania y cinco asociaciones ubicadas en América Latina, Egipto e India.
Entre sus áreas de investigación, desarrollo y producción está la
acuicultura de camarones, campo que ha avanzado enormemente, permitiendo un aumento sustancial de producción total de camarones a escala mundial. A partir de sus competencias en investigación y desarrollo, formulación nutricional e ingeniería de procesos, la empresa Zeigler® desarrolla innovadores productos para dietas acuáticas de camarón en sus diferentes etapas de producción, entre las que se encuentra Z Pro Dieta Seca Superior para Larvas, para la cría de camarones en etapa larval.

Z Pro: Dieta Seca Superior para Larvas
Z Pro forma parte de los productos de Zeigler® para el periodo de producción de Laboratorio. Es el periodo de producción más temprano y sensible, que abarca el cultivo de larvas, nauplios y zoea, a través de mysis y las primeras fases postlarvales (PL). Durante este periodo crítico de metamorfosis se desarrolla la estructura del cuerpo del organismo, impactando a largo plazo su potencial crecimiento. La nutrición óptima en la etapa de incubación es crítica, teniendo un mayor impacto general en todo el ciclo de vida que en cualquier otra fase de crecimiento. Los alimentos secos para larvas como Z Pro han demostrado proporcionar la mejor nutrición para una cría exitosa de camarones en esas fases.
9 Ingredientes altamente digestibles y atractivos para promover un rápido consumo y crecimiento.
9 Formulado y fabricado para maximizar la eficiencia de las proteínas y la calidad del agua.
9 Contiene Vpak (Vitality Pak) para mejorar la salud de los organismos y resistencia a las enfermedades.
9 No contiene proteínas de animales terrestres.
9 Dieta con nutrientes optimizados para proporcionar un desempeño superior en sistemas de cría de larvas y PL.
9 Bioseguro y certificado libre de patógenos de camarón.
9 Desarrollado y probado en sistemas de cría de larvas en el Centro de Investigación de Acuacultura Zeigler® (ZARC).
9 Conservado con nitrógeno y en empaques a prueba de manipulaciones para la seguridad y estabilidad del producto.
Una formulación nutricionalmente balanceada, con alta digestibilidad de productos de proteína animal de origen marino, proteínas vegetales (incluidas algas), levadura, aceites de pescado y vegetales, almidones vegetales, premezclas de minerales y vitaminas, antioxidantes, pigmentos y aglutinantes biodegradables (Tabla 1).
A través de estrechas relaciones de trabajo con socios comerciales e instituciones de investigación líderes, Zeigler® ha cimentado su posición como pionero en la industria de cultivo de camarón.

Zeigler® Bros., Inc., líder mundial en investigación, desarrollo y producción de soluciones nutricionales para la acuicultura, ha basado su posición como pionero en la industria de cultivo de camarón en sus estrechas relaciones de trabajo con socios comerciales e instituciones de investigación. En este sentido, se enfoca en nuevos avances tecnológicos que apoyan la sostenibilidad, la seguridad y, sobre todo, la productividad general de la camaronicultura. La dieta balanceada Z Pro Dieta Seca Superior para Larvas, ha sido desarrollada para asegurar resultados de desempeño que pueden transformar positivamente la producción en el cultivo de camarones en la etapa larval, mediante una combinación innovadora de compuestos en su formulación.

9 El almacenamiento refrigerado o congelado extenderá la vida útil.
9 Cerrar bien las latas abiertas y almacenarlas a una temperatura de 0°C (32°F) o inferior.
9 Rotar el inventario de modo que se utilice primero el producto más viejo (PEPS).
La versión informativa del artículo original está patrocinada por: ZEIGLER BROS., INC.
Esta es una versión resumida desarrollada por el equipo editorial de Panorama Acuícola Magazine del artículo “Z
de aplicación y almacenamiento de Z Pro
Z Pro es una dieta Premium para larvas diseñada para alimentar a los camarones en los estadios desde mysis hasta postlarval, en cuyo uso se recomienda:

9 Utilizar dentro de los veinticuatro (24) meses desde la fecha de fabricación.
9 Almacenar en un lugar fresco y seco, bien ventilado y sin exposición al sol.
El tamaño de partículas del producto es de 150 micrones de mysis
3 a PL 5, 250 micrones para PL 5 a PL 8 y 350 micrones desde PL 8 a PL 15; distribuidos en los siguientes empaques:
9 Latas envasadas con nitrógeno de 500 gramos (1.1 lb), 12 por caja, para tamaño de partículas de 150 micrones.
9 Bolsa envasadas con nitrógeno de 4 kg (8.8 lb), 3 por caja, para tamaños de partículas de 250 y 350 micrones.
PRO DIETA SECA SUPERIOR PARA LARVAS - UNA DIETA LARVAL OPTIMIZADA EN NUTRIENTES PARA UN DESEMPEÑO SUPERIOR” escrito por ZEIGLER® BROS., INC. La versión original fue publicada en https://www.zeiglerfeed.com. Se puede acceder a la versión completa, incluyendo tablas y figuras, a través de https://www.zeiglerfeed.com/ shrimp/laboratorio/z-pro/; https:// www.nutrimar.mx/_files/ugd/5003b5_ b2fd2ac5085f4182a6d29a75f298157c.pdf (ficha técnica)
INFORMACIÓN DE LA EMPRESA
Zeigler Bros., Inc. 400 Gardners Station Road Gardners, PA 17324 USA www.zeiglerfeed.com info@zeiglerfeed.com

ActiTuna es un producto fabricado en Ecuador desde agosto del 2013, mediante un riguroso proceso de transformación de las vísceras de atún, transformándolas en un producto funcional con una alta proporción de péptidos bioactivos y otros compuestos nitrogenados de bajo peso molecular, de gran importancia en el cultivo de especies acuícolas como el camarón.
Las innovaciones sostenibles están impulsando el desarrollo de la industria de la acuicultura y, en especial, la formulación de alimentos acuáticos.
La tendencia iniciada hace 30 años sobre la reducción en la inclusión de harina de pescado (FM, por sus siglas en inglés) en las fórmulas, ha llevado a los fabricantes de alimentos a encontrar nuevas materias primas alternativas. En tal sentido, se hace necesario investigar sobre la optimización y la eficiencia de estas, siendo parámetros claves la determinación de su origen (trazabilidad), características (propiedades físicas y bioquímicas), rendimiento (palatabilidad, digestibilidad) y proceso de fabricación.

Los coproductos resultantes del procesamiento de alimentos y mariscos para consumo humano son fuentes valiosas de materias primas, siempre que se garantice la frescura y la consistencia de la cadena de suministro: atún, tilapia, calamar, camarón, pescado blanco y bases de pollo se encuentran entre las fuentes más comunes. Si el proceso de fabricación de harina domina hoy la valorización de dichos coproductos del mar, el proceso de hidrólisis puede considerarse como una mejor alternativa para generar nuevas funcionalidades como una mayor pala-
tabilidad, digestibilidad y bioactividad de los productos terminados, es decir, hidrolizados funcionales.
ActiTuna es un hidrolizado de proteína funcional
Los hidrolizados funcionales se obtienen mediante la hidrólisis enzimática de materias primas proteicas. Los –muy específicos– equipos utilizados por Symrise Aqua Feed, combinados con el alto nivel de control durante el proceso, garantizan productos estandarizados con un rendimiento constante en cada lote, contrario a muchos otros pro-
cesos y sus productos resultantes. La caracterización de los hidrolizados funcionales aporta información para evaluar su rendimiento y niveles de estandarización. El rendimiento del producto está íntimamente ligado a su perfil peptídico, donde cantidad, tamaño y diversidad de estos son esenciales para predecir la respuesta de los organismos que consumen hidrolizados funcionales a través de la dieta. Un cambio en el perfil peptídico conducirá a la desviación en el rendimiento del producto, ya sea en términos de palatabilidad, digestibilidad o bioactividad.
ActiTuna es un producto fabricado en Ecuador desde agosto del 2013, mediante un riguroso proceso de transformación de las vísceras de atún, provenientes de la industria atunera ecuatoriana y que, de lo contrario, serían descartadas y/o subutilizadas. Contando con una amplia experiencia de más de 9 años en el control de calidad de la materia prima, molienda e hidrólisis enzimática, Symrise Aqua Feed transforma estas materias primas de “bajo valor” en un producto funcional con una alta proporción de péptidos bioactivos y otros compuestos nitrogenados de bajo peso molecular, de gran importancia en el cultivo de especies acuícolas tales como el camarón blanco, especie de la que Ecuador es el primer productor de América Latina.
Symrise Aqua Feed se caracteriza por ser el único productor de hidrolizados en Ecuador con un enfoque científico y, por ende, el único capaz de respaldar sus argumentos de venta con resultados de ensayos, tanto in vitro como en campo.
Esta “nueva generación” de ingredientes funcionales muestran múltiples beneficios para los fabricantes de alimento: mejora y estandariza el rendimiento, reemplaza materias primas que muestran una calidad impredecible, ayuda a equilibrar los compuestos nitrogenados de bajo peso molecular (nucleótidos y péptidos), particularmente, en dietas bajas en harina de pescado, permite
desarrollar segmentos específicos de alimentos y garantiza la trazabilidad para acuicultores y fabricantes.
Desafíos críticos enfrentados por la industria camaronera Una encuesta realizada por Rabobank en 2020 a la industria camaronera, confirmó los dos principales desafíos que debe enfrentar la industria, el costo del alimento y enfermedades del camarón, cuyas pérdidas globales se estiman en $ 1 billón anual (Flegel et al., 2008). Solo Asia reportó pérdidas anuales de $ 4 mil millones durante el período de 2009 a 2018 debido a enfermedades (Shinn et al., 2018), es decir, aproximadamente el 15% del valor de su producción anual.
La tasa de crecimiento, a través del consumo de alimento y el bienestar de los camarones, también puede verse comprometida por las condiciones ambientales cuando los cambios de temperatura o salinidad son abruptos, o cuando la turbidez del agua está cambiando. Unas limitadas tasas de crecimiento e ingesta de alimento afectarán de forma directa el rendimiento del camarón (biomasa cosechada) e indirectamente el estado de salud de los organismos, reduciendo la resistencia a enfermedades, requiriendo ciclos de producción más largos y bajo condiciones sanitarias desfavorables.
Con más de 10 años de experiencia, Symrise Aqua Feed ha reali-
zado cientos de ensayos para desarrollar y analizar diversos hidrolizados funcionales, tanto en sus propias instalaciones de prueba (Aqualis), como con socios, evaluándolos con diferentes especies y bajo diferentes condiciones de prueba. Los siguientes datos brindarán información general del desempeño de ActiTuna y los beneficios específicos en tasa de crecimiento, a través de una mayor ingesta o asimilación de alimento, resistencia a los desafíos infecciosos y mejor supervivencia resultante, entre otros.
Entre las muchas bioactividades diferentes que se encuentran en los péptidos marinos, los antimicrobianos pueden encontrar una aplicación muy interesante en los camarones. Los péptidos antimicrobianos podrían mejorar la resistencia a enfermedades de los camarones alimentados con una dieta que los incluye, gracias al fortalecimiento de la salud no específica, así como a la modulación de la microbiota, reduciendo la carga relativa de bacterias patógenas, como las cepas de Vibrio, en la población de bacterias.
Para demostrar el rendimiento antimicrobiano de ActiTuna, se realizaron ensayos in vitro después de una separación del hidrolizado en 30 fracciones peptídicas diferentes en función de su peso molecular (HPLC, por sus siglas en inglés).

Cada fracción de hidrolizado/péptido se probó en 4 soluciones de cultivo diferentes de cepas bacterianas, responsables de las principales enfermedades acuícolas. Después de 6 horas, se leyó la absorbancia para determinar si esta fracción peptídica había dado como resultado el crecimiento o la inhibición de bacterias. Los resultados presentados en la Figura 1 demuestran la presencia de los péptidos antimicrobianos en ActiTuna efectivos contra distintos patógenos.
Más del 90% de la proteína de ActiTuna está compuesta por péptidos con un peso molecular inferior a 1,000 Da. Acabamos de demostrar que tales péptidos pueden generar bioactividades como las antimicrobianas. Además, los péptidos de bajo peso molecular y los aminoácidos libres también están involucrados en la atractibilidad y palatabilidad, así como en la digestibilidad del alimento.
Metaanálisis de las investigaciones de Symrise Aqua Feed sobre los usos de ActiTuna en dietas para camarón
De 2011 a 2020, Symrise Aqua Feed ha implementado 22 ensayos con ActiTuna en formulaciones dietéticas para camarón; 14 de ellos para
la sustitución de recursos marinos sobreexplotados (harina de pescado o calamar), mientras los otros 8 se centraron en suplementación de ActiTuna (3% en promedio, desde 6% en dietas para larvas a 2% en dietas de engorde) en formulaciones comerciales existentes, preferiblemente por su inclusión en las matrices de alimentación.

Los resultados de tales ensayos se consolidan en la Tabla 2, en la cual se incluye un indicador en color que ilustra la tendencia de los resultados de cada ensayo y cifras en negrita que muestran los valores de rendimiento promedio para cada ámbito de uso: harina de pescado/ sustitución de harina de calamar con ActiTuna combinado con materias primas de origen vegetal o suplementos de ActiTuna (y el resto de materias primas de la fórmula del alimento). Además del tema de las investigaciones, hemos distinguido como factores experimentales: condiciones experimentales, tipo de instalaciones de crianza y tipo de proceso implementado para preparar las dietas experimentales. Con el fin de normalizar los indicadores de rendimiento obtenidos bajo diferentes condiciones de crianza o dieta, hemos decidido basar nuestro análisis en el aumento/reducción relativo del rendimiento observado entre
las dietas ActiTuna y sus controles, expresado en porcentaje.
En ambas situaciones, la tendencia global confirma que el uso de ActiTuna conduce a un mejor rendimiento del camarón, con una reducción del promedio del factor de conversión alimenticia (FCR, por sus siglas en inglés) y un aumento de los parámetros de crecimiento, supervivencia y rendimiento. Sin embargo, parece obvio que las ganancias de rendimiento observadas son mucho mayores cuando el alcance de la investigación fue la suplementación frente a la sustitución de los recursos marinos sobreexplotados, ya que, para el último, el objetivo es alcanzar, al menos, el mismo rendimiento que la dieta control con más harina de pescado y/o harina de calamar. Por ejemplo, en promedio, las diferencias de rendimiento obtenidas entre las dietas de ActiTuna y sus controles fueron del 14 % en el caso de la suplementación con ActiTuna frente al 5 % en el caso de los estudios de sustitución de harina de pescado/calamar.
Un ANOVA de 2 vías realizado sobre estos factores y variables zootécnicas confirmó que solo el alcance de las investigaciones (Factor: tema) había tenido un impacto significativo en las diferencias observadas entre estos ensayos in vivo (Tabla
2), sin cuestionar el resultado positivo de la sustitución de las harinas marinas por proteínas vegetales e hidrolizado funcional ActiTuna. Esto puede sonar obvio, pero experimentamos y demostramos de manera consistente que es posible mantener la productividad del cultivo de camarón, e incluso aumentarla, sin depender necesariamente de los recursos marinos sobreexplotados, siempre que los requisitos nutricionales de la dieta de camarón se cumplan.

Otra información clave de este metaestudio y el análisis ANOVA de 2 vías, es que en ambas condiciones de uso, reemplazo o suplementación, las tasas de supervivencia fueron similares, es decir, no significativamente diferentes. Esto indica que la potencia de ActiTuna como ingrediente que mejora la salud no fue matizada por el reemplazo de los recursos marinos sobreexplo-

tados. Por último, es reconfortante observar que tanto el proceso de fabricación de las dietas y el tipo de instalaciones, no influyeron estadísticamente en las tendencias observadas bajo las diferentes condiciones evaluadas en el estudio.
Conclusiones: ActiTuna como ingrediente rentable para mejorar el rendimiento en la formulación de alimentos para camarón
Esta revisión ilustró el proceso de desarrollo y evaluación de ingredientes novedosos implementados por Symrise Aqua Feed para satisfacer las necesidades de la industria del camarón, en términos de soluciones rentables que mejoran el rendimiento y la productividad del camarón. Estos resultados demostraron su estrecha relación con mejores tasas de supervivencia del camarón, aumento directo de la biomasa cosechada, al
tiempo que se reduce el costo de producción debido al alimento.
En nuestros estudios, hemos correlacionado la tendencia positiva en términos de rendimiento de la salud del camarón tanto en condiciones de campo, con en ensayos de laboratorio in vitro e in vivo, demostrando que ActiTuna estimula las defensas inmunitarias del camarón o la potencia antimicrobiana contra los principales patógenos bacterianos de la acuicultura. Los investigadores saben que los ensayos in vivo, especialmente con camarones, pueden estar sujetos a sesgos impredecibles y/o desconocidos, dando lugar a resultados inesperados. Solo el análisis de metaestudio, después de varias repeticiones en diferentes condiciones ambientales, puede proporcionar conclusiones consistentes y confiables sobre la eficacia y eficiencia de nuevas soluciones dietéticas .
Información y ventas contactar a Eduardo Hurel. Teléfono: +593 981 696 086, email: eduardo.hurel@symrise.com

La harina de pescado es actualmente la principal fuente de proteínas en los alimentos para peces, pero su disponibilidad limitada se ve afectada por muchos factores, por lo que estudiar los efectos de la inclusión de otros ingredientes como la harina de subproductos avícolas en la dieta de dorada, es de especial importancia para la acuicultura moderna.
 Por: Redacción de PAM*
Por: Redacción de PAM*
El crecimiento de la acuicultura en la última década y el consumo mundial de peces de cultivo ha ido en aumento. El alimento es uno de los principales costos en la acuicultura, por lo que es muy importante comprender el efecto de las estrategias de nutrición en la calidad y la comercialización de filetes de pescados de cultivo. La harina de pescado (FM, por sus siglas en
inglés) es actualmente la principal fuente de proteínas en los alimentos para peces, pero su disponibilidad limitada se ve afectada por muchos factores, tales como el cambio climático. En consecuencia, la sustitución de FM es un importante desafío para los proveedores de alimentos para peces y ha estimulado a los nutricionistas e investigadores a encontrar fuentes de proteínas sostenibles, eficaces y más económicas.
La harina de subproductos avícolas (PBM, por sus siglas en inglés) es considerada como una proteína alternativa adecuada en dietas artificiales para especies acuícolas carnívoras y omnívoras, debido a su alto volumen de producción, composición nutricional, precio y ventajas de suministros frente a la harina de pescado. De acuerdo con la Asociación Estadounidense de Oficiales de Control de Alimentos

(AAFCO, por sus siglas en inglés), la PBM consiste en partes limpias, procesadas y molidas de la carcasa de aves sacrificadas, tales como pescuezo, patas, huevos no desarrollados e intestinos, excepto las plumas.
La PMB se usa habitualmente en la nutrición del ganado, en particular en la nutrición porcina. Su demanda está aumentando en la industria de alimentos acuícolas y distintos autores han confirmado que tiene un potencial considerable como ingrediente de alimentos en los sistemas de producción de peces. Algunos estudios han demostrado que la PBM podría reemplazar el 75% o, incluso, el 100% de la harina de pescado sin una disminución significativa en su crecimiento. El objetivo de este estudio fue investigar acerca de la inclusión de la PMB en la nutrición de la dorada (Sparus aurata) y sus efectos sobre el crecimiento, la fisiología del sistema digestivo y la calidad del producto final de esta especie.
En las pruebas, es utilizaron una dieta control (dieta comercial) y dos dietas experimentales, Alimento A y Alimento B con contenidos de PBM al 50 y 100% de sustitución de FM respectivamente (Tabla 1). Todas las dietas fueron isoproteícas 45% e isolipídicas 20% (Tabla 2). El ensayo de crecimiento duró 110 días, incluidas 2 semanas de aclimatación de los peces. Los juveniles de dorada con un peso medio inicial de 73.57 ± 10.47 g, se distribuyeron aleatoriamente en 9 tanques (3 repeticiones por dieta), alimentados una vez al día manualmente (tasa de alimentación del 1%). El muestreo se realizó con una frecuencia mensual.


Rendimiento del crecimiento e índice somático
El peso corporal promedio inicial fue de 73.57 ± 10.47 g y se incrementó en forma constante en todos los grupos experimentales (Figura
1). Al final de la prueba, todos los peces mostraron un peso similar (sin diferencias estadísticas). Tampoco se encontraron diferencias estadísticas en la longitud final entre todos los grupos de peces (Figura 2). Los resultados reportados demuestran que la sustitución de harina de pescado por la harina de subproductos de aves en las dietas de doradas juveniles no afecta significativamente el crecimiento de los peces en términos de peso y longitud. Los parámetros productivos de los grupos experimentales de peces, tanto de la dieta control como en las experimentales fueron similares.
La sustitución de harina de pescado por PBM en la dieta no afecta significativamente (p > 0.05) el cortisol, los niveles de proteínas, la osmolalidad, actividades de alanina aminotransferasa y aspartato aminotransferasa en el plasma de los peces. No se encontraron diferencias estadísticamente significativas entre los grupos experimentales con respecto a la fosfatasa alcalina hepática. Al final del ensayo, las actividades enzimáticas intestinales mostraron valores similares en todos los grupos experimentales.
Se realizó un análisis proteómico de filetes de los peces para evaluar el efecto de las diferentes dietas experimentales en el proteoma.
El análisis de imágenes utilizando “Image Master 2D Platninum” en los músculos de los peces reveló de 700 a 800 puntos. No se encontraron diferencias estadísticas en el número total de manchas entre los grupos de peces al final de la prueba (743 ± 22, 751 ± 14 y 756 ± 18, en el grupo control, Alimento A y Alimento B, respectivamente).
Los resultados demostraron que el perfil de aminoácidos en el músculo de la dorada es similar en los peces alimentados con Alimento A, Alimento B y en aquellos alimentados con la dieta control, con la excepción de la alanina, tirosina y treonina.

La concentración de lípidos aumentó al final de la prueba de crecimiento en todos los grupos experimentales y no se detectó
ninguna diferencia estadística en el contenido graso del filete. El análisis de fosfolípidos no reveló diferencias entre los grupos experimentales. El colesterol total en el músculo de la dorada aumentó casi linealmente durante la prueba de crecimiento. Sin embargo, no se encontraron diferencias estadísticas entre los grupos de peces.
La PBM es considerada una alternativa apropiada para el alimento de peces, especialmente porque tiene algunas características nutricionales comparables a la harina de pescado; y se ha comprobado en la dieta de muchas especies de peces en acuicultura. Algunos investigadores se han centrado en el valor nutricional de este ingrediente (composición, contenido de aminoácidos y ácidos grasos) y en su efecto sobre el crecimiento de los peces.
Los resultados confirman que los alimentos que contenían PBM
(50% y 100%) usados durante la prueba no mostraron ningún efecto negativo en el crecimiento de los peces. Estos hallazgos confirman los de Alexis (1997), quien demostró que la inclusión de 75% y 100% en la dieta de S. aurata condujo a resultados productivos similares a los peces alimentados con harina de pescado. La capacidad de PBM para sustituir a la harina de pescado también está respaldada por la observación de que todos los parámetros productivos medidos en este experimento (crecimiento específico, ganancia de peso promedio, factor de condición, índice viscerosomático e índice hepatosomático) fueron similares en todos los grupos experimentales.
El cortisol hemático es un parámetro comúnmente utilizado para evaluar el bienestar de los peces y proporciona una buena indicación de la intensidad y duración del estrés en la dorada (Jentoft et al., 2005; Syriou et al., 2011). El resultado del estudio sugiere claramente que la dieta basada en PBM no determina, per se, el estrés en esta especie de pez. En el experimento, alrededor de 90% de las muestras de hígado se clasificaron como hígado sano (Grado 1). Solo unas pocas muestras mostraron displasia nuclear (independientemente de los tratamientos experimentales), mientras que no se observó vacualización, esteatosis ni degradación de los hepatocitos.

Diversos estudios han demostrado que el perfil de ácidos grasos del tejido de peces refleja la composición de ácidos grasos de la dieta (Maina et al., 2003; Francis et al., 2006; Xue et al., 2006; Bahurmiz y Neg, 2007; Gümüş y Erdogan, 2010; Hu et al., 2013). Los peces marinos no pueden producir ácidos grasos altamente insaturados (HUFA, por sus siglas en inglés). La historia dietética de los peces de cultivo también puede influir en su composición lipídica (BeneditoPalos et al., 2009).
Sin embargo, en el estudio se observaron diferencias considerables en el perfil de ácidos grasos
La sustitución de harina de pescado por la harina de subproductos de aves en las dietas de doradas juveniles no afecta significativamente el crecimiento de los peces en términos de peso y longitud.
Para promover un futuro realmente sostenible para la acuicultura, es de prioritaria importancia demostrar que la investigación y la industria de los alimentos acuícolas puedan compartir el mismo objetivo de sostenibilidad,
del músculo de peces alimentados con la dieta PBM con respecto a la dieta control. Los resultados arrojaron un alto nivel de ácidos grasos monoinsaturados (40-45%) y un nivel relativamente bajo (31-36%) de ácidos grasos poliinsaturados (PUFA, por sus siglas en inglés). El ácido oleico (C18:1n-9), el ácido palmítico (C16:0) y el ácido linoleico (C18:2n-6) representan los principales ácidos grasos. Se encontraron resultados similares en dorada de cultivo (Valente et al., 2011).
En el presente estudio, el contenido de fosfolípidos en el músculo de la dorada no se vio afectado por la composición de las dietas en todos los grupos de peces. A los 90 días de prueba, el porcentaje de ácido eicosapentaenoico EPA del total de ácidos grasos en el músculo de la dorada, ni los fosfolípidos, se vieron afectados por la PBM entre los grupos de peces.

El estudio claramente comprobó que la PBM se puede emplear en la alimentación artificial de doradas, demostrando así que no hay efecto negativo ni fisiológicos o subpatológico y en las condiciones de bienestar de los peces de cultivo. Este resultado tiene un efecto inmediato en la industria de alimentos acuícolas, mostrando la posibilidad de su uso en la alimentación artificial de las principales especies de peces de la acuicultura mediterránea.
En términos generales, la investigación también confirma que una industria de alimentos acuícolas basada en alimentos disponibles localmente beneficiará a todo el sector acuícola, lo que demuestra que la reutilización de subproductos, como el caso de PBM, es un buen ejemplo de economía circular, un concepto que es familiar para los consumidores modernos. La experiencia positiva del salmón del Atlántico en Noruega, ícono de la piscicultura carnívora en el norte de Europa, debería trasladarse a las especies carnívoras vicariantes de la región del Mediterráneo, como la
dorada, y a una futura sustitución masiva de la harina de pescado lo que reducirá en gran medida el impacto medioambiental y, en consecuencia, el impacto social de este sector, considerando que esta especie probablemente dominará la piscicultura en toda la región mediterránea.

Para promover un futuro realmente sostenible para la acuicultura, es de prioritaria importancia demostrar que la investigación y la industria de los alimentos acuícolas puedan compartir el mismo objetivo de sostenibilidad, como se muestra en este estudio en el cual la experimentación “en el campo” se ha llevado a cabo completamente en una piscifactoría privada, y lo que es más importante, compartiendo un claro objetivo de mejorar la sostenibilidad del cultivo de dorada.
Las estimaciones de la FAO muestran que la piscicultura de carnívoros aumentará en Europa y en la región del Mediterráneo. Las especies de peces carnívoros son tradicionalmente las más criticadas por la opinión pública y los medios de comunicación por su impacto indirecto sobre los recursos naturales, por el consumo de harina de pescado. Resultados como los obtenidos en este estudio muestran de manera clara que la acuicultura moderna aprovecha de
inmediato las oportunidades, como en este caso de utilización de PBM en Italia, que el concepto de economía circular tiene en la acuicultura moderna y que es posible un futuro diferente para los peces más importantes. de la actividad acuícola de la región mediterránea.
Esta es una versión resumida desarrollada por el equipo editorial de Panorama Acuícola Magazine del artículo “POULTRY BY-PRODUCT MEAL AS AN ALTERNATIVE TO FISH MEAL IN THEJUVENILEGILTHEADSEABREAM(SPARUS AURATA)DIET”escritoporM.SABBAGHUniversityofSalento;R.SCHIAVONE-University ofSalento;G.BRIZZI2-ChlamysSrl;B.SICURO -UniversityofTorino;L.ZILLI-Universityof SalentoyS.VILELLA-UniversityofSalento. La versión original, incluyendo tablas y figuras, fue publicada en JUNE de 2019 en APERTO - ARCHIVIO ISTITUZIONALE OPEN ACCESS DELL’UNIVERSITÀDITORINO.Se puede acceder a la versión completaa través de DOI:10.1016/j. aquaculture.2019.734220

alternativa natural a los antioxidantes sintéticos para la conservación de los alimentos acuícolas
Los antioxidantes son ampliamente utilizados en la acuicultura actual, por su capacidad de limitar el efecto del estrés oxidativo. Laboratoires Phodé ha desarrollado su nuevo rango Olpheel, incluyendo el producto Olpheel Anti-Ox, el cual ha demostrado ser una alternativa natural eficiente a los antioxidantes sintéticos y a la etoxiquina para preservar los alimentos extruidos de la oxidación.
Por: Laboratoires Phodé.Los antioxidantes son ampliamente utilizados en la acuicultura actual. Estos compuestos tienen la capacidad de limitar el efecto del estrés oxidativo, que es la consecuencia del alto metabolismo del oxígeno dentro del cuerpo de los animales, provocando la aparición de especies reactivas de oxígeno (ROS, por sus siglas en inglés, también llamados radicales libres). Estos últimos interfieren en la señalización celular y en los tejidos, provocando daños y disfunciones en el interior de los organismos. Los antioxidantes también se incluyen de forma natural en los alimentos para evitar su oxidación y degradación, manteniendo la calidad de los compuestos de los alimentos al máximo. Debido a la alta exposición al oxígeno y a los ROS, los antioxidantes eliminan esos radicales libres y los reducen dándoles un átomo de hidrógeno. Estos nuevos compuestos reducidos no causan daños al alimento y los antioxidantes oxidados tienen un efecto muy disminuido comparado a los radicales libres.
La European Food Safety Authority (EFSA) recién suspendió el uso de la etoxiquina como anti-
oxidante y, en consecuencia, la industria busca soluciones alternativas para producir alimentos acuáticos de alta calidad con productos más sostenibles en comparación con los antioxidantes sintéticos.
Se sabe que los polifenoles son moléculas antioxidantes muy eficaces gracias a sus grupos fenólicos. Entre las fuentes naturales de polifenoles, los extractos de semilla y la piel de uva son muy utilizados, ya que contienen un alto contenido de polifenoles, en particular taninos condensados. Entre los taninos condensados, las procianidinas, y más concretamente las oligo-procianidinas (OPC), son uno de los antioxidantes más potentes que se conocen.
El objetivo de este estudio, llevado a cabo en el centro de experimentación Innocon en Chile, fue evaluar el potencial de un insumo alimenticio rico en OPC, Olpheel Anti-Ox, en la conservación de los alimentos contra la oxidación.
Para evaluar el efecto antioxidante de Olpheel Anti-Ox (OAO), se llevó a cabo un ensayo de oxidación acelerada del alimento. Consistió en someter un alimento extruido a una temperatura de 90°C y 6 bares
de oxígeno durante 18 horas en un equipo Oxitest®. Con ello, se determinó el tiempo de inducción, el cual corresponde al tiempo necesario para que comiencen a producirse las reacciones primarias de oxidación de la grasa en la muestra; cuanto más largo sea este tiempo, más resistente es la matriz alimenticia contra la oxidación.

Para medir la eficacia del antioxidante, se han evaluado 4 tratamientos
9 Control -: alimento sin antioxidantes.
9 Control +: alimento control + 500 ppm de TBHQ (butilhidroquinona terciaria) + 300 ppm de BHT (hidroxitolueno butilado) + 1,300 ppm de Vitamina E.
9 OAO 50 ppm: alimento control + Olpheel Anti-Ox incluido a 50 ppm.
9 OAO 125 ppm: alimento control + Olpheel Anti-Ox incluido a 125 ppm.
En cuanto a la oxidación del alimento (Figura1), los resultados tanto a 50 como a 125 ppm de Olpheel Anti-Ox mostraron resultados similares (6.47 y 6.18 horas respectivamente para el inicio de
la oxidación) comparado al control positivo (6.67 horas, mezcla de antioxidantes sintéticos), mostrando un mayor efecto en la conservación del alimento superior al control negativo sin ningún antioxidante.

Para profundizar estos resultados primarios, se evaluó en un segundo ensayo el efecto de Olpheel AntiOx en la vida útil del alimento tipo extruido, y se realizó otro análisis de oxidación en Oxitest® a 90, 100 y 120°C, determinando el tiempo de inducción a estas temperaturas con una presión de oxígeno de 6 bar. Como no hubo diferencias significativas entre los resultados de 50 ppm y 125 ppm, la dosis de 50 ppm se ha considerado la mejor en cuanto a rentabilidad. Para llevar a cabo esta segunda prueba, se eligió una dosis de 30 ppm para ser probada, con


el fin de probar que las dosis bajas también podían ser eficientes.
Los valores del tiempo de inducción a 90, 100 y 120°C obtenidos por el segundo Oxitest® se representaron gráficamente y se calculó la vida útil del alimento de tipo extruido a 25°C por extrapolación de la curva. Para lograrlo se utilizó el software Oxisoft® del equipo Oxitest®

Los resultados mostraron que el uso de Olpheel Anti-Ox a una dosis de 30 ppm podría conducir a un valor de vida útil de 141 días para los alimentos extruidos almacenados a 25°C (Figura 2), correspondiente al tiempo necesario para que la oxidación comience durante el almacenamiento. Este periodo se considera elevado, ya que los alimentos extruidos se consumen rápi-
damente durante la cría de salmón o de camarones, demostrando que el uso del Olpheel Anti-Ox podría ser una estrategia eficaz para la conservación de los alimentos.
El uso Olpheel Anti-Ox, un antioxidante a base de semillas y piel de uva, ha dado como resultado una protección similar de los alimentos contra la oxidación a la de los antioxidantes sintéticos. Estos resultados indican el uso de Olpheel Anti-Ox como una alternativa eficiente a los antioxidantes sintéticos y a la etoxiquina para preservar los alimentos extruidos de la oxidación.

“Latinoamérica

El Summit Latinoamericano por la Sustentabilidad Pesquera y Acuícola, este año en su tercera emisión, es un evento que crea un espacio para reunir a todos los actores que, en cooperación, diálogo, generosidad y sobre todo buena voluntad, comparten experiencias, conocimientos, ideas para poder implementar soluciones concretas desde cada ámbito de acción al grave problema del deterioro ambiental en los mares, y que pone, además, en conflictos la seguridad alimentaria de la humanidad.
Por: Manuel SarmientoLa inmensidad del océano ha despertado desde tiempos inmemorable la sensación de que es vasto, ilimitado, de ser una fortaleza inalterable, de que se puede extraer o verter lo que sea de él y se va a regenerar. Si algo hemos aprendido en las últimas décadas es que esa sensación no es del todo correcta: es enorme pero no ilimitado, es sensible, con una influencia más allá de sus aguas y, aunque es muy generoso y buen amigo, lo hemos maltratado en diversas formas, exigiéndole en ocasiones más de lo que sanamente nos puede dar.
Esa exigencia nos ha dado a lo largo de los años resultados a veces no deseables: arrecifes que no están sanos por la contaminación, algunas pesquerías sobreexplotadas, plásticos flotando en el agua y tantos otros, que ha provocado un deterioro ambiental en los mares, y que pone, además, en aprietos la seguridad alimentaria de la humanidad.
Ya lo sabemos, y por ello se están haciendo innumerables esfuerzos e iniciativas para frenar y revertir el deterioro que nosotros mismos causamos. Todas suman, pero muchas veces son únicas, aisladas y desarticuladas con otras, perdiendo la oportunidad de la fuerza de la sinergia. Adicionalmente, la crisis tiene su origen en muchas causas (sociales, económicas, ambientales, legales, de justicia…) por lo que las soluciones más eficaces son las que incluyen a varios, idealmente a todos, los actores involucrados; es decir, si el paciente está muy enfermo de todo, el dermatólogo solo no lo va a salvar.
Por ello al hablar de que mi país ha implementado refugios pesqueros y regulado su flota para evitar la sobrepesca es fantástico, ayuda sin duda, pero su impacto es limitado si los vecinos no adoptan medidas similares.
Pensar en soluciones regionales más allá de los países, por ejemplo, latinoamericanas, son el camino para
tener una mayor celeridad en la restauración de la vida marina (y, por tanto, de la salud de nuestro único planeta), y eso solo se logra, justamente, coordinándonos, dialogando, compartiendo experiencias, conocimientos, estrategias; ya no estamos, si es que queremos sobrevivir como
humanidad, para seguir en el “modo del yo”, sino implementar el “modo nosotros” y, sobre todo, cuando hablamos de recursos irreverentes que se desplazan importándoles un pepino nuestras artificiales fronteras, como en el mar.
El Summit Latinoamericano por la Sustentabilidad Pesquera y Acuícola, este año en su tercera emisión, es un evento que crea un espacio para reunir a todos los actores que, en cooperación, diálogo, generosidad y sobre todo buena voluntad, comparten experiencias, conocimientos, ideas para poder implementar soluciones concretas desde cada ámbito de acción a tan grave problema.


En esta ocasión, o debería decir oportunidad, en Chile y con participación virtual, se reunirán pescadores de pequeña escala, industriales, acuicultores, organismos de certificación, organizaciones de la sociedad civil, gobiernos, procesadores, comercializadores, restauranteros, chefs, hoteleros y consumidores en general, buscando impulsar el desa-
rrollo de la sustentabilidad pesquera y acuícola latinoamericana, donde quepan todos los intereses, negocios, actividades, donde se pueda generar riqueza, alimentos, comercio justo, conocimiento, conciencia en la compra y disponibilidad a pagar por productos legales y sustentables hoy y en el futuro sin agotar los recursos naturales, con el lema: “Una sola región, una sola misión: pesca con futuro”, como el camino.

Temas como gobernanza en la pesca y acuicultura, equidad de género, pesquerías de pequeña escala, financiamiento, inversión de impacto, ecocertificaciones y tantos otros, muestran la diversidad y el enfoque multiprofesional que se requiere para compartir y proponer soluciones para el bien de la vida en el mar que, finalmente, también es nuestra vida.

La asistencia de muchos países, inclusive más allá de la región latinoamericana, hacen que esta reunión de trabajo sea particularmente enriquecedora y útil; presencia de,
por ejemplo, Chile, Perú, Ecuador, Colombia, México, Estados Unidos (seguro se me escapan muchos más), inclusive España, es un reflejo alentador de que afrontar los problemas comunes en conjunto, es mucho mejor camino que solos, con la esperanza de que finalmente, hayamos adquirido una nueva conciencia en la unión, para afrontar el reto más grande de la humanidad: sobrevivir a la disminución de los recursos naturales y al cambio climático... que además, nosotros solitos nos lo provocamos.
CKM, empresa peruana, contribuye con productos alternativos y naturales que potencian la sostenibilidad y rentabilidad del sector acuícola, a través de su Programa Aqua-CKM y sus productos fitobióticos Orevitol® AS 20 y Liverin-L®, con resultados positivos de productividad en el cultivo del camarón Litopenaeusvannamei.

 Por: Redacción de PAM*
Por: Redacción de PAM*
CKM, empresa peruana con 28 años de trayectoria en la industria de producción, se dedica a la investigación, innovación y desarrollo de productos farmacéuticos y productos alternativos naturales. Consciente de la actual exigencia del mercado mundial respecto al retiro de antibióticos en la producción animal, CKM está orientada a ofrecer programas con productos alternativos naturales capaces de ser usados de forma continua y eficiente en campo por avicultores, porcicultores y acuicultores.
CKM con su enfoque de investigación continua, contribuye con la sostenibilidad de la cadena de valor de la industria alimentaria, mejorando la nutrición, rendimiento y bienestar del animal. Además, constata que el consumidor final pueda gozar de carnes más inocuas y seguras para su consumo y que el productor logre una mayor sostenibilidad en su proceso productivo; apuntando de esta manera hacia su visión de ser una empresa líder en proponer productos y tecnología con estándares internacionales de calidad que, a su vez, sean sosteni-
bles con el medio ambiente, convirtiéndola en una empresa pionera en investigación y manejo de productos fitobióticos como una alternativa al uso de antibióticos.
Asimismo, CKM tiene como misión proveer productos y servicios con valor agregado a la industria, que mejoren la productividad de sus clientes, objetivos que cumple estrictamente a través de la certificación e implementación de su “Sistema de Gestión de Calidad”, “Buenas Prácticas de Manufactura” y “Buenas Prácticas de Almacenamiento”. Además, cuenta con profesionales de primer nivel en sus áreas de producción, logística y calidad, así como en los servicios técnicos de nutrición y sanidad para beneficio del productor y la industria. En particular, ofrece un innovador programa y productos para la industria acuícola.
CKM en la acuicultura
CKM no detiene la investigación ni los esfuerzos por colaborar con la sostenibilidad en la producción de proteína animal. Por esta razón, la empresa continúa en la evaluación de nuevas moléculas que logren su compromiso y objetivo de aportar productos naturales alternativos y programas innovadores, pero ahora enfocados en las necesidades del sector acuícola latinoamericano; con
el fin de ofrecer valor a través de programas con productos alternativos naturales que puedan ser utilizados de forma habitual y segura, permitiendo además maximizar la productividad y rentabilidad de las empresas de la industria. Para ello, pone a disposición de los productores acuícolas el uso de fitobióticos, asistencia técnica especializada y asesoría pre y postventa, con especial atención en especies clave para el mantenimiento y desarrollo de esta industria.
La exportación del camarón L. vannamei es la principal actividad del sector, la cual se rige por estrictos estándares internacionales de inocuidad y exige un organismo con ciertas características (peso, calidad, textura, melanosis, entre otros). En consecuencia, CKM consciente de que los camarones están expuestos a diario a la interacción con agentes patógenos, así como a un constante estrés fisiológico e inmunológico, presenta a través de su Línea CKMAqua, una nueva propuesta mediante un programa destinado a cubrir los puntos críticos que exige la industria camaronera.
La Línea CKM-Aqua ha desarrollado productos a base de moléculas alternativas como: fitobióticos, ácidos orgánicos, biopolímeros, entre otros, destinados a fortalecer y proteger la integridad intestinal, barrera antibacteriana y regenerar la pared celular de los órganos del camarón. Entre las primeras moléculas que trabaja CKM en el sector acuícola se encuentran los fitobióticos, moléculas clasificadas y reconocidas como seguras por la Administración de Alimentos y Fármacos de los Estados Unidos (FDA, por sus siglas en inglés).
El Programa Aqua-CKM está conformado por dos productos fitobióticos (Figura 1), ambos respaldados por un servicio técnico especializado:
3 Orevitol® AS 20, a base de aceite esencial de orégano, que contiene entre sus sustancias activas al carvacrol y timol.
3 Liverin-L®, a base de extracto de cardo mariano, cuyo componente es silimarina (combinación de flavolignanos como: silibilina, silicristina y silidianina).

Para la Línea CKM-Aqua es clave llevar a cabo protocolos de evaluación que permitan a sus clientes alcanzar el máximo potencial en el uso de los productos naturales alternativos (fitobióticos). Por tal motivo, estos entran en un exhaustivo esquema de evaluaciones que comprende las siguientes fases:
Primera evaluación: se realizan pruebas en laboratorio de diagnóstico, donde se mide la efectividad del producto contra cepas patógenas obtenidas del medio. Para ello, se toman muestras de camarones infectados con el fin de obtener las cepas patógenas y, así, poder evaluar la eficiencia y respuesta inhibitoria del producto.
Segunda evaluación: se efectúan pruebas en ciclos completos de crianza en granjas experimentales, donde se aplican los productos en programas establecidos bajo condiciones normales de trabajo de campo. Este estudio evalúa la eficacia del Programa Aqua-CKM respecto a la mejora de los parámetros productivos.
De forma simultánea a las evaluaciones experimentales, y gracias
a la colaboración de clientes y aliados estratégicos, los productos se ponen a prueba para solucionar problemas de campo en tiempo real (problemas sanitarios, tóxicos, entre otros). Además, como política, el servicio técnico de la Línea CKM-Aqua acompaña al acuicultor en todo su proceso productivo para que juntos, al evaluar y analizar las condiciones sanitarias presentes en cada granja y de cada unidad de negocio, se pueda llegar al diagnóstico y proporcionar la mejor solución para abordar el problema.
A continuación, CKM Aqua presenta una serie de estudios realizados en las diferentes etapas productivas, orientados a demostrar los beneficios de los productos fitobióticos Orevitol® AS 20 y Liverin-L® del Programa Aqua-CKM en las distintas etapas de crecimiento del camarón L. vannamei, tanto en ensayos en laboratorio como de campo, como se describe en la Tabla 1.
Evaluación: Laboratorio de Análisis
Los productos del Programa AquaCKM son continuamente evaluados

en laboratorio, para comprobar su efectividad contra los microorganismos y enfermedades emergentes de campo. En la Figura 2 se aprecia la evaluación microbiológica del producto Orevitol® AS 20 (aceite esencial de orégano), donde se puede observar la difusión en disco mostrando los halos de inhibición de crecimiento del Vibrio harveyi frente a discos impregnados con Orevitol® AS 20. Asimismo, se realizó la evaluación de Orevitol® AS 20 vs. Pseudomonas sp y vs. Vibrio parahemolyticus, con resultados de inhibición del crecimiento.

Como parte de los análisis en laboratorio, se condujo la evaluación clínico patológica de hepatopáncreas después del uso del Liverin-L® (extracto de cardo mariano). En la Figura 3 se muestra los túbulos hepatopancreáticos con una necrosis leve y la estructura de la pared difusa (Figura 3A), mientras que, el uso de Liverin-L® favorece la integridad del hepatopáncreas, lo que se demuestra a través de las paredes lisas y estructura conservada de este órgano (Figura 3B).
La evaluación de las larvas de camarón L. vannamei se realizó entre los meses de noviembre y diciembre de 2021. Cada evaluación se realizó por triplicado con sus respectivos testigos.
Los resultados demuestran la eficiencia del Programa Aqua-CKM, al obtener mayor supervivencia aun trabajando a altas densidades (Tabla 2).

Se realizó una primera evaluación de raceways en febrero de 2022. Los hallazgos arrojaron una mayor supervivencia de 7.42% con el Programa Aqua-CKM vs. el testigo (Tabla 3). Posteriormente, en las siguientes evaluaciones se obtuvo entre un 10% y 15% adicional en supervivencia respecto a los testigos en una segunda evaluación (agosto, 2022). En ambas evaluaciones del Programa Aqua-CKM en raceways, se logró obtener nuevos y mejores estándares, así como mayor supervivencia respecto a sus testigos,

además de una reducción significativa de microorganismos patógenos según análisis de laboratorio.
La evaluación de precría se realizó en febrero de 2022. Los resul-
tados demostraron una tendencia del Programa Aqua-CKM en lograr mayor supervivencia (Tabla 4). La evaluación de engorda se llevó a cabo en septiembre de 2022, observándose que los estanques con el Programa Aqua-CKM, empezaron

con un incremento de peso semanal inferior al testigo, logrando al final de campaña superarlo en peso. La edad de inicio fue de 36 días y la ubicación de las evaluaciones fue Tumbes, Perú (Tabla 5).


A través de las evaluaciones en la granja experimental se demostró que el uso continuo del Programa Aqua-CKM en diferentes épocas del año, permite lograr mejores parámetros productivos, alcanzando nuevos estándares, como se muestra en todas las evaluaciones (Tabla 6).
La utilización continua del Programa Aqua-CKM en la crianza del camarón L. vannamei durante
toda su etapa productiva, afecta de manera positiva su productividad. Asimismo, Orevitol® AS 20 y Liverin-L® (productos fitobióticos) demostraron que:
3 Trabajan como una barrera antibacteriana natural.
3 Favorecen la integridad intestinal.
3 Optimizan la ganancia de peso.
3 Estimulan el crecimiento del organismo.
3 Mejoran la conversión alimenticia.
3 Regeneran, mantienen y limpian sus órganos.
“Una vez más, se confirma la efectividad generada por el uso continuo del Programa Aqua-CKM a través del tiempo, mejorando y mantenido los parámetros productivos exigidos por el mercado acuícola mundial”.
Este artículo es patrocinado por CKM
Esta es una versión resumida desarrollada por el equipo editorial de Panorama Acuícola Magazine del artículo “CKM,EMPRESA PERUANA,QUECONTRIBUYECONUN PROGRAMA INNOVADOR,CON PRODUCTOS ALTERNATIVOSYNATURALES,QUEPOTENCIAN LA SOSTENIBILIDAD Y RENTABILIDAD DEL SECTOR”escritoporING.JAVIERSOTO,ING. PESQUEROLUISHURTADOYLIC.ANDREA MUÑOZ-CKM
La demanda de camarón es muy grande en todo el mundo, lo que requiere la implementación de innovaciones para alcanzar la producción necesaria, por lo que resulta importante evaluar a gran escala de la relación longitud-peso en camarones Litopenaeusvannamei cultivados en estanques revestidos con polietileno en el pueblo de Bhimpore del distrito de Surat (Gujarat, India).
Por: Redacción de PAM*La demanda de camarón es muy grande en todo el mundo, llevando a incrementar su cultivo en muchos países para lograr suplirla. En
consecuencia, el camarón peneido (Litopenaeus vannamei), con alta clasificación de exportación, se cultiva en todo el mundo (Suriya et al., 2016; Khademzadeh y Haghi, 2017)
con beneficios esperados como: especie libre de patógenos específicos (SPF, por sus siglas en inglés), resistencia a patógenos específicos (SPR, por sus siglas en inglés), tasa


de crecimiento rápido y fácil de cultivar, incluso con una población muy densa. Dicha especie se introdujo en Gujarat durante el periodo 2001-02, cuando los acuicultores sufrieron enormes pérdidas económicas en el cultivo del camarón tigre (Penaeus monodon) debido a varias enfermedades infecciosas.
Asimismo, se han implementado desarrollos e innovaciones en el cultivo de camarones con la finalidad de alcanzar la producción necesaria, de acuerdo con la demanda, por ejemplo, extender el revestimiento de polietileno sobre el estanque de tierra para reducir la filtración, mantener la fluctuación del pH en el agua sin contacto directo con el suelo y mantener los lodos, etc.
La producción efectiva de camarones depende de los parámetros fisicoquímicos y biológicos, pero también puede ser monitoreada mediante la relación entre la longitud y el peso (LWR, por sus siglas en inglés) y el factor de condición (K). La relación entre la longitud y el peso es un sustituto modesto para evaluar el peso corporal a partir de las medidas de longitud, que no son tan variables y se miden fácilmente en el campo (Gautam et al., 2014). No obstante, son herramientas muy valiosas para considerar las fluctuaciones biológicas en los organismos acuáticos (Shah et al., 2013; Gautam et al., 2014; Prajapati and Ujjania, 2021).
La relación longitud-peso tiene un papel importante en la ciencia de la pesca para regular variaciones concebibles entre diversas poblaciones de la misma especie (King, 2007), lo cual es apoyado por estudios de crecimiento comparativo (Peixoto et al, 2004).
El valor del factor de condición (K) es un índice que refleja la interacción entre factores vivos y no
vivos en la condición biológica de los organismos acuáticos y se calcula a partir del peso y la longitud (Lizama et al., 2000; Solanki et al., 2020), pudiendo utilizarse para estimar cambios en la condición nutricional (Lizama et al., 2000; Sutton et al., 2000; Lalrinsanga et al., 2012; Mohanty et al., 2015; Solanki et al., 2020; Prajapati and Ujjania, 2021).
En granjas de cultivos, ayuda a evaluar tanto las condiciones de salud y hábitat, como la accesibilidad a los alimentos (Hanson y Bajjaliya, 2005; Khademzadeh y Haghi, 2017)
En consecuencia, el estudio de la relación entre longitud, peso y el factor de condición (K) son herramientas importantes para entender las condiciones de cultivo, estatus de crecimiento y la condición de los camarones, objetivo principal de este estudio.
El camarón patiblanco del Pacífico L. vannamei se cultiva en todo el mundo con desarrollos e innovaciones como revestimiento de polietileno extendido (PEL, por sus siglas en inglés) sobre estanques de tierra.
En esta investigación se midieron las variables morfométricas que incluyen la longitud y el peso de 500 especímenes de camarones recolectados al azar de un estanque revestido de polietireno en Bhimpore, Surat (Gujarat) durante el ciclo de cultivo de 2021. La longitud de la muestra se midió desde la punta del rostrum hasta la punta final del urópodo, con la ayuda de un vernier con una precisión de ± 0.02 mm, y el peso se tomó utilizando una balanza electrónica con una precisión de 0.01 g (Lester, 1983).
Los datos de longitud de los camarones se dividieron en diferentes grupos de talla a intervalos de 2.00 cm: 10.001-12.000 cm; 12.001-
14.000 cm y 14.001-16.000 cm, que se designaron como A, B y C respectivamente.
La relación longitud-peso se calculó a partir de una función de potencia no lineal Y= aXb (Ricker, 1973) y a partir de datos transformados utilizando la ecuación lineal log (W) = log (a) + b log (L) descrita por Pauly (1983).
El factor de condición K se determinó a partir de la ecuación K = (W/L³) × 100 (Htun-Han, 1978), donde K es el factor de condición, W es el peso (g), L es la longitud total (cm).
Se recopilaron los datos de las variables morfométricas de longitud y peso de los camarones cuyos valores fueron 11.488-15.581 (13.393±0.035) cm y 12.26 a 31.22 (19.613±0.162) g respectivamente. Los datos de distribución de frecuencia de tallas mostraron que la longitud del grupo B fue dominante 377 (75%) entre la población de camarones estudiada, seguido por el grupo de tallas C 100 (20%) y el grupo A con 23 y (5%) (Tabla 1). Los supuestos de Fatima (2000) para camarones peneidos y Tandel (2020) para camarones patiblancos corroboran los resultados obtenidos, mientras que la dominancia de los camarones de mayor talla también fue reportada por Fatima (2001); Solanki et al. (2020) y Prajapati and Ujjania (2021).
La relación talla-peso concuerda con la modificación de crecimiento en longitud, y de crecimiento en peso, en las representaciones ordinarias de valoración (Silva et al., 2015). Las variables (longitud y peso) tienen una relación lineal positiva y el coeficiente de correlación (r²) fue de 0.633, 0.780, 0.809 y 0.906 en los grupos de longitud A, B, C y la población agrupada (Tabla 2, Figura 1).

La constante de crecimiento o coeficiente de regresión (b) fue de 2.541, 2.812, 3.531 y 2.997 para los grupos de talla de A, B, C y población agrupada (Tabla 2). Estos hallazgos revelan que el crecimiento de los camarones estudiados fue isométrico (b = 3.0) e indican que el crecimiento de los camarones fue normal, en consecuencia, la longitud y el peso siguieron la ley del cubo del crecimiento, resultados similares a los reportados por Konan et al. (2014), Udoinyang et al. (2016) y Khademzadeh y Hanghi (2017), mientras que Mane et al. (2019) y Prajapati y Ujjania (2021) comunicaron un crecimiento alométrico positivo en los camarones.
El factor de condición indica, a través de las variaciones de situación, información sobre la condición fisiológica de los peces en relación con el bienestar (Prajapati y Ujjania, 2021). En el estudio se observó para el grupo de talla A entre 0.763-0.850 (0.814 ± 0.005), para el grupo de talla B 0.720-0.974 (0.806 ± 0.002) y para el grupo de talla C 0.729-0.910
(0.815 ± 0.004), mientras que para la población total fue de 0.7200.974 (0.808±0.002) (Tabla 2). El valor resultante de K fue de 1.0-0.5; lo que significa que la condición de los camarones estudiados fue variablemente buena y el ambiente acuático del estanque PEL propicio. Resultados similares para los valores de K fueron reportados por Kunda et al. (2008) en Panulirus penicillatus, Tandel (2020) en L. vannamei y Solanki et al. (2020) en P. monodon En contradicción a los resultados presentados, un valor de K superior a 1.0 fue reportado para L. vannamei por Prajapati y Ujjania (2021) en Gujarat y para P. monodon por Mohanty et al. (2015) y Mane et al. (2019) en Odisha y Maharashtra.

Con base en estos hallazgos se puede concluir que el crecimiento de los camarones patiblancos del Pacífico (L. vannamei), cultivados en estanque revestido con polietileno, en el pueblo de Bhimpore del distrito de Surat (Gujarat, India)
fue isométrico y normal. De manera compatible, el valor del factor de condición se observó entre > 0.5 y < 1.0, lo que especifica que la condición de los camarones fue bastante buena. Aunque el ambiente de los estanques de cultivo fue propicio para los camarones, para lograr un crecimiento óptimo y comercial debería ser esencial alterar las operaciones de la granja .

Este artículo es patrocinado por REEF INDUSTRIES, INC.

A medida que los productores continúen buscando formas de proteger su inversión en cada ciclo, los postbióticos continuarán ganando impulso en la producción de camarones y peces como una estrategia para soportar el crecimiento y la supervivencia frente a desafíos impredecibles.
del agua, aumenta su susceptibilidad a las infecciones bacterianas. Por lo tanto, es crucial dotarlos con un sistema inmunitario preparado.
Un sistema inmunitario preparado está listo para responder y recuperarse rápidamente de los patógenos. Más importante aún, mientras el sistema de defensa está esperando ser activado, no le quita energía para el crecimiento y el desarrollo.
Descripción general de la inmunidad en el camarón
Aunque los camarones solo tienen un sistema inmunitario innato, este es muy complejo. Comprende muchas células, compuestos y genes, todos trabajando juntos para detectar, desactivar y eliminar patógenos.

Estos son algunos de los compuestos y mecanismos notables en el camarón:
Cuando hay un brote de enfermedad, los productores acuícolas pueden recurrir a antibióticos para tratar a camarones y peces. Aunque los antibióticos pueden salvar los organismos, también tienen inconvenientes. Entonces, cada vez más productores se preguntan: ¿cómo podemos evitar la necesidad de los antibióticos?
Los postbióticos están surgiendo como una estrategia para soportar la inmunidad en camarones y otras especies acuáticas. La investigación indica que estos pueden apoyar la diversidad del microbioma intestinal y la salud inmunológica. Cuando los camarones en cultivo se encuentran frente a factores estresantes, como cambios en temperatura y química
Los camarones solo tienen un sistema inmunitario innato, el cual produce respuestas genéricas a los patógenos. Cuando el sistema inmunitario innato se encuentra con un patógeno, no reconoce el tipo de patógeno, simplemente sabe que es extraño y prepara un ataque.
Los animales vertebrados (humanos, peces y otros) tienen un sistema inmunitario innato y otro adaptativo. El sistema inmunitario adaptativo aprende a reconocer patógenos y crea moléculas nuevas y específicas para ayudar a combatir las infecciones. Cuando el sistema inmunitario adaptativo se reencuentra con el patógeno, lo reconoce y puede reaccionar rápidamente. Este sistema de reconocimiento es beneficioso para combatir las infecciones repetidas y es por esta razón que las vacunas funcionan.
Fenoloxidasa: el mecanismo inmune más efectivo Se considera que la melanización es el mecanismo inmunitario más efectivo en los invertebrados, como el camarón (Amparyup et al., 2013). En este proceso, el compuesto crítico es la melanina, el mismo compuesto que produce pigmento en la piel humana. Las moléculas de melanina rodean a los patógenos y los desactivan al unirse a las proteínas en sus superficies.
Aunque el paso final de la unión es relativamente directo, la producción de melanina está controlada por una serie compleja de interacciones llamadas Sistema de Profenoloxidasa, o ProPO. Primero, las moléculas de detección descubren un invasor. Posteriormente, a través de una serie de reacciones, se produce la enzima fenolaxidasa, la cual constituye el factor limitante de la tasa en la producción de melanina: más fenoloxidasa significa un aumento de la melanina.
No siempre podrá ver lo que está sucediendo con los camarones por debajo de la superficie. Pero con un postbiótico, su futuro nunca había sido tan claro.

El aditivo postbiótico de Diamond V en el alimento promueve la sobrevivencia y el crecimiento de los camarones, ayudando a optimizar la biomasa máxima. Maximice el crecimiento de su negocio. Minimice su costo por cosecha.
DVAQUA™. Una solución que puede ver.

Los componentes celulares del sistema inmunitario también juegan un papel crítico. Los hemocitos, la primera línea de defensa, son células circulantes que envuelven materiales invasores en un proceso llamado fagocitosis. Una vez que la célula es engullida, libera moléculas altamente reactivas que pueden descomponer el patógeno. La liberación de estas moléculas se llama estallido respiratorio (o estallido oxidativo).
Efecto de la lisozima en las paredes celulares
Si bien los hemocitos pueden engullir y descomponer algunos patógenos, las bacterias pueden representar un desafío debido a la pared celular protectora que las rodea. La lisozima es uno de los compuestos en el sistema inmunitario del camarón con capacidad para romper la pared celular bacteriana. Con una pared celular debilitada, las bacterias son más vulnerables a otros ataques del sistema inmunitario.
Los estudios han encontrado que los camarones alimentados con postbióticos tienen niveles más altos de parámetros inmunitarios (como
fenenoloxidasa, lisozima y hemocitos) y tienen una mayor actividad de fagocitosis y estallido respiratorio. Aunque estos parámetros inmunes son más altos, parece que el sistema inmunitario está preparado y no completamente activado. Esto es evidente en condiciones de bajo desafío, en las que los organismos alimentados con postbióticos tienen un mayor crecimiento en comparación con aquellos que no reciben postbióticos. En condiciones de alto desafío, se ha encontrado que los camarones alimentados con postbióticos sobreviven a un ritmo más alto en comparación con el grupo de control.
Durante un estudio de dos meses en condiciones naturales en estanques de cultivo con presencia de Vibrio a < 2,500 CFL/ml, los camarones recibieron postbióticos o ninguno (Sanguin & Troncoso, 2019). En esta condición de bajo desafío, los camarones que recibieron postbióticos tuvieron una actividad de fenoloxidasa significativamente mayor (81%) (Figura 1) y una tendencia a aumentar el conteo total de hemocitos (6% más alto). Los camarones alimentados con postbióticos también superaron al control en términos de desempeño: mayor ganancia de peso (8%), menor factor de conversión alimen-

ticia (-11%) y mayor supervivencia (12%) (Figura 2).
En otro estudio en tanques de cultivo con alto desafío de Vibrio, los camarones blancos del Pacífico alimentados con postbióticos tuvieron niveles aún más altos de parámetros inmunitarios y supervivencia (Corneillie et al., 2019). Durante seis semanas, los camarones fueron alimentados con postbióticos o dieta control antes de ser desafiados con una cepa de Vibrio parahaemolyticus causante de EMS/AHPND. Siete días después del desafío, los camarones alimentados con el postbiótico tuvieron un estallido respiratorio significativamente mayor (83%), porcentaje de células fagocíticas (45%) y supervivencia (77%) en compa-

ración con el grupo de control (Figuras 3 y 4). Los camarones alimentados con postbióticos también mostraron tener una tendencia a una mayor actividad de la fenoloxidasa.


La lucha contra los patógenos requiere energía. El camarón tiene una serie de estrategias inmunes innatas para combatir la infección, pero el requerimiento de energía puede restar desempeño.
Es por eso que un sistema inmunitario preparado es importante; está listo para responder de manera rápida cuando ocurre un desafío, pero no está completamente activo y, por lo tanto, no le quita energía
a otras funciones corporales, como el mantenimiento o el crecimiento. La preparación del sistema inmunitario de los camarones y los peces puede ayudar a los productores a soportar el crecimiento y estar preparados si ocurre un desafío.

Los postbióticos pueden ayudar a proporcionar este amplio apoyo para camarones y peces porque no son un solo producto compuesto.
Los postbióticos contienen numerosos metabolitos que pueden tener una amplia gama de efectos en los organismos, desde la modulación del microbioma intestinal hasta la preparación del sistema inmunitario.
Los efectos de la preparación que los postbióticos parecen tener en el sistema inmunitario pueden estar contribuyendo a los resultados que los investigadores están empezando a ver: los camarones alimentados con postbióticos parecen superar en desempeño a los que no los reciben cuando hay bajos niveles de bacterias presentes y sobreviven mejor cuando son desafiados por niveles más altos de bacterias.
A medida que los productores continúen buscando formas de proteger su inversión en cada ciclo, los postbióticos continuarán ganando impulso en la producción de cama-
rones y peces como una estrategia para soportar el crecimiento y la supervivencia frente a desafíos impredecibles.

Aguirre-Guzman, G. et al. 2009. Penaeid shrimp immune system. Thai J. Vet. Med. 39(3): 205-215
Amparyup, P. et al. 2013. Prophenoloxidase system and its role in shrimp immune response against major pathogens. Fish & Shellfish Immunology 34: 990-1001.
Corneillie, S. et al. Fermented Yeast Product (DVAQUA) Shows Strong Protection Against EMS/AHPND in Whiteleg Shrimp Litopenaeusvannamei WAS 19-21 June 2019, Chennai, India. Sanguin, S. & J. Troncoso. Concept in Shrimp Feed Against Bacterial Diseases in Whiteleg Shrimp Litopenaeusvannamei WAS 19-21 June 2019, Chennai, India.
Este documento se proporciona a solicitud del interesado, con fines informativos, exclusivamente. Estos materiales no constituyen ni están destinados a constituir un asesoramiento veterinario, legal o regulatorio. La información contenida en este documento está basada en fuentes disponibles al público en general y/o datos no publicados, y se considera verdadera y precisa, pero Diamond V no garantiza ni ofrece ninguna garantía de precisión o integridad. El cumplimiento legal y regulatorio de su negocio es su responsabilidad. El comprador/usuario asume todos los riesgos relacionados con el uso de la información aquí contenida y está de acuerdo en que no tenemos ninguna responsabilidad para con usted o algún tercero en relación con el uso de dicha información. Recomendamos que consulte asesores de salud animal, regulatorios y legales familiarizados con todas las leyes, reglas y normativa aplicables.
Los días 7 y 8 de septiembre de 2022, se realizó la Conferencia de Cooperadores Agrícolas de las Américas 2022, evento emblemático de la Región de las Américas, en el cual se reunieron los principales tomadores de decisiones de la industria donde se escuchó la voz de oradores reconocidos internacionalmente, expertos en la materia, líderes de productores de Estados Unidos y especialistas de la industria, para discutir una variedad de tendencias y estrategias futuras.
 Marco Linné Unzueta*
Marco Linné Unzueta*
Los días 7 y 8 de septiembre de 2022, el Consejo de Exportación de Soya de Estados Unidos (USSEC, por sus siglas en inglés), en colaboración con el Consejo de Granos de Estados Unidos (USGC, por sus siglas en inglés), asociaciones de productores de trigo (U.S. Wheat Associates) y arroz (USA Rice), organizaron la Conferencia de Cooperadores Agrícolas de las

Américas 2022, evento emblemático de la Región de las Américas, en el cual se reunieron los principales tomadores de decisiones de la industria en un encuentro de dos días, se escuchó la voz de oradores reconocidos internacionalmente, expertos en la materia, líderes de productores de Estados Unidos y especialistas de la industria, para discutir una variedad de tendencias actuales.
Como parte del contexto, debemos de recordar que, según la FAO (2016), el crecimiento de la población alcanzará 9.5 mil millones de personas en 2050, estimándose que se requerirán 40 millones de toneladas adicionales de mariscos para 2030, es decir, casi el doble de nuestra producción actual para el consumo humano. A lo cual la FAO se cuestiona: “¿Cómo superar este déficit de manera sostenible?”.
Para responder lo anterior, se puede asumir que los productos obtenidos vía acuicultura tendrán una tendencia: “... en el próximo decenio, la producción total de la pesca de captura y la acuicultura superará a la de carne de vacuno, porcino y aves de corral” (FAO, 2016); producción que ostenta una gran calidad desde el punto de vista nutricional y que, a su vez, se reflejará en dietas más saludables; siempre y cuando se trabaje bajo la
premisa de realizar actividades bajo estándares de Buenas Prácticas de Producción (BPP) y de Buenas Prácticas de Manufactura (BPM), permitiendo la reducción de la huella de carbono bajo acciones de sustentabilidad.
Uno de los puntos críticos de atención ante lo expuesto, y en la tesitura de trabajar con las estrategias para reducir las emisiones de gases de efecto invernadero, en las dietas actuales y futuras, se promueven, en la mayoría de los casos, dietas “verdes” basadas en fuentes de origen vegetal, para lo cual se deberán establecer estrategias que promuevan el crecimiento, programación y estandarización de la producción, sin dejar de lado el incremento en la rentabilidad y favorecer el aprovechamiento sustentable de los recursos; reflejándose en acciones que permitan la reducción de las emisiones, adoptando tecnologías eficientes en combustible y trabajar en la producción de peces y mariscos, con fuentes alternas para la fabricación de alimentos “amigables” con el medio ambiente.
Con base en lo planteado por Doug Winter (Chairman USSEC), uno de los productos que deberá tener mayor incentivo para la producción de alimentos para la acuicultura es la SOYA, una gran fuente confiable nutricional a escala mundial; por lo que la USSEC busca dar valor agregado, a través de diferenciación de productos, permitiendo otorgar a las actividades pecuarias y acuícolas estructuras de
producción sostenibles, considerado como un valor compartido bajo un consumo con conciencia ecológica y estándares de sostenibilidad en la producción de soya.
Por otro lado, Jim Sutter (CEO USSEC) quien representa a la producción de Soya de EU, considera que la filosofía de GanarGanar busca apoyar a Latinoamérica (LATAM) con productos de soya de alta calidad que ayude a enfrentar los grandes desafíos, de las actividades agropecuarias y acuícolas, ante el cambio climático, entre otros, con base en lo definido por FAO en la agenda 2030, con énfasis en las emisiones de CO2 y sostenibilidad, produciendo específicamente en zonas definidas para agricultura, no deforestando, teniendo las menores huellas de carbono, lo que proveerá confianza en los consumidores a través de la educación que guíe las decisiones para contar con alimentos de calidad y en cantidad.
Adicionalmente a lo anterior, se establecerán o fortalecerán acciones a través de la Oficina de Programas Globales de USDA/Foreign Agricultural Science, acciones destacadas por William Bomershein, director de dicha oficina, estrategias en la producción y comercialización de soya, buscando un entorno global de beneficio para el sector agropecuario, estableciendo reglas predecibles, privilegiando el cambio climático y sostenibilidad en la generación de alimentos.
Por otro lado, se cuenta con programas de intercambio que buscan
hacer investigaciones de mercado en las diferentes regiones, principalmente en países emergentes, a través de Programas de Ciencia y Tecnología en temas de políticas para el desarrollo de mercados en países de bajos ingresos.
Como parte de las consideraciones definidas en la reunión, María Mayorga, MS, PhD. Especialista Técnico Regional en Avicultura, USSEC Américas, hace hincapié en el incremento en la producción pecuaria, por lo que se requiere incrementar la producción de alimentos balanceados, considerando que la pasta de soya de Estados Unidos ha logrado excelentes resultados en cuanto a una mayor eficiencia nutricional, ya que aporta la mayoría de los aminoácidos requeridos por los organismos en cultivo.

Por su parte, May Craze, Fundador Spheric Research, menciona que la I+D+i debe ser una estrategia continua en el desarrollo acuícola, resaltando en particular la experiencia de Sistemas de Recirculación para la Acuicultura (RAS, por sus siglas en inglés), aunado al manejo y niveles de producción intensivos, para lo cual la respuesta fue el desarrollo del sistema In-Pond Raceway (IPA o IPRS, por sus siglas en inglés), que en español lo podemos traducir en algo como “Canales de Flujo Rápido dentro de la Laguna”, sistema que, por múltiples razones como temas de sustentabilidad, eficiencia en consumo de agua-espacio así como la creciente demanda de pescado de los mercados, fue retomado en los últimos años con el impulso de la USSEC y evaluado en entornos comerciales con muy buenos resultados.
Finalmente, Jairo Amézquita, Gerente de Proyectos Regionales de Acuicultura, USSEC Américas, mencionó que para lograr alcanzar las metas establecidas durante la reunión se deberá considerar “la colaboración, capacidad resiliente, capital de inversión”, y que LATAM cuenta con las herramientas e inversiones necesarias para la innovación en acuicultura, con el apoyo de la producción de insumos de calidad a través de la producción de largo plazo de soya americana, bajo estándares de prácticas sostenibles que permitan el desarrollo de estrategias sustentables a inmediato plazo, donde se incluya la robótica, nanotecnología, biofortificación, cultivos verticales, entre otros.
La creación de la Red Mesoamericana de Acuicultores de Pequeña Escala tiene como objetivo promover la cooperación y el intercambio de saberes y experiencias que contribuyan al desarrollo inclusivo de asociaciones de México, Guatemala, El Salvador, Honduras, Nicaragua, Costa Rica y República Dominicana, fundadoras de este mecanismo internacional.
En el marco del Año Internacional de la Pesca y la Acuicultura Artesanales (2022), declarado por la Asamblea General de las Naciones Unidas y cuya promoción global ha sido encargada a la FAO, cuyo objeto es visibilizar y concientizar a la sociedad mundial sobre la importancia social y alimentaria de estos subsectores, la Oficina Regional de FAO para América Latina y el Caribe
impulsó la creación de tres Comités Subregionales, entre los cuales se instaló el Comité Mesoamericano para la Celebración de este importante hito internacional (Comité AIPAA-2022).
El Comité está integrado por autoridades nacionales de pesca y acuicultura de México y de los países centroamericanos, estas últimas representadas por la Organización del Sector de la Pesca y la Acuicultura

del Istmo Centroamericano (OSPESCA); además de confederaciones nacionales y regionales de pescadores artesanales, organizaciones de acuicultores de pequeña escala y de la sociedad civil, coordinados por la FAO. Se elaboró un plan de acción que prioriza diversas actividades, entre las que destacan las orientadas a la incorporación a los sistemas de protección social de los y las trabajadoras de las cadenas

de producción y valor de la pesca y la acuicultura de pequeña escala y las focalizadas en el fortalecimiento de su organización, asociatividad y articulación internacional.

En este marco, se ha identificado la ausencia de mecanismos de coordinación, intercambio y cooperación entre las organizaciones de acuicultores de pequeña escala de la región, a diferencia de sus contrapartes de la pesca artesanal que han consolidado su intercambio de experiencias y fortalecido su posición negociadora en foros internacionales.
La debilidad de los sistemas nacionales de registro acuícola no permite precisar con fiabilidad el número de acuicultores de recursos limitados y de la micro y pequeña empresa en la región; no obstante, se estima que alrededor de 18,000 productores acuícolas de
microescala operan en los países de Mesoamérica, con alta dispersión geográfica, incluyendo grupos indígenas, mujeres y jóvenes, muchos de ellos en la informalidad y consecuentemente al margen de los beneficios que brindan los programas oficiales creados para su apoyo.
En virtud de su baja escala productiva y limitaciones diversas, su mejor forma de enfrentar adversidades y aprovechar oportunidades de mercado o economías de escala que les permitan sostenerse e idealmente desarrollarse, es fortaleciendo su organización interna, su asociatividad, su articulación interorganizacional y promoviendo la cooperación tecnológica; consolidando sus compras de insumos o comercializando de manera colectiva, tanto en el ámbito local, como nacional y regional. Sin duda, las facilidades que brindan las tecnologías de
información digital permiten aprovechar beneficios y oportunidades más allá de sus fronteras.
Es con esta premisa que el Comité Mesoamericano AIPAA-2022 acordó impulsar la creación de la Red Mesoamericana de Acuicultores de Pequeña Escala, la cual se ha venido gestando en los últimos meses y se lanzó oficialmente el 30 de agosto del presente año. Tiene como objetivo promover la cooperación y el intercambio de saberes y experiencias que contribuyan al desarrollo inclusivo de asociaciones de México, Guatemala, El Salvador, Honduras, Nicaragua, Costa Rica y República Dominicana, que son las fundadoras de este mecanismo internacional.
Esta nueva Red funcionará con una estructura sencilla y ha elegido como Coordinador Fundador, al Dr. Francisco Martínez, de Red TilapiaMéxico y como coordinador alterno al Sr. Bily Cazali, de la Cadena de la Tilapia de Guatemala. Cuentan ya con un plan de acción que incluye diversas actividades de intercambio y fortalecimiento de capacidades a través de medios virtuales y se propone continuar gestionando la adhesión de más asociaciones de la región, cuyas características les definen como acuicultores de recursos limitados y de la micro y pequeña empresa, con lo cual se garantiza una relación de cooperación horizontal. La FAO y OSPESCA han sido incluidas como organizaciones observadoras y acompañarán técnicamente sus procesos. Sin duda la experiencia de otras redes que ya funcionan sin otro interés que el beneficio mutuo, permearán este nuevo mecanismo internacional.
Celebramos la creación de este importante mecanismo y les auguramos mucho éxito, reiterando la mejor disposición de FAO de acompañar sus esfuerzos, toda vez que esperamos tengan repercusión positiva en la seguridad alimentaria y las economías locales.
*NACA=Network of Aquaculture Centers of Asia.
* Oficina Regional de la FAO para América Latina y el Caribe, Santiago, Chile | www.fao.org

Llegué a Roma a presenciar por quinta vez un Comité de Pesca (COFI) con muchas expectativas de lo que pudiera suceder en esta trigésimo quinta edición del COFI… El evento hibrido permite avanzar en una agenda dominada por los festejos del Año Internacional de la Pesca y la Acuacultura Artesanales y temas muy significativos, pero desde mi punto de vista muy personal, no como representante de ninguna organización, creo que no es suficiente.

Llegué a Roma a presenciar por quinta vez un Comité de Pesca (COFI) con muchas expectativas de lo que pudiera suceder en esta trigésimo quinta edición del COFI, aunque con un nudo en la garganta por no querer dejar a mi hijo seguir creciendo, sin mí, por una semana. No importa como llegue uno a Roma, la
ciudad no defrauda y hace que los visitantes se enamoren, o se vuelvan a enamorar de ella en cada viaje. Sin embargo, la historia del COFI es distinta, ya que todavía por motivos del COVID no se llega a una sede de la FAO vibrante y llena de vida, sino que se es recibido en un edificio que aún vive protocolos COVID y el cual se siente desangelado y triste.
En la actualidad, por protocolos sanitarios, muy pocos empleados van a diario a trabajar, lo hacen desde sus casas, y se aprovecha esto para renovar grandes secciones del edificio. Los protocolos también hacen que no todos los participantes estemos en la misma sección, los delegados (2 por país) están convidados al salón plenario,

mientras que aquellos delegados que exceden el número permitido deben ubicarse en el salón rojo y los observadores quedamos todos en el salón verde. Sin importar el motivo, uno se siente aislado y las oportunidades para interactuar con nuestros colegas de todo el mundo se ven muy mermadas.
A pesar de todo, los pocos funcionarios de la FAO a los que se les permite asistir al evento lo hacen con ganas y dinamismo, los demás deben ver el evento desde sus casas u oficinas de manera virtual. Por más que lo intento, creo que jamás me acostumbraré a esta modalidad que llegó para quedarse. El evento hibrido permite avanzar en una agenda dominada por los festejos del Año Internacional de la Pesca y la Acuacultura Artesanales, en donde −como es costumbre− llueven elogios para todos los participantes. Se comentan temas fundamentales para el sector, como la disminución de la pesca ilegal no declarada y no reglamentada, acciones necesarias para combatir el cambio climático, la importancia de mantener la biodiversidad en la pesca y la acuicultura; además de las recomendaciones del comité de acuicultura. Todos ellos muy significativos, pero desde mi punto de vista muy personal, no como representante de ninguna organización, creo que no es suficiente.

Al pasar los años uno va perdiendo poco a poco la capacidad de asombro, es un hecho triste, pero cierto… lo ya vivido con anterioridad, no se vuelve a vivir con la misma emoción e intensidad. Tal vez eso es lo que me pasó con el COFI o, simplemente, las cosas han cambiado un poco, pero debajo de todo el glamur que estos Comités representan, o representaban, hace falta un poco de visión y pasión. Creo que es muy importante, fundamental, que tengamos una perspectiva muy clara de la acuicultura que vemos, todos, dentro de 20 o 30 años. Tal vez esta visión no será la misma por regiones o por países, pero también eso debemos de saberlo. Haber metido al congelador a la Declaración de Shanghái en el último subcomité de acuicultura, por las razones que hayan sido, que no técnicas, nos ha privado de la oportunidad de imaginarnos un mundo donde la acuicultura es prioridad, donde su objetivo es sacar a familias de la pobreza a través de trabajos bien remunerados, y no ser la última opción para muchos. Creo que la desactivación de la Declaración de Shanghái retrasa significativamente a la Transformación Azul y a la consolidación de la acuicultura a escala mundial.
Sé que probablemente sea una voz en el desierto, pero hoy quiero hacer un llamado a todos mis ami-
gos científicos, tomadores de decisiones y profesionales de la acuicultura a que unamos fuerzas y retomemos muchos de los puntos de la Declaración de Shanghái que deben de implementarse cuanto antes. En lo personal, creo que la FAO hizo su trabajo y, por motivos ajenos a ella, no se pudo concretar un esfuerzo de años. Somos nosotros, y nadie más, quienes debemos llevar las riendas y sin importar nacionalidades, credos o ideologías, nuestro compromiso con la humanidad requiere que empujemos para que la acuicultura entre en las agendas y, sobre todo, en los presupuestos de todos nuestros países… ¡Sigamos entre todos avanzando hacia la transformación azul!
Antonio Garza cuenta con Maestría y Doctorado en Acuicultura por la Universidad de Auburn, EE.UU. Actualmente, es Presidente, Aquaculture without Frontiers (AwF).
Rector, Universidad Tecnológica del Mar de Tamaulipas Bicentenario (UTMarT)
Fué Presidente-Electo, Sociedad Mundial de Acuacultura (WAS)
Experto acuícola, consultor de la FAO, así como especialista en planeación estratégica. Ex-director de Extensión y Entrenamiento Internacional de la Universidad de Auburn y creador de la Certificación para Profesionales en Acuicultura. Fundador de la Iniciativa Global para la Vida y el Liderazgo a través de los Productos Pesqueros. Recientemente fungió como Director General de Planeación, Programación y Evaluación de la CONAPESCA, en México. Su trabajo lo ha llevado a participar en el desarrollo de proyectos alrededor del mundo.

Recientemente se ha observado un marcado incremento en el capital de riesgo privado que apoya a emprendedores y empresas acuícolas en crecimiento.
Por capital privado nos referimos a recursos económicos que tienen su origen en empresarios y empresas privadas y son invertidos en proyectos y empresas privadas a través de diversos esquemas de organizaciones financieras, entre los cuales los Fondos de Inversión son los más conocidos.
Si bien cada inversionista, empresa financiera y Fondo tiene sus estrategias, criterios y áreas de inversión en particular, en términos generales estos se clasifican de acuerdo con el nivel de desarrollo de las empresas en la que invierten. Por un lado, está el capital privado para desarrollo (Equity Capital) y, por otro, el capital de riesgo (Venture Capital). El primero se enfoca tradicionalmente a empresas en operación con capacidad de producción y mercado ya probadas y requieren capital para crecimiento, fortalecimiento productivo y tecnológico, restructuraciones financieras, etc. El capital de riesgo está, como su nombre lo indica, dirigido a empresas nuevas o que apenas están validando su modelo de negocio, o empiezan a producir y vender, esto es, con un nivel de riesgo mayor a una empresa consolidada.
Los criterios fundamentales (de muchos existentes) para decidir una inversión de capital de riesgo es el potencial de rentabilidad y crecimiento de las nuevas o medianas empresas y, por supuesto, el nivel de riesgo existente en caso de no cumplirse la primera premisa.

La inversión privada en acuicultura ha estado presente por varios años; sin embargo, había sido bási-
camente al nivel de equity, esto es capital de desarrollo, dirigido a empresas ya consolidadas como las grandes salmoneras, camaroneras, RAS, etc. Lo interesante es que a partir del año 2020 observamos un crecimiento importante del volumen de capital de riesgo invertido en nuestro sector acuícola, no solo en producción sino en varios eslabones de la cadena de valor.
En la Figura 1, adaptada de información generada por el Consorcio de Inversionistas de los Océanos, Alimentos Marinos y Acuicultura (OSAIC, por sus siglas en inglés), podemos ver claramente en 2021 y lo que va del presente año, la aparición de fondos de capital de riesgo invirtiendo cantidades importantes de recursos en el sector acuícola.
Como se puede observar, la mayoría de los Fondos se encuentran aún abiertos, en otras palabras, continúan invirtiendo. La Figura 2 nos permite tener una idea de los eslabones de la cadena de valor acuícola a los cuales se están dirigiendo los recursos de capital de riesgo, mostrando el destino de las inversiones realizadas por los “Fondos y Oficinas Familiares” que participan en el OSAIC. En esta se evidencia que el desarrollo de alimentos alternativos para acuicultura es uno de los favoritos, donde se percibe un gran potencial de crecimiento debido a la presión existente para eliminar la harina de pescado de las formulaciones de balanceados acuícolas por motivos de sustentabilidad. El segundo eslabón de interés ha sido la producción de peces y mariscos y, en tercer lugar, la producción de macroalgas.
En términos de especies, los inversionistas manifiestan un gran interés en el cultivo de camarón, debido a que perciben un gran potencial de crecimiento del mercado, el incremento en la sustentabilidad de la actividad, la creciente adopción de tecnología, etc. Para la sorpresa de muchos, el cultivo de macroalgas acapara la atención de los inversionistas de capital de riesgo, principalmente por las oportunidades de mercado que representan el desarrollo actual de una amplia variedad de productos derivados, que van desde bioplásticos, biocombustibles, productos para las industrias farmacéutica, alimenticia y cosmética, etc. De igual manera, la capacidad de las macroalgas de

absorber grandes cantidades de CO2, contribuyendo a la mitigación del cambio climático, convierte a este sector en un candidato potencial para ingresar en los mercados mundiales de créditos de carbono.


Un aspecto de suma importancia que se considera ha frenado la inversión en acuicultura, es la percepción del sector financiero de que es una actividad no sustentable. Algunos expertos indican que el incremento en el flujo de recursos se debe precisamente a que tal impresión empieza a cambiar en virtud de los avances alcanzados en este sentido, sin dejar de reconocer los grandes retos por abordar. Este es el motivo por el cual el desarrollo de alimentos alternativos para la acuicultura en sustitución de la harina de pescado es uno de los sectores preferidos por los inversionistas (Figura 2). De igual manera, las aportaciones ambienta-
les proporcionadas por el cultivo de macroalgas al ecosistema es una de las razones de su popularidad. La sustentabilidad es, y seguirá siendo, un aspecto de suma importancia que debemos cuidar para favorecer el flujo de capitales a la actividad.
Para muchos empresarios con deseos de empezar nuevos proyectos acuícolas, o hacer crecer y reforzar las capacidades de producción y mercadeo de sus operaciones actuales, el acceso al capital de riesgo privado podría parecer una posibilidad lejana, con un proceso complicado y hasta amenazador. Al respecto podemos mencionar que, para los proyectos adecuados, la opción es real. Sin embargo, también debemos señalar que las inversiones de capital privado son altamente competidas, por lo cual los proyectos deben ser planteados meticulosamente de acuerdo con los criterios empleados
por los inversionistas para su selección. Por ello, es muy recomendable contar con asesoría profesional técnica y financiera con el fin de hacer un planteamiento viable para los inversionistas.
En el documento “Hacia una Revolución Azul”, elaborado por The Nature Conservancy y el fondo Encourage Capital, se estima que para el año 2030 se requerirá invertir en el mundo entre US$ 150,000 millones y US$ 300,000 millones en infraestructura de producción acuícola para poder satisfacer la demanda proyectada... ¡Solamente en el eslabón de producción!
Si bien es solo el primer paso, es importante que los inversionistas de capital privado y, más importante aún, los de capital de riesgo, empiecen a ver y valorar el potencial de negocios de la acuicultura mundial. Tenemos que aprender a desarrollar proyectos enfocados en los criterios de selección de estos inversionistas, a valorar la importancia y la trascendencia de incorporar a nuestras empresas socios capaces de contrarrestar nuestras debilidades y limitaciones.
La “Revolución Azul” solo será una realidad si logramos atraer y canalizar a nuestro sector los recursos que necesitamos… ¡Todos a trabajar!
Roberto Arosemena es Ingeniero Bioquímico con especialidad en Ciencias Marinas por el Instituto Tecnológico y de Estudios Superiores de Monterrey, Campus Guaymas, y obtuvo su Maestría en Acuacultura por la Universidad de Auburn, Alabama en Estados Unidos. Cuenta con más de 35 años de experiencia en el sector acuícola nacional e internacional.
Ha ocupado diferentes cargos tanto en el sector tanto privado como gubernamental entre los que destacan haber sido.
Presidente fundador de Productores Acuícolas Integrados de Sinaloa A.C., empresa integradora constituida por 32 granjas camaroneras.
Fue Director General fundador del Instituto Sinaloense de Acuacultura por más de 9 años.
Se desempeñó como Secretario Técnico de la Comisión de Pesca en la Legislatura LXII en la Cámara de Diputados del Congreso de la Unión.
Asimismo, ocupó el cargo de Director Ejecutivo del Consejo Empresarial de Tilapia Mexicana A.C., Actualmente se desempeña como Director General de NDC Consulting Group y como Socio Fundador y Director Ejecutivo del Centro Internacional de Estudios Estratégicos para la Acuicultura (Panamá).
La inteligencia artificial es un concepto simple a primera vista. Aprendizaje por máquinas. ¿Podemos enseñar a una máquina a aprender? La respuesta es un sí rotundo.

La mayoría estaría de acuerdo en la idea de que tener un enfoque consistente y estructurado de la producción es un elemento clave de la sostenibilidad. ¿Por qué pienso esto? Durante los últimos 43 años he trabajado con la comunidad acuícola internacional en una gran variedad de áreas. Mis primeros trabajos después de graduarme se centraron en el desarrollo de vacunas y la inmunización de peces de cultivo. Para saber si una vacuna funcionaba en el campo, había que saber qué pasaba en la población. Usualmente, era fácil porque los organismos sobrevivían cuando antes no lo hacían. El alcance del beneficio se determinaba en la cosecha, aunque a menudo había pistas previas.
El consumo de alimentos era una de las pistas, aunque requiriera monitoreo, que para los organismos que no eran visibles durante gran parte de su ciclo de vida, podría ser un desafío en el mejor de los casos. Por lo general, el acuicultor calcularía la biomasa en la cosecha y, luego, determinaría qué tan eficientemente se estaba usando el alimento al calcular el factor de conversión alimenticia (FCR, por sus siglas en inglés), una medida de la cantidad promedio de alimento consumido por la población sobreviviente. Este valor era una
pista de lo que podría estar pasando en la población, pero no había forma de saber qué estaba pasando en un individuo determinado.
Desde 1991 he estado trabajando principalmente con camarones de cultivo. He viajado mucho y he
pasado muchos meses en distintos países observando, aprendiendo y enseñando acerca de diversos aspectos de la sostenibilidad, entre otras cosas. Lo que noté es que había poca, si es que había alguna, consistencia en el enfoque para

Se ha demostrado una y otra vez que el uso de herramientas basadas en la ciencia y enfoques analíticos es importante para una producción consistente. Esto es esencial para la verdadera sostenibilidad.
criar camarones entre países e incluso entre productores vecinos. Caos sería una palabra apta para describirlo. A inicios de 1990, con algo de dinero de capital de riesgo, desarrollé y probé en el campo lo que en aquel tiempo esperamos se convirtiera en la primera vacuna comercial para camarones.
¿Cómo podríamos medir el éxito? Usualmente, como en el ejemplo anterior de FCR, uno observaba la población tratada y la comparaba con la población nativa. Los camarones se crían por millones. Esto hace que todo tipo de comparaciones esté cercano a errores de diferentes aspectos del proceso. Al igual que con los salmónidos en rediles para camarones en estanques, la presencia de problemas subyacentes de salud animal generalmente no es evidente. Me di cuenta de que debía haber alguna forma de recopilar datos de población que permitiera una toma de decisiones realista.
Uno de los grupos de granjas con los que trabajé en Ecuador, desarrolló un programa de computadora (AP1) que fue un paso
positivo en la dirección correcta. Permitía la entrada de datos y, a través de estadística correlativa, arrojaba una curva de regresión cuya pendiente definía la rentabilidad al momento de las observaciones. A medida que aumentaba la pendiente, también aumentaban los beneficios. Cuando la pendiente se mantenía estable, no había incremento en las ganancias y cuando la pendiente disminuía las ganancias declinaban. Esto se centró en gran medida en las estimaciones de supervivencia y FCR basadas en el muestreo de la población. Sorprendentemente preciso, el programa demostró que, mantener y registrar la mayor variedad de datos posible y usar estadística correlativa, era una herramienta poderosa.
Sin embargo, cuando uno trataba de explicar esto a muchos acuicultores fuera de este pequeño círculo, caía en oídos sordos. Muchos argumentaron que la cría de camarones era rara vez un arte y las herramientas de la ciencia no eran apropiadas. Esta era la vieja escuela y, aunque todavía hay muchos
aferrados a este enfoque anticuado, la realidad es que la cría de camarones no es diferente de otros paradigmas agrícolas, a excepción de estar trabajando con invertebrados y ambientes acuáticos. Se ha demostrado, una y otra vez, que el uso de herramientas basadas en la ciencia y enfoques analíticos es importante para una producción consistente. Esto es esencial para la verdadera sostenibilidad, no solo lo que hoy pasa por ella.
La inteligencia artificial (AI, por sus siglas en inglés) es un concepto simple a primera vista. Aprendizaje por máquinas. ¿Podemos enseñar a una máquina a aprender? La respuesta es un sí rotundo. Hay muchas cosas diferentes que suceden en la típica granja camaronera. ¿Qué pasaría si se pudiera usar una combinación de tecnologías para diseñar un programa capaz de ver al camarón en tiempo real (esto se está haciendo con sistemas de alimentación automática basados en sonido y acústica y, en algunos casos, cámaras) y que pueda aprender sobre lo que está sucediendo con la población, con base en la correlación de observaciones con la salud animal y los resultados finales de rentabilidad, la biomasa final en la cosecha (supervivencia y peso promedio) y FCR?
Un programa intuitivo permitiría ver las conexiones entre cualquier número de prácticas, incluyendo naturaleza fisicoquímica del entorno de producción, tamaño, estructura y diseño de los tanques y estanques, composición genética de los organismos, naturaleza de los alimentos y cualquier aditivo que pueda ser añadido en la alimentación, uso de aireación, uso de alimentadores automáticos, uso de biorremediación, uso de probióticos, salud de la población basada en muestreo, análisis en tiempo real del comportamiento animal, presencia de patógenos oportunistas y/u obligados, estructura del microbioma, entre otras. Este programa necesitará el acceso a todos estos datos y poder observar la población en tiempo real. De aquí,

¿Qué pasaría si se pudiera usar una combinación de tecnologías para diseñar un programa capaz de ver al camarón en tiempo real y que pueda aprender sobre lo que está sucediendo con la población, con base en la correlación de observaciones con la salud animal y los resultados finales de rentabilidad, la biomasa final en la cosecha (supervivencia y peso promedio) y FCR?

se generarían conclusiones sobre patrones de comportamiento que no se pueden ver ni correlacionar estadísticamente de varios elementos de producción.
¿Que podríamos aprender? Tendríamos una comprensión mucho más detallada sobre el impacto de la tecnología en los resultados. También, veríamos problemas apareciendo mucho antes de lo que permiten los métodos actuales lo que llevaría a implementar medidas reactivas y proactivas en etapas tempranas para alterar el resultado. El impacto de una amplia diversidad de variables sobre el resultado deseado y la máxima rentabilidad, sería evidente. Esta infor-
mación estaría en un formato en la nube accesible para todos.
Mi primer pensamiento mientras reflexionaba sobre esto fue que en muchos criaderos y granjas elegirían no ser parte de este sistema. Es probable que los productores de reproductores y de maduración también opten por no participar. La razón es simple. Cuando los datos muestren la existencia de algún problema con ciertos organismos de un sistema de producción específico, esto podría perjudicar la capacidad de los dueños de ganar dinero. En un mundo ideal, esto obligaría a los propietarios a modificar sus prácticas para mejorar. En el mundo real, asumir la respon-
sabilidad es una gran idea, pero arriesgada. Esto básicamente significa que se requiere establecer regulaciones para forzar a una industria que preferiría no ser tan visible. En la actualidad, este tipo de programa de AI no existe. Pienso que esto cambiará... Cuando todos los elementos de la cadena de suministro se den cuenta del poder de esta herramienta para garantizar que la producción sea rentable de forma constante, es de esperar todo encaje en su lugar. Quienes no implementen la estructura requerida, continuarán fallando, al menos de manera intermitente.
Es posible que todos estos datos se almacenen en la nube. Las
especificaciones de una operación determinada solo estarían disponibles para quienes los cargaron allí. Lo que estaría disponible para la industria, en conjunto, sería las conclusiones que la AI extrae de los datos. Esto permitiría a quienes comprenden el poder de estos datos, realizar cambios en la forma como ejecutan sus operaciones. Se transformarían en Procedimientos Estándares de Operación (SOP, por sus siglas en inglés). Las empresas e individuos que opten por no seguir este camino, deberán justificarlo ante los clientes que decidan que seguir estas prácticas es esencial para la sostenibilidad general de sus operaciones. A la larga, llevaría a la industria a una verdadera sostenibilidad al reducir aquellas prácticas que la AI demuestra no son sostenibles.

El término sostenibilidad se ha convertido en un elemento de marketing, con poco consenso sobre sus implicaciones. Esto se asemeja a otros términos como ecológico,
verde, probiótico, etc. La industria global de cultivo de camarones, como existe ahora, no es universalmente sostenible. Algunos sectores pueden considerarse tales, pero el espectro de enfermedades continúa rondando en las cabezas de los productores. La sostenibilidad en su significado más simple, puede definirse como poder cultivar camarones en el futuro con los mismos enfoques tomados hoy. Muchos camaronicultores no forman parte de grandes corporaciones y muchos podrían considerarse productores de subsistencia. Tienen pequeñas granjas y viven de cultivo a cultivo. Fallas extendidas de sus siembras acaban con sus sueños y terminan retornando a paradigmas de cultivo menos riesgosos. Incluso si la AI estuviera ampliamente disponible, no se beneficiarían en la misma medida que lo harían las granjas corporativas más grandes.
Muchas empresas están analizando o desarrollando activamente la AI, si no para un uso generalizado,
al menos para sus propias operaciones. Reconocen el valor a largo plazo. Predecir el futuro es con frecuencia un trabajo de conjeturas. Creo que en un futuro próximo veremos como la AI se convierte en una parte cada vez más importante de las prácticas culturales estándar y sus beneficios se extenderán ampliamente, marcando el camino hacia la verdadera sostenibilidad… Elementos de esta tecnología ya se están utilizando.
Stephen Newman es doctor en Microbiología Marina con más de 30 años de experiencia. Es experto en calidad del agua, salud animal, bioseguridad y sostenibilidad con especial enfoque en camarón, salmónidos y otras especies. Actualmente es CEO de Aqua In Tech y consultor para Gerson Lehrman Group, Zintro y Coleman Research Group.
Contacto: sgnewm@aqua-in-tech.com www.aqua-in-tech.com www.bioremediationaquaculture.com www.sustainablegreenaquaculture.com
Por: Lilia Marín Martínez*La conservación de los alimentos representa un gran desafío provocado por el cambio climático, de allí que las condiciones de su almacenamiento sean clave para evitar el aumento de la cantidad de agua en el alimento, el riesgo de proliferación microbiana y el desarrollo de hongos y levaduras.

El fenómeno de La Niña persistirá durante el resto del 2022, con probabilidades de que decrezca de 86% a 60% entre los meses de diciembre 2022 y febrero 2023, suprimiendo la convección en regiones al oeste y al centro del Pacífico y generando lluvias y humedades relativas altas, convirtiéndose en una grave amenaza para la seguridad alimentaria, el desarrollo sostenible y el almacenamiento.
Bajo estas condiciones ecológicas se favorece el desarrollo de los principales factores que ocasionan las pérdidas económicas de las materias primas almacenadas, por lo que garantizar su almacenamiento y conservación ha sido de gran preocupación.
La conservación de los alimentos representa un gran desafío provocado por el cambio climático.
El almacenaje debe efectuarse en condiciones de baja humedad relativa, en caso contrario, la humedad (agua) presente en la atmósfera tarde o temprano acabará por aumentar la cantidad de agua del alimento, aumentando así el riesgo de proliferación microbiana, en especial de aquellos que se encuentran en la superficie, y el desarrollo de hongos y levaduras. Este aspecto frecuentemente constituye un problema con impacto negativo en las plantas de rendimiento, plantas de alimentos balanceados y comercializadores, ya que nos obliga a tomar medidas costosas para mantener la conservación óptima.
El almacén debe contar con estantes, tarimas, armarios o vitrinas que guarden una distancia adecuada entre ellos y separados de la pared para facilitar el manejo de los productos y la limpieza de los estantes; además de termómetros e higrómetros de acuerdo a las características de los productos a resguardar. En ningún caso, deben colocarse los productos directamente en el piso.
Las instalaciones deben contar con los materiales de limpieza necesarios, almacenados de tal manera que se garantice la rotación adecuada del inventario, que las existencias más antiguas se usen primero. En otras palabras, seguir el principio de PEPS, método de inventario que se basa en “primeras entradas, primeras salidas”.

Los techos deben ser de material que evite las filtraciones de agua, donde el diseño de las aéreas permita el correcto aireamiento para que materias primas y productos terminados se mantengan a la temperatura, humedad y demás condiciones necesarias, para conservar la calidad e integridad de los productos. Finalmente, es necesario considerar un sistema que garantice la correcta ubicación y distribución de los productos en el almacén.
La Humedad Relativa se define como una proporción, expresada en porcentaje, de la cantidad de humedad atmosférica presente en relación con la cantidad que estaría presente si el aire estuviera saturado, según el National Oceanic and Atmospheric Administración (NOAA). Por ejemplo, 0% significa
que el aire está completamente seco y 100% de humedad relativa significa que está a punto de formarse niebla o rocío a medida que el vapor se condensa. Cuando la temperatura desciende por debajo del punto de rocío, el vapor de agua se convierte en precipitación como lluvia, nieve o rocío.

La conservación adecuada de las materias primas, dependerá esencialmente de las condiciones ecológicas de la planta o almacén, las propiedades físico-químicas y las biológicas de las mismas, el período de almacenamiento, así como del tipo y las características del almacén.
 *Estudió Ingeniería Química en la Universidad de Guadalajara, con especialidad en Nutrición, Producción de Alimentos para Mascotas y Acuicultura por T&M. Ha sido Jefe de Control de Calidad y Producción en Aceiteras y en Empresas de Alimentos Balanceados. Es Consultora Internacional y Nacional en Empresas de Productos Marinos, Aceites y Harinas de Pescado, Plantas de Rendimiento de subproductos de origen animal, entre otros. CEO de Proteínas Marinas y Agropecuarias S.A. de C.V. (PROTMAGRO) y de Marín Consultores Analíticos.
*Estudió Ingeniería Química en la Universidad de Guadalajara, con especialidad en Nutrición, Producción de Alimentos para Mascotas y Acuicultura por T&M. Ha sido Jefe de Control de Calidad y Producción en Aceiteras y en Empresas de Alimentos Balanceados. Es Consultora Internacional y Nacional en Empresas de Productos Marinos, Aceites y Harinas de Pescado, Plantas de Rendimiento de subproductos de origen animal, entre otros. CEO de Proteínas Marinas y Agropecuarias S.A. de C.V. (PROTMAGRO) y de Marín Consultores Analíticos.
La importancia de aportar los requerimientos de ácidos grasos esenciales a cada especie cultivada, no es solo con la finalidad de optimizar la producción y el rendimiento del cultivo, sino también la de generar un producto con altos niveles de ácidos grasos esenciales que beneficie la salud del hombre.
El aceite y la harina de pescado para la elaboración del alimento acuícola se obtiene principalmente de pequeños peces que habitan la zona pelágica del océano, tales como anchoas, sardinas, caballas y arenques (Escalante, 2010). Sin embargo, estas especies son un recurso limitado y la mayoría de ellas están siendo sobreexplotadas o se encuentran en su límite máximo de seguridad biológica. Se reporta que en promedio se necesita procesar 1 tonelada métrica de peces pelágicos para producir solo 225 kg de harina de pescado y 50 kg de aceite de pescado (Hamilton et al., 2020; Kok et al., 2020).

En los últimos años, los costos de la elaboración de la harina y el aceite de pescado se han venido incrementando debido a la sobreexplotación y a la menor existencia de estas especies. Tanto así, que el costo de producción de la compra del alimento balanceado está representando 60%, 70% e incluso un poco más del costo total de la producción, afectando sig-

nificativamente a los acuicultores, en especial, los pequeños y medianos productores.
¿Qué son los ácidos grasos esenciales y por qué son tan importantes?
Los aceites de pescado contienen diferentes ácidos grasos, en términos de familia omega 3, 6 y/o 9, de los cuales el número y la posición de sus dobles enlaces es la característica química que determina las propiedades físicas y funcionales de cada ácido graso (Rustan & Drevon, 2005). Los omega 9 son ácidos grasos monoinsaturados, porque tienen un solo doble enlace, siendo el más común el ácido oleico. A los ácidos grasos 3 y 6 se les llama ácidos grasos poliinsaturados (AGPI), ya que se componen de cadenas largas de carbono con más de un doble enlace (entre 4 y 6 dobles enlaces). Si el primer doble enlace se encuentra entre el tercer y cuarto átomo de carbono se llaman ácidos grasos n-3; y si el primer doble enlace está entre el sexto y séptimo átomo de carbo-
no, se denominan ácidos grasos n-6 (Rustan & Drevon, 2005).
En la acuicultura, la importancia de aportar los requerimientos de ácidos grasos esenciales a cada especie cultivada, no es solo con la finalidad de optimizar la producción y el rendimiento del cultivo, garantizando la buena salud de la especie (Tasbozan & Gokce. 2017), sino también la de generar un producto con altos niveles de ácidos grasos esenciales que beneficie la salud del hombre.
Existen numerosas investigaciones que reportan que el consumo directo de ácidos grasos n-3, especialmente el ácido docosahexaenoico (DHA), apoya en la protección contra enfermedades cardíacas fetales, la regulación de la presión arterial, la prevención de diabetes y algunos tipos de cáncer, y tienen efectos antiinflamatorios (Lunn & Theobald, 2006). Además, señalan que existe una proporción ideal de ácidos grasos n-6/n-3 en la nutrición humana, la cual contribuye a la prevención de enfermedades. Esta proporción aún sigue siendo tema de debate e investigación, pero algunos recomiendan proporciones que varían entre 1:7, 1:10 y 1:20 de n-3:n6 (Lunn & Theobald, 2006).
En los organismos acuícolas el grado de esencialidad es diferente, el cual se define según la capacidad de la especie para convertir un ácido graso n-3 o n-6 en otro, es decir, que por medio de algunos precursores tengan la capacidad de sintetizar algún ácido graso esencial (Rustan & Drevon, 2005). Dentro de la vía de
biosíntesis de los AGPI (Figura 1), los omega 6 se originan a partir del ácido linoleico (ALA), de los cuales este es precursor para la formación de otro ácido: ácido araquidónico (ARA). Mientras que, los omega 3 son de cadena más larga, que se originan a partir del ácido linolénico (LNA), los cuales son precursores para la síntesis del ácido eicosapentaenoico (EPA) y ácido docosahexaenoico (DHA).

Necesidades de ácidos grasos esenciales según tipo de organismo
En acuicultura, los peces dulceacuícolas tienen una cierta capacidad de sintetizar el ARA, EPA y DHA entre la acción enzimática que interviene en la elongación (adición de átomos de carbono) y en la desaturación (extracción de hidrógeno) de la cadena de ácido graso cuando hay suficientes cantidades de precursores de LNA y ALA (Tocher, 2015). En otras palabras, estas especies pueden sintetizar ARA, EPA y DHA a través de los ácidos grasos linolénico y linoleico, los cuales se pueden conseguir más fácilmente en diferentes aceites de origen vegetal, tales como: aceite de soja, canola, chía, semilla de lino, sacha inchi, entre otros (Escalante, 2010; Costa e Silva et al., 2013; Pozo & Durán, 2015).
En peces marinos esta capacidad es baja, o se cree nula, entre otros aspectos porque los ácidos grasos esenciales los encuentran en el alimento de manera abundante. Las microalgas y plancton marino,
principales fuentes de alimento dentro de la cadena trófica del océano, sintetizan directamente los EPA y DHA y, por ende, no requieren generarlo (Tocher, 2015). A diferencia de las microalgas marinas, las de agua dulce contienen niveles más altos de los precursores ALA y LA (ácido graso Linoleico), que EPA y DHA, e incluso se reporta que contiene niveles más altos del precursor LA que origina los ácidos grasos omega 6 (Castro et al, 2012). Se considera que esta diferencia, quizás es la que ha obligado a las especies dulceacuícolas a generar ciertas estrategias adaptativas para producir sus propios ácidos grasos esenciales, a partir de dichos precursores (Tocher, 2015).
Alternativas de fuentes de ácidos grasos en acuicultura
La principal fuente de reemplazo del aceite de pescado son los aceites vegetales, los cuales sin duda garantizan el aporte de ALA y LA durante la nutrición de los organismos. Sin embargo, hoy en día la tecnología acuícola va más allá, apostando a fuentes que aporten directamente el DHA y DPA para satisfacer la demanda requerida por la especie y, a su vez, enriquecerla de estos ácidos para beneficio de la salud humana.
Las fuentes de ácidos grasos de origen marino incluyen el uso de microalgas fotosintéticas. Actualmente, en muchos criaderos o granjas se viene aplicando o cultivando diatomeas para suministrar EPA y flagelados para suministrar DHA a alimentos vivos, rotíferos y
nauplios de Artemia para así alimentar los primeros estadios del desarrollo de la especie (Muller- Feuga, 2004). Sin embargo, ninguna de estas tecnologías ha superado el umbral de viabilidad económica.
Por el contrario, la tecnología simbiótica BAF. (www bioaquafloc. com) se ha especializado en generar cantidades de zooplancton en el agua y fondo como para alcanzar concentraciones de EPA y DHA tan altas que cubran por completo las necesidades fisiológicas de los organismos. Al asegurar una fuente constante de estos AGPI, puede usarse alimentos predigeridos en base de soya, libres de harina o aceite de pescado, en ocasiones, con sustituciones del 90-100% de alimento balanceado por predigerido.
Este artículo ha sido elaborado con la colaboración de la Biol. Edna Riaño.
*Referencias citadas por el autor disponibles bajo previa solicitud a nuestro equipo editorial. Doctor en Ecología Marina, Máster en acuicultura y Licenciado en Ciencias Ambientales por la Universidad de Murcia. Colaborador de investigación en laboratorios en Francia, Corea del Sur, Australia y México. Fue investigador nacional SNI1 en México. Consultor de Conservation International Foundation en Costa Rica y Asesor internacional de empresas productivas en tecnologías acuícolas simbióticas. Revisor de la Revista Ingeniantes CITT. Tutor académico de tesis de doctorado en tecnologías simbióticas. Fundador y gerente de la web de acuicultura simbiótica www.bioaquafloc.com
Agripac 15
Dirección: Córdova 623 y Padre Solano
PBX: (593) 4 – 3703870, 4 – 2560400
E-mail: sprincipal@agripac.com.ec www.agripac.com.ec
Agrosuncorp, S.A. 55
Oficinas: Km 8.5 Vía a Daule, Coop. Juan Montalvo Mz. 5 Sl. 3. Guayaquil, Ecuador. Tel: (+593) 983782902, (+593) 04 602 6590 E.mail: agrogerencia@agrosuncorp.com.ec www.agrosuncorp.com.ec/
Aker BioMarine Manufacturing LLC. 51 4494 Campbell Road Houston, TX 77041 EE.UU. Tel: +1 346-802-6643
Carretera Internacional y Calle Fresno S/N Parque
Industrial No. 2
C.P. 85000 | Cd. Obregón, Sonora.
Contacto: Osvaldo Anaya / Clarissa Navarro Tel: 644 410 6235
E-mail: clarissa_navarro@cargill.com www.cargill.com.mx
GPO GAM.
Contacto: Adriana Armijo Tel: +668 817 5471
TERCERA DE FORROS
E-mail: ventaspacifco@gbpo.com.mx www.gbpo.com.mx
National Renderers Association, Inc. 105 Oficina para Latinoamérica: Sierra Candela 111 Oficina 501. Lomas de Chapultepec
C.P. 11000 CDMX Contacto: Luz María Cano. Tel: (55) 55 5980 6080
E-mail: nramex@nralatinamerica.org
MEGASSUPPLY 43
EE.UU., Europa, Sudamérica, Asia y Medio Oriente. Tel.: +1 (786) 221 5660 Fax: +1 (786) 524 0208 www.megasupply.net
PHODÉ. 109 E- mail: phode@phode.com www.phode.com
Proteínas Marinas y Agropecuarias S.A. de C.V. 13
Calle 2 Cañas #2775. C.P. 44470 Guadalajara, Jalisco, México Tel: +52 (33) 3810 2185 E-mail: contac@protmagro.com www.protmagro.com
SKRETTING. 67
Km 6.5 vía Durán-Tambo, Durán, Ecuador
Contacto: Piero Botteri Tel: +593 9693 78133
E-mail: piero.botteri@skretting.com www.skretting.com/es-EC/
VITAPRO / NICOVITA 31
Av. 28 de Julio 1150, Mirafores Lima, Perú.
Contacto: María Alejandra Rivera Cárdenas Cel: +51 996 479 973
E-mail: mriveraca@vitapro.com.pe www.vitapro.com.pe
Zeigler Bros, Inc. 99
400 Gardners, Station RD, Gardners, PA. 17324, EE.UU. Contacto: Susan Thompson
Tel: 717 677 6181
E-mail: sales@zeiglerfeed.com www.zeiglerfeed.com
ADILISA. 29
Oficinas corporativas: Km 11,5. Vía Daule. Urb. Inmaconsa. Mz 22 Solar 2. Guayaquil, Ecuador. Tel: (+593) 994422452 www.adilisa.com
AGRANTECH. 33 Bálsamo Sur 606 y Av. Las Monjas. Guayaquil, Ecuador. Tel: 2388450, 2388364
E-mail: info@agrantech.com
BIOIBERICA. 81
Oficinas corporativas Av. Països Catalans 34, planta 2ª, 08950 Esplugues de Llobregat (Barcelona - España) Tel: +34 93 490 49 08
E-mail: animalnutritioncontact@bioiberica.com www.bioiberica.com
Diamond V Mex S. de R.L. de C.V 123 Circuito Balvanera # 5-A Fracc. Ind. Balvanera, Corregidora. Quéretaro, México. C.P. 76900. Contacto: José Ramón Pérez H. Tel: (442) 183 71 60, fax (442) 183 71 63 E-mail: j.perez@diamondv.com www.diamondv.com
DSM Nutritional Products Latin America. 79 San José, Costa Rica. E-mail: Thiago.Soligo@dsm.com www.dsm.com
FARMAGRO. 23 Cdla. Los vergeles Calle 23A. Dr. Carlos Julio Arosemena, No 1-6-7 Intersección Av. 38C Mz 263. Guayaquil, Ecuador. E-mail: info@farmagro.com www.farmagro.com/
INVE Aquaculture Inc. 91 3528 W 500 S-Salt Lake City. UT. PO 84104 EE.UU. Contacto: Teri Potter. Tel: (801) 956 0203 E-mail: tpotter@inve-us.com www.inve.com
MSD MERCK ANIMAL HEALTH. 87 Oficinas Corporativas San Jerónimo Avenida San Jerónimo 369 Piso 5. Col. la Otra Banda. Álvaro Obregón 01090 CDMX. Sitio de Producción Santa Clara Plásticos No. 28 Santa Clara Coatitla 55540 Ecatepec de Morelos, Estado de México. Tel: + 5255 5569 1227 www.msd.com/contact/contacts.html
Prilabsa International Corp. 9 2970 W. 84 St. Bay #1, Hialeah, FL. 33018, EE.UU. Contacto: Roberto Ribas. Tel: 305 822 8201, 305 822 8211 E-mail: rribas@prilabsa.com www.prilabsa.com
E.S.E. & INTEC Process Equipment, Systems & Technologies. 137 Carretera Córdoba a Veracruz. Km 342, Zona Industrial, C.P. 94690, Córdoba, Veracruz, México. Tel: +52 (271) 751 7350, (271) 751 7396 E-mail: contacto@intecmx.com www.intecmx.com
Extrutech. .............................................................139 343 W. Hwy 24, Downs, KS 67437, EE.UU.
Contacto: Judy Long. Tel: 785 454 3383, 785 284 2153, 52 2955 2574 E-mail: extru-techinc@extru-techinc.com, osvaldom@extru-techinc.com www.extru-techinc.com
SEINMEX Servicios y Equipos Industriales de México 11
México: Aguascalientes # 327 Col. San Benito. Hermosillo, Sonora, México. Tel: (+52) 662 306 8890 E-mail: ventas@seinmex.com
Centroamércia: Reparto Montserrat. Casa # 2. Chinamdega, Nicaragua.
Tel: (+505) 8 882 1514
E-mail: centroamerica@seinmex.com www.seinmex.com
APRACOM. 27 E-mail: ventasacuicultura@apracom-ec.com www.apracom-ec.com
AQUACULTURE AMERICA 2023. 65 23 al 26 de Febrero, 2023.New Orleans Marriott. New Orleans, Louisiana. Tel: +1 760 751 5005 E-mail: worldaqua@was.org www.was.org
Aqua Expo Guayaquil 2022. 1 17 al 20 de octubre 2022 Centro de Convenciones. Guayaquil, Ecuador. Tel: (+593) 4 268 3017 ext. 202 E-mail: aquaexpoec@cna-ecuador.com
CONACUA 2022. ......................................................5 30 de Noviembre al 1 de Diciembre Tel: +668 030 484, 668 815 6227, 555 563 4600 www.conacua.com
LACQUA 2023. 71 18 al 21 de Abril, 2023. Hotel Riu Plaza. Tel: +1 760 751 5005 E-mail: worldaqua@aol.com www.was.org
WORLD AQUACULTURE SINGAPORE 2022. 17 29 de Noviembre al 2 de Diciembre, 2022. Singapore EXPO Convention & Exhibition Centre and MAX Atria Tel: +1 760 751 5005
E-mail: worldaqua@was.org www.was.org
COMEPESCA. 113
Contacto: Luis Fernández Tel: +52 (55) 3959 2572
E-mail: lfernandez@comepesca.com
AQUA EXPO GUAYAQUIL 2022 Oct. 17-20, 2022
Guayaquil, Ecuador
Panorama Acuícola Magazine
Empresarios No. #135 Int. Piso 7 Oficina 723 Col. Puerta de Hierro, C.P.45116. Zapopan, Jal. México. Cruza con las calles Av. Paseo Royal Country y Blvrd. Puerta de Hierro Tels: +52 (33) 8000 0578
Contacto 1: Suscripciones E-mail: suscripciones@panoramaacuicola.com Tel: +52 (33) 8000 0629 y (33) 8000 0653
Contacto 2: Juan Carlos Elizalde, ventas y mercadotecnia
E-mail: crm@dpinternationalinc.com www.panoramaacuicola.com
Design Publications International Inc. 203 S. St. Mary’s St. Ste. 160 San Antonio, TX 78205, EE.UU.
Oficina en EE.UU: +(210) 229 9036 Oficina en EE.UU, Directo: +(210) 504 3642 Oficina en México: (+52) (33) 3632 2355
Suscripciones: iwantasubscription@dpinternationalinc.com
Publicidad: crm@dpinternationalinc.com / sse@dpinternationalinc.com www.aquaculturemag.com
GEOFOREST ECUADOR. Fotogrametría y Drones. SEGUNDA DE FORROS
Contacto: Luis Fernández Tel: 099 948 5502, 098 896 2509
PLÁSTICOS RIVAL. 41
Oficinas corporativas: Catalina Aldaz y Portugal, Edificio Bristol Parc, Piso 6, Oficina 602. Quito, Ecuador.
Asesor comercial online: (+593) 99 861 6897 www.tienda.plasticosrival.com
REEF Industries. 119 9209 Almeda Genoa Road Z.C. 7075, Houston, Texas, EEUU.
Contacto: Gina Quevedo/Mark Young/ Jeff Garza. Tel.: Gratis 1 (800) 231-6074 Tel.: Local (713) 507-4250 E-mail: gquevedo@reefindustries.com jgarza@reefindustries.com myoung@reefindustries.com www.reefindustries.com
T: (+593) 4 268 3017 ext. 202
E: aquaexpoec@cna-ecuador.com W: https://aquaexpo.com.ec
FERIA MUNDIAL DE LA ACUICULTURA DEL CAMARÓN Y NACIONALES (FENACAM) Nov. 15 -18, 2022
Natal, Brasil
T: (+55) 84 3231.6291
E: fenacam@fenacam.com.br W: www.fenacam.com.br/
XVIII CONGRESO NACIONAL DE ACUICULTURA (CNA) DE ESPAÑA Nov. 21-24, 2022 Cádiz, España T: (+34) 956 290 939 E: cnacadiz@viajeseci.es W: www.seacongresos.org
XIV SIMPOSIO INTERNACIONAL DE GENÉTICA EN ACUICULTURA (ISGA) 2022
Nov. 27 – Dic. 2, 2022
Puerto Varas, Chile W: Isga.uchile.cl
WORLD AQUACULTURE SINGAPORE 2022 Nov. 29 - Dic. 2, 2022
Singapore.
T: (+1) 760.751.5005 FAX (+1) 760.751.5003 E: worldaqua@was.org W: www.was.org
CONGRESO DE ACUACULTURA DE CAMARÓN CONACUA 2022 Nov. 30 - Dic. 1, 2022
Los Monchis, Sinaloa, México. T: 668 103 0484 – 668 815 6227 – 555 563 4600
E: organizacionconacua@gmail.com W: www.conacua.com
AQUACULTURE AMERICA 2023
Feb. 23-26, 2023
New Orleans, EE.UU.
T: (+1) 760.751.5005 FAX (+1) 760.751.5003 E: worldaqua@was.org W: www.was.org
LATIN AMERICAN & CARIBBEAN
AQUACULTURE 2023 (LAQUA 2023)
Abril 18-21, 2023
Ciudad de Panamá, Panamá
T: (+1) 760.751.5005 FAX (+1) 760.751.5003 E: worldaqua@was.org y carolina@was.org W: www.was.org
Entre la “Acuicultura de la Realidad” y la “Acuicultura de las Expectativas” se pueden crear una variedad de escenarios, que en un mercado de inversionistas que desconocen la acuicultura, pueden caber las ideas más delirantes, y aún creerlas.
 Por: Artemia Salinas
Por: Artemia Salinas
Hace apenas unos cuantos años, 6 o 7 años para ser más exactos, con el boom mundial de las “Startups” y las empresas “Fintech”, llegaron a la acuicultura una serie de Fondos de Inversión buscando oportunidades para integrar un portafolio de promesas y expectativas que vender en los mercados financieros mundiales.
“Startups” y empresas “Fintech”, son, entre otras cosas, esas empresas que una entre millones consigue despegar de manera acelerada y vertiginosa, aumentando su capital a partir de inversiones basadas principalmente en las “expectativas” que podrían en un momento dado generar dividendos, siempre y cuando se logren todas las premisas prometidas en la promoción y venta de sus acciones.
Así fue como nació la “Acuicultura de las Expectativas”, un mundo nuevo de oportunidades para inversionistas, fondos de inversión, agentes financieros y fundaciones, entre otros, que vieron un panorama abierto, sin competencia y que con un discurso irrefutable cargado de sostenibilidad y buenas intenciones para salvar al planeta de la devastación de océanos y mares, salieron a vender las expectativas que la acuicultura promete en relación con: seguridad alimentaria, generación de empleos, contribución a la
sostenibilidad de mares y océanos, alimentos de alto nivel proteico y bajos en grasas, menor conversión alimenticia, mayor producción por unidad de área y cuantiosos dividendos al ser empresas nuevas en una industria nueva y que, por lo tanto, promete un crecimiento acelerado con base en nuevos productos en un nuevo y demandante mercado.
Todo va muy bien, hasta que llegamos a la “Acuicultura de la Realidad”, entendiendo por realidad, la “existencia verdadera y efectiva de algo o alguien”. Entre la “Acuicultura de la Realidad” y la “Acuicultura de las Expectativas” se puede crear una variedad de escenarios, que en un mercado de inversionistas que desconocen la acuicultura, pueden caber las ideas más delirantes posibles, y aún creerlas.
Una idea delirante puede tardar años de inversiones para deshacerse en falsas expectativas. Y estos fracasos, pueden terminar disuadiendo la inversión y el crecimiento de la acuicultura.
Proyectos que presentan un prototipo funcional, pero que después resultan ser inviables técnica o financieramente escalables, ideas lógicas pero que enfrentan regulaciones gubernamentales complejas, o mercados sobreestimados que no reaccionan con la prontitud necesaria para la sobrevivencia del pro-
yecto, son parte de las historias en donde no se cumplieron las expectativas que los inversionistas compraron por adelantado, esperando obtener crecientes réditos que al final terminaron esfumándose.
Es incuestionable que la acuicultura está evolucionando tecnológicamente a pasos agigantados, pero también es cierto que esta industria es aún liderada por una generación de pioneros que presentan resistencia y paradigmas a estos cambios tecnológicos. En esta encrucijada, es difícil para los potenciales inversionistas comprender si las nuevas tecnologías no son acogidas por los veteranos acuicultores por ser delirantes y especulativas, o si son rechazadas por su necedad y resistencia al cambio.
Si usted lector, es un inversionista interesado en subirse a la ola de la acuicultura para obtener ganancias rápidas de este crecimiento, ¡bienvenido! Hay delante de usted muchas oportunidades donde puede invertir de manera segura y obtener rendimientos superiores a los que va a encontrar en otros mercados financieros, pero asegúrese de tener un buen asesor quien lo prevenga de la venta de expectativas delirantes, las cuales por más serias y atractivas que le parezcan, lo van a llevar a un laberinto de pérdidas incalculables.
